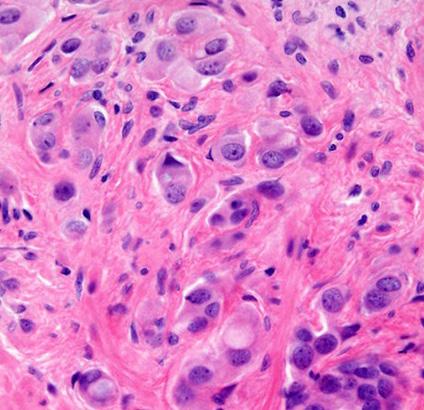

By Joe Taglieri joet@beaconmedianews.com

TheChuckwalla National Monument in Riverside and Imperial counties, along with another newly designated monument in Northern California, may lose federal protections following reports over the weekend that President Donald Trump plans to rescind the monuments established by President Joe Biden.
Just before leaving office in January, Biden declared the Chuckwalla National Monument that protected 624,270 acres of desert habitat from development.
Biden also established the 224,676-acre Sáttítla Highlands National Monument in the Cascade Mountains' Medicine Lake Highlands in Siskiyou County.
The New York Times and Washington Post reported Trump's intention to rescind the monuments Saturday, after the White House published a document late Friday that listed many executive orders canceling Biden administration actions, including one "terminating proclamations declaring a million acres of new national monuments that lock up vast amounts of land that lock up economic development and energy production."
That entry was later removed, however, without clarification from the White House.
The U.S. Department of Interior and White House did not respond to requests for comment.
Coachella Valley officials and community members who advocated for the Chuckwalla National Monument vowed to fight attempts to rescind federal protections.
"I hope the Trump administration doesn't alter Chuckwalla National Monument," Assemblyman Greg Wallis, R-Bermuda Dunes, told City News Service. "Chuckwalla is extremely popular across the political spectrum and was advocated for by a large, bipartisan coalition. Our local communities know that safeguarding our desert is good for the economy and is smart for the well-being of generations to come."
Palm Desert City Councilman Evan Turbee told CNS his business Big Wheel
Tours, which provides off-roading excursions in Chuckwalla, is dependent on the protected wilderness area.
"Hundreds of business owners like myself advocated for Chuckwalla National Monument to be protected and removing those protections would be deeply, deeply unpopular," Turbee said. "There is nothing partisan about it — it's something our community really fought for."
Janessa Goldbeck, a U.S. Marine Corps veteran and CEO of Vet Voice Foundation, said, "Chuckwalla National Monument isn't just a stretch of land — it's
See Chuckwalla Page 35
BCritics blast Trump order as free speech threat, but others say it's needed
By City News Service
y March 31, federal agencies that answer to the White House are required to identify policies available "for fighting antisemitism," mainly at colleges that have hosted pro-Palestine protests, prompting several Inland Empire residents to express fear of a "chilling" effect on free speech, while others support the action.
"This is about silencing criticism of Israeli genocide in Gaza," UC Riverside graduate Shaheen Nassar, whose family immigrated from the Palestinian territories, told City News Service. "Cheerleaders of the genocide do everything in the way of intimidation against people daring to speak out against it."
President Donald Trump's executive order to "Combat Antisemitism," issued Jan. 30, gave agencies 60 days to submit details on legal resources and options to "punish
See Trump order Page 36
Former DHS city councilman gets 12 months' probation for road rage
By City News Service
Aformer Desert Hot Springs city councilman who damaged a young man's car in a fit of rage following a roadway encounter was sentenced Friday to 12 months' probation and ordered to pay the victim $3,400 in restitution.

Russell Trueman Betts, 66, pleaded guilty last week to an unlawful fight in public, a misdemeanor, under an agreement with the Riverside County District Attorney's Office. In exchange for his admission, prosecutors dropped two related charges against Betts.
During a hearing at the Riverside Hall of Justice Friday, Superior Court Judge Gail O'Rane certified the terms of the
See Councilman Page 18






San Bernardino will receive nearly $2.95 million from Caltrans to construct raised street medians on E Street, city officials announced last week.
The project is for a 3.5-mile stretch between Fairway Drive and 10th Street.
The grant funding to the city in partnership with Omnitrans, the county's public transportation agency, is part of the state’s Local Highway Safety Improvement Program, or HSIP.


“This median project will directly improve vehicle, bus, and pedestrian safety along E Street in San Bernardino,” Mayor Helen Tran, an Omnitrans board member, said in a statement.
According to state accident data, the E Street corridor is high-risk for traffic mishaps.
The Federal Highway Administration recommends installing a raised median as an effective way of reducing vehicle crashes by about 25% and reducing pedestrian-related
By Staff
collisions by 36%. Raised medians physically separate opposing directions of traffic and restrict dangerous turns, both of which are common on E Street, officials said.
A similar project in 2019 along Hospitality Lane, between E Street and Waterman Avenue, provides a preview of the potential safety benefits for the proposed improvements on E Street, according to the city.
In the four years before the raised median on Hospitality Lane was installed, 42 collisions occurred with 21 resulting in injuries. In the first four years after the median’s installation, the number of collisions dropped to 23 with 12 causing injuries.
“The Hospitality Lane project clearly showed that adding a raised median to a high traffic corridor reduced the number of accidents,” Deputy Public Works Director and City Engineer Azzam Jabsheh said in a statement.
Officials expect the

HSIP grant to cover about 90% of the $3.2 million cost to install the new medians, with the remaining $250,000 coming from voter-approved Measure I.
A timeline for the E Street safety improvement project has not been finalized, officials said. Prior to the start of construction, the city will seek input from local businesses, approve a final design, then solicit bids from builders and ulti-
mately choose a contractor. HSIP is a core federalaid program with the purpose of achieving a significant reduction in traffic deaths and serious injuries on the nation's public roads. The current round of funding was approved via the Infrastructure Investment and Jobs Act of 2021. California’s share of HSIP money is divided between state highways and local streets.
By City News Service

Jack Draper of Great Britain beat Holger Rune of Denmark in straight sets Sunday to capture the BNP Paribas Open, while teenager Mirra Andreeva upset top-seeded and topranked Aryna Sabalenka in the women's final.


Draper, seeded 12th, dispatched the 13th-seeded Rune, 6-2, 6-2.
The 23-year-old Draper upset second-seeded Carlos Alcaraz of Spain in Saturday's semifinals, 6-1, 0-6, 6-4, while Rune scored his own upset, knocking off fifth-seeded Daniil Medvedev of Russia, 7-5,
Draper entered the tournament as the 14th-ranked player on the ATP Tour, but his success at Indian Wells means he'll crack the top 10 on Monday.
Rune was ranked No. 13. Sabalenka, 26, had yet to lose a set in the tournament entering Sunday's final. The Belarusian star also lost the 2023 final at Indian Wells to Elena Rybakina of Kazakhstan.
Theninth-seeded Andreeva, who will turn 18 on April 29, was ranked No. 11 in the world entering the tournament, a ranking that

will rise thanks to her 2-6, 6-4, 6-3 victory.
"I tried to run like a rabbit today," Andreeva said at the podium after receiving her trophy. "Because Aryna was sending bullets. It was hard just to keep up."
For her part, Sabalenka said she had a "a love-hate relationship with this place," referring to her other finals loss. "Mirra, congrats on an incredible run — great tournament, and great tennis," she added.
Summer's sunny embrace is more than just a promise of hotter days and ice cream feasts. For families, it's a golden opportunity to fortify bonds, create memories, and cultivate both joy and growth. The allure of family activities in the summer extends beyond mere enjoyment, offering a wealth of benefits that ripple through family dynamics and individual well-being.
The cornerstone of these activities is the strengthening of familial ties. Whether it's orchestrating game nights in the living room or embarking on adventurous vacations, these shared moments foster open communication and collective problem-solving. “Spending quality time together builds trust and mutual understanding, creating memories that last a lifetime,” family therapist Dr. Eleanor Moore remarks.
Physical health reaps dividends from the season’s outdoor-centric lifestyle. With sunshine as the backdrop, families delve into activities like swimming, hiking, and biking. These pursuits not only champion fitness but also reduce the sedentary lure of screens, enhancing overall health, according to Dr. John Peters from the North American Journal of Sports Science. Social skills, particularly in children, get a gentle polish during group activities. Be it a friendly game of football or collaborating on a summer camp project, children learn valuable lessons in teamwork and effective communication. Educational psychologist Dr. Linda Ray notes, “These interactions teach children the importance

of cooperation and the art of conflict resolution.”
Mentally, the benefits of a sunlit summer are profound. Nature acts as a balm, soothing stresses and sharpening the mind’s focus. Engaging in nature-based activities like hiking or leisurely picnics has been shown to reduce anxiety levels significantly, according to a study from the Journal of Environmental Psychology. Summer also emerges as a vibrant canvas for creativity and learning. Visits to cultural landmarks or museums transform learning into an interactive experience, while arts and crafts ignite imaginative sparks. According to cultural educator Marianne Lewis, “These activities blend fun with learning, enhancing children's problemsolving skills and artistic expression.” Ultimately, the summer season crafts stories that families will revisit with nostalgia. Whether camping in the backyard under starlit skies or exploring new destinations by road, these experiences become etched in the family’s folklore, bringing joy and connection as time unfolds.
Directory of Local Summer School Programs and Summer Camps: Alverno Heights Academy alvernoheightsacademy.org
Spartan Allstars Sports Day Camp spartanallstars.com
British Swim School britishswimschool.com
City of Burbank Summer Camps burbankca.gov
Mayfield Senior School Summer Programs mayfieldsenior.org
Maranatha High School Summer Academy maranathahighschool.org
Child Educational Center’s Summer Exploration Camp ceconline.org
Chinese School of San Marino Summer Camp smusd.us
La Cañada Flintridge Country Club Summer Camp lcfcountryclub.com
La Salle College High School Summer Programs lschs.org
Hogg's Hollow Summer Camp hoggshollowschool.com
Pasadena Christian School Summer Programs pasadenachristian.org
Pasadena Humane Summer Camp pasadenahumane.org
Pasadena Unified School District Summer Programs pusd.us
Mayfield Junior School Summer Program mayfieldjs.org
Parker-Anderson Enrichment Adventure Summer Camps parker-anderson.org
Rise Up and Dance Summer Camp riseupanddance.com
San Marino Community Church Nursery School smccnurseryschool.com
San Marino Community Church sanmarinocommunitychurch.com
San Marino Summer Academy smsummer.us
The Learning Castle and La Cañada Preparatory’s Summer School thelearningcastle.com
Ramona Convent Secondary School Summer Programs ramonaconvent.org
As the summer months approach, many parents find themselves in search of the perfect summer camp for their children. However, for families that prioritize diversity and inclusivity, the decision requires careful consideration. Summer camps provide children with invaluable opportunities for personal growth, learning, and social interaction, making inclusivity a priority is paramount. Leading the charge in this space are camps with missions steeped in diversity, equity, and inclusion. A good starting point for parents is to delve deeply into a camp’s mission statement, accessible via their website or brochures, to ascertain their commitment to creating a welcoming environment for all. Researching the camp’s mission and values helps identify whether they place emphasis on inclusivity. It’s equally important for parents to inquire about the demographics of both campers and staff members. Camps striving to recruit counselors from diverse cultural and ethnic backgrounds manifest a commitment to providing a richer, more inclusive environment. These camps often feature programs that celebrate multiculturalism, such as language immersion activities and cultural celebrations, which serve to broaden children’s perspectives and foster respect for different traditions.
Camps known for their inclusive policies, including accommodations for children with disabilities and LGBTQ+ inclusivity, often assure a safe and supportive environment. How a camp addresses

conflicts related to diversity is also a pivotal inquiry.
Inclusion doesn't stop with policy and diversity; ensuring that staff members undergo training on cultural competence, anti-bias education, and inclusion strategies is critical. "A camp prepared to provide such training illustrates a commitment to nurturing a supportive atmosphere for all children," shared a parent whose child has experienced such a camp.
Location and accessibility also play roles in selecting the right camp. Camps situated in diverse communities or those offering scholarship and transportation assistance tend to provide more inclusive experiences.
For parents, connecting with other families and reading reviews can offer insights into the camp’s diversity efforts and overall environment. Finally, understanding the leadership team's diversity can highlight their dedication to creating an inclusive space. Ultimately, a well-chosen summer camp can offer children an experience rich in cultural appreciation and personal development.
Directory of Local Summer School Programs and Summer Camps:
The City of Arcadia www.arcadia.gov/reg
Lavner Education Summer Tech Camp lavnercampsandprograms.com
San Gabriel Christian Summer Program sangabrielchristian.org
Camp Adventurewood campadventurewood.com
Encore Music and Performing Arts encoremusicsouthpasadena.com
Art / Work / Place myartworkplace.com
Tiffany Music Academy tiffanymusicacademy.com
Childtime of Alhambra childtime.com
Kids Klub San Gabriel/Rosemead kidsklubcdc.com
Spark Academy sparkacademycorp.com
Global Art Academy
A Child’s Garden School achildsgardenschool.org
Magikid Robotics Lab magikidlab.com
Asian Arts Talent foundation aatf.us
A+ Learning Center a-pluslearningcenter.com
Galileo Camps galileo-camps.com
California School of the Arts sgv.csarts.net
San Gabriel Mission High sgmhs.org
Steve and Kate’s Camp steveandkatescamp.com
Pasadena Ice Skating Camp pasadenaskatecamp.com
Flintridge Secret Heart Academy fsha.org
Caltech Center for Diversity caltech.edu
By Staff
Anew UCLA study has found that artificial intelligence could help doctors identify prostate cancer patients most likely to benefit from targeted treatment that removes cancer while sparing healthy tissue, according to a UCLA-led study published Tuesday.
Researchers evaluated the new Unfold AI software that uses data from MRIs and biopsies to generate a detailed 3D map of prostate tumors. The study found that the AI technology's measurements of tumor size — compared with relying solely on tumor grade or prostate-specific antigen levels — significantly improved doctors' predictions of successful treatment.
"By using AI to measure the size of a man's prostate tumor more precisely, we can better predict who is likely to be cured with focal therapies like partial gland cryoablation," Dr. Wayne Brisbane, assistant professor of urology at UCLA's David Geffen School of Medicine,
said in a statement.
The study tested whether Unfold AI's tumorvolume mapping would aid doctors in predicting a patient's likelihood for successful outcomes from a treatment called "partial gland cryoablation," a minimally invasive procedure that freezes and eradicates only cancerous areas of the prostate instead of removing or irradiating the entire gland. The treatment minimizes damage to vital areas, which reduces side effects in an effort to maintain patients' quality of life, researchers found. Current methods of predicting treatment success — tumor grade and PSA levels — often underestimate tumor size can miss smaller cancerous areas, often leading to incomplete treatment and cancer recurrence.
"The study marks an important advance in integrating AI into prostate cancer treatment decisionmaking, offering the potential for more personalized prostate cancer care,"
By City News Service

TBrisbane said.
Although the findings are promising, researchers emphasized the need for broader trials to validate the results.
“Such a method has not been previously available," Dr. Leonard Marks, professor and deKernion Endowed Chair in Urology UCLA's medical school, said in a statement. "It's important because tumor volume is a major determinant of treatment success or failure."
Marks, who is also a member of the UCLA Health Jonsson Comprehensive Cancer Center and senior author of the study, added, "Using AI to predict tumor volume and shape gives a clearer picture and could help choose better candidates for focal cryotherapy.”
Unfold AI was developed by researchers at UCLA and Avenda Health.
The study was published in BJUI Compass, a peerreviewed medical journal specializing in urology, and is available online at pmc. ncbi.nlm.nih.gov/articles/ PMC11771490.
he UCLA and USC women's basketball teams were headed to the NCAA Tournament on Monday as No. 1 seeds.
UCLA is the top seed in the tournament for the first time in school history. The Bruins won the Big Ten Tournament and will play the winner of the UC San Diego vs. Southern play-in game in the first round of the Regional 1 bracket in Los Angeles on Friday.
UCLA (30-2) has never won an NCAA national championship in women's basketball. The only two losses for the Bruins this season came
against crosstown rival USC. But UCLA beat USC in the championship game of the Big Ten Tournament.
UCLA's first round game is at Pauley Pavilion and will be televised on ESPN on Friday. The game is set to start at 7 p.m.
USC (28-3) is the No. 1 seed in Regional 4 and will play UNC Greensboro in the first round in Los Angeles on Saturday.
The Trojans have won two NCAA women's basketball championship in 1983 and 1984.
USC plays UNC Greensboro (25-6) at Galen Center in
Los Angeles. The game will be televised on ABC and is set to tip off at noon.
South Carolina, the reigning NCAA women's basketball national champion, is the No. 1 seed in Regional 3. South Carolina (30-3) plays Tennessee Tech (26-5) in the first round in Columbia, South Carolina on Friday. The game is set to start at 10 a.m. Texas (31-3) is the No. 1 seed in Regional 3 and plays the winner of the High Point vs. William & Mary play-in game. The first round game for Texas is Saturday and scheduled to start at 3:45 p.m. in Austin, Texas.
Eliminate gutter cleaning forever! LeafFilter, the most advanced debris-blocking gutter protection. Schedule a FREE LeafFilter estimate today. 20% off Entire Purchase. 10% Senior & Military Discounts. Call 1-855-424-7581 (Cal-SCAN)
DONATE YOUR VEHICLE to fund the SEARCH FOR MISSING CHILDREN. FAST FREE PICKUP. 24 hour response. Running or not. Maximum Tax Deduction and No Emission Test Required! Call 24/7: 1-877-434-6852 (Cal-SCAN)

GOT AN UNWANTED CAR??? DONATE IT TO PATRIOTIC HEARTS. Fast free pick up. All 50 States. Patriotic Hearts’ programs help veterans find work or start their own business. Call 24/7: 1-855408-6546 (Cal-SCAN)
Tiene un vehiculo no deseado? Donelo a Patriotic Hearts! Recogida rápida y gratuita en los 50 estados. Patriotic Hearts ofrece programas para ayudar a los veteranos a encontrar trabajo o iniciar su propio negocio. Llama ahora: 1-855-408-7368 (24/7) (Cal-SCAN)
Get a break on your taxes! Donate your car, truck, or SUV to assist the blind and visually impaired. Arrange a swift, no-cost vehicle pickup and secure a generous tax credit for 2025. Call Heritage for the Blind Today at 1-844-4912884 today! (Cal-SCAN)
Struggling with debt? If you have over $10,000 in debt we help you be debt free in as little as 24-48 months. Pay nothing to enroll. Call Now: 1-877-435-4860 (Cal-SCAN)
ERS! A cheaper alternative to high drugstore prices! 50 Pill SpecialOnly $99! 100% guaranteed. CALL NOW: 1-888-256-9155 (Cal-SCAN_
Jacuzzi Bath Remodel can install a new, custom bath or shower in as little as one day. For a limited time, waiving ALL installation costs! (Additional terms apply.) Subject to change and vary by dealer. (Offer ends 3/30/25.) Call 1-833-9854766
Safe Step. North America's #1 Walk-In Tub. Comprehensive lifetime warranty. Top-of-the-line installation and service. Now featuring our FREE shower package and $1600 Off for a limited time! Call today! Financing available. Call Safe Step 1-888-989-5749 (CalSCAN)
DENTAL INSURANCE from Physicians Mutual Insurance Company. Coverage for 400 plus procedures. Real dental insurance - NOT just a discount plan. Do not wait! Call now! Get your FREE Dental Information Kit with all the details! 1-844-203-2677 www.dental50plus.com/calnews #6258 (Cal-SCAN)
Consumer Cellular - the same reliable, nationwide coverage as the largest carriers. No long-term contract, no hidden fees and activation is free. All plans feature unlimited talk and text, starting at just $20/month. For more information, call 1-844-908-0605 (Cal-SCAN)

Attention: VIAGRA and CIALIS US-
The difference in winning and losing market share is how businesses use their advertising dollars. CNPA’s Advertising Services’ power to connect to nearly 13 million of the state’s readers who are an engaged audience, makes our services an indispensable marketing solution. For more info call Cecelia @ (916) 288-6011 or
cecelia@cnpa.com
DID YOU KNOW Newspaper-generated content is so valuable it’s taken and repeated, condensed, broadcast, tweeted, discussed, posted, copied, edited, and emailed countless times throughout the day by others? Discover the Power of Newspaper Advertising. For a free brochure call 916-288-6011 or email cecelia@ cnpa.com (Cal-SCAN)
If veterinary care is unavailable or unaffordable, ask for Happy Jack® ItchNoMore® or Skin Balm® to treat skin allergies on dogs & cats. At Tractor Supply®.
RETIRED COUPLE $$$$ for business purpose Real Estate loans. Credit unimportant. V.I.P. Trust Deed Company www.viploan.com Call 1-818-248-0000. Broker-principal DRE 01041073. No consumer loans. (Cal-SCAN)
BATH & SHOWER UPDATES in as little as ONE DAY! Affordable prices - No payments for 18 months! Lifetime warranty & professional installs. Senior & Military Discounts available. Call: 1-877-252-9868 (Cal-SCAN)
Don't Pay For Covered Home Repairs Again! Our home warranty covers ALL MAJOR SYSTEMS AND APPLIANCES. We stand by our service and if we can't fix it, we'll replace it! Pick the plan that fits your budget! Call:1-855411-1731 (Cal-SCAN)
WATER DAMAGE CLEANUP & RESTORATION: A small amount of water can lead to major damage in your home. Our trusted professionals do complete repairs to protect your family and your home's value! Call 24/7: 1-888-248-0815. Have zip code of service location ready when you call! (Cal-SCAN)
By Shawn Spencer shawn@girlfridaysolutions.net
Wine not spring is in the air! Shooby doobydooooo.
Today is officially the first day of spring, and it is one of my favorite seasons. I love walking through Old Town all year long, but the pink jasmine vine in front of Sena on Myrtle is in bloom and I cannot get enough of it. I’m not sure how long of a break we will have from the rain, but the weather is supposed to be glorious for the next week or two. Thank goodness, because there are some Old Town events coming up that you will not want to miss!
Back by popular demand, do not miss the eighth annual Old Town Monrovia Wine Walk. Sip, shop, and support our Old Town Merchants. Tickets are available on Eventbrite, but you can also purchase tickets at Charlie’s House and the Community Center. The Wine Walk is on Saturday, April 5 from 6-9 p.m.
Your ticket gets you a tasting glass, twelve tastings and a map of all the participating businesses. Grab a group of friends or make this a fun date night! Enjoy the wonderful weather as you stroll through Old Town, and visit participating businesses to sample delicious wines and food pairings. This is such a fantastic opportunity to get to know our local business owners and their staff. It is also a great opportunity to visit a business that is new

to you!
There will be live music, fun photo ops, delicious wines and appetizers. This event sells out every year, so get your tickets today! Don’t drink? Don’t care! There are non-alcoholic stops, as well, and it is still a lot of fun.
Looking for something eggstra special to do? Look no further — Spring Bunny Photos at Library Park are on April 12 from 10 a.m. to 1 p.m. In addition to a photo with the Easter Bunny, there will be arts and crafts, lawn games, story time and other photo opportunities. It’s sure to be a fun day for the entire family!
I don’t want to put a damper on all of this springtime fun, but I do want to share one more thing with
you. Please do not miss your last chance to become wildfire ready! This third and final event is virtual and takes place on Wednesday, March 26 from 5-7 p.m. The San Gabriel Valley Council of Governments is developing a regional wildfire plan and wants all SGV residents and business owners to share their priorities. You can register online at tinyurl. com/wildfire-planning.
Get outside and enjoy this lovely weather while you can! We certainly need the rain, but that doesn’t mean we can’t enjoy a little sunshine during this reprieve. Let’s not forget that we basically have only a few weeks of jeans weather before it becomes shorts weather.
The City of Arcadia offers a variety of summer camps for children ages 5-12 including Specialty Camps, Sports Camp, and Fun N Play. Camps are limited and fill up quickly, so be sure to register now!
• Specialty Camps feature a variety of week-long themed camps. Camps are STEM and sports-centric, boosting brain activity to its maximum potential over summer break.
• Sports Camp engages participants in athletic drills, sports theme activities, and weekly excursions.
• Fun n Play provides a variety of organized recreational games and activities including crafts, games, special events, and much more. For more information, please visit us at www.arcadiaca.gov/reg

Wile is a striking 2-year-old Belgian Malinois mix with a big personality and an independent spirit. Weighing in at 60 pounds, Wile is a strong and confident dog who knows what he wants. He’s intelligent and self-sufficient, making him a great match for someone who appreciates a dog that doesn’t constantly demand attention. If you’re looking for a loyal companion who enjoys having his own space while still being a dedicated best friend, Wile might just be the perfect fit. Wile is housetrained and has great manners indoors, making him an easy addition to a home that values structure and routine. He’s not one for rowdy dog parks or canine playdates—Wile prefers to be the only dog in the home, where he can truly relax and bond with his person. His independent nature means he enjoys exploring on walks and sniffing out interesting scents, but he also appreciates a cozy spot to unwind at the end of the day. This smart and capable pup would do best with an experienced dog owner who understands his working-dog mentality. Wile thrives with clear boundaries and a job to do, whether it’s daily walks, training sessions, or mentally stimulating activities. He would love a home where he can continue to learn and build trust with a patient and understanding human. While he may not be a social butterfly with other dogs, Wile is ready to be an incredibly devoted and loving companion to the right person. If you’re searching for a strong, independent dog with a big heart, Wile is waiting to meet you!
Mito is a 7-year-old pit bull mix who is a happy-go-lucky goofball who’s always ready for adventure. The moment he steps out of his kennel at Pasadena Humane, his whole body wiggles with excitement—sometimes a little too much, but that’s just part of his charm! Mito is a true people-lover who soaks up attention and affection like a sponge. Belly rubs? Yes, please! Head scratches? Even better! And if you have treats, you’ll have a best friend for life. He’s highly food-motivated and already knows “sit” (and will eagerly show off his skills in exchange for a snack). His enthusiasm sometimes leads to some extra paws-on greetings— whether it’s a table or a person, he just can’t contain his joy! Mito will thrive in an active home where he can burn off energy with daily exercise and continue working on his leash skills. He’s a strong boy who’s eager to learn, and with a little training (and a lot of treats), he’ll make a loyal, loving companion. If you’re looking for a fun-loving, affectionate pup who’s always ready to brighten your day, Mito might be your perfect match!
The adoption fee for dogs is $150. All dog adoptions include spay or neuter, microchip, and age-appropriate vaccines. Walk-in adoptions are available every day from 10:00 –5:00. View photos of adoptable pets at pasadenahumane.org. New adopters will receive a complimentary health-and-wellness exam from VCA Animal Hospitals, as well as a goody bag filled with information about how to care for your pet. Pets may not be available for adoption and cannot be held for potential adopters by phone calls or email.
March 6
At 6:54 p.m., officers were dispatched to a business in the 700 block of East Huntington regarding a theft. A female suspect stole merchandise and fled in a getaway vehicle driven by a male subject. Officers located the vehicle when it was fleeing the scene and conducted a traffic stop. The stolen property was recovered and both suspects were arrested for grand theft.
At 9:48 p.m., an officer stopped a bicyclist for a vehicle code violation at the intersection of Central and California. During the investigation, the suspect was found to be in possession of a controlled substance. The suspect was arrested and taken into custody.
At 9:44 p.m., officers responded to a business in the 900 block of South Fifth regarding a woman refusing to leave. She was not a guest and staff desired prosecution. Officers located the woman on the premises causing a disturbance. The subject was arrested and taken into custody.
At 11:26 p.m., an officer on patrol in the 300 block of
West Foothill contacted a pedestrian whom he recognized from prior contacts. A records check revealed she had five outstanding warrants. She was arrested and taken into custody.
March 7
At 1:39 a.m., an officer patrolling the 1600 block of South Primrose noticed a suspicious parked vehicle occupied by a male. After contacting the subject, a records check revealed he had an outstanding warrant out of Los Angeles. He was arrested and taken into custody.
At 1:30 p.m., a victim reported a fraud in the 800 block of Alta. He was notified that his tax refund had been stolen and sent to a college in Northern California. This investigation is continuing.
At 3:34 p.m., a resident reported vandalism in the 900 block of Oceanview. The resident stated someone damaged the complex's mailbox during the night. It is unknown at this time if mail was stolen. This investigation is continuing.
At 4:31 p.m., officers responded to a call in the 500 block of West Huntington

regarding a theft. A suspect stole approximately $800 worth of cosmetics from the business and fled. Officers checked the area but did not locate the suspect. This investigation is continuing.
At 6:48 p.m., officers responded to the 700 block of East Huntington regarding a missing 74-year-old woman. The reporting party stated her grandmother was last seen two hours prior. Officers conducted an extensive search, checking nearby businesses, parking lots, and parks. A critical missing broadcast was issued and Arcadia Police assisted during the search. Officers received information that the grandmother had walked home, her safety was confirmed.
At 8:36 p.m., officers responded to a business in the 700 block of East Huntington regarding a female suspect concealing merchandise in a bag. When the suspect exited the store with stolen merchandise, officers contacted her. After an investigation, the suspect was arrested for shoplifting.
March 8
At 12:18 a.m., officers responded to an apartment complex in the 1600 block of South Magnolia regarding a male subject roaming the parking structure and bike storage area. Officers located the subject charging his phone. A records check revealed he had a warrant out of Los Angeles for a violation of a court order. He was arrested.
At 3:38 a.m., West Covina police officers had contact with a subject in their city and discovered he had a warrant out of Monrovia for felony domestic violence, robbery, criminal threats, and vandalism. A Monrovia police officer responded to the West Covina Police Department and took custody of the subject and transported him to MPD to continue the investigation.
At 6:36 a.m., officers responded to a traffic collision in the area of Foothill and Violet. A driver traveling at an unsafe speed, rear ended two vehicles who were
stopped at the intersection. One party complained of neck pain.
At 8:46 a.m., officers responded to a call in the 400 block of Genoa regarding a possible burglary. Officers arrived and learned that the front door of the home had been kicked in. There was nobody inside and nothing was stolen from the home, since the residents were in the process of moving out. This investigation is continuing.
At 9:01 a.m., an employee in the 700 block of East Huntington called to report a burglary. Someone had broken into the business by shattering the drivethru window. The suspect attempted to steal the cash register but learned it was empty and left it behind. Nothing was determined to be taken at this time. This investigation is continuing.
At 1:16 pm, in the 700 block of East Huntington, a caller reported that his friend was possibly overdosing on an opiate and they were driving in the area. Officers and MFD were dispatched to the area. The vehicle continued driving into the City of Duarte before it stopped in front of 1134 Huntington, Duarte. Officers located the vehicle and issued two doses of Narcan on the subject, after confirming he was in medical distress, reviving him. He was transported to the hospital.
At 3:50 p.m., officers responded to a traffic collision in the area of Foothill and Grand. A vehicle made a left turn in front of another and caused a collision. No one was injured but one of the parties did not have insurance. Fraud March 8 a
At 5:58 p.m., a victim residing in the 300 block of Genoa reported fraudulent activity on her bank account. She stated her house had burned down in the Altadena fires and after relocating to Monrovia, she realized her wallet containing multiple banking cards had been left behind at the Altadena residence. She recently discovered approximately $12,000 in unauthorized charges at various locations across
Southern California. The investigation is continuing.
At 6:11 p.m., officers responded to a business in the 500 block of West Huntington regarding a disturbance. Loss prevention recognized a male subject inside the store as a previous shoplifter and instructed him to leave. When the subject exited the store, he turned and spit in the loss prevention officer’s face before fleeing. Officers searched the area but were unable to locate the suspect. The investigation is continuing.
At 8:16 p.m., officers responded to multiple 911 calls regarding a male subject sitting in the middle of the roadway at the intersection of Myrtle and Foothill. Officers arrived, blocked traffic for safety, and contacted the subject. After an investigation, it was determined the subject was a danger to himself. He was placed on a mental evaluation hold and transported to a local mental health facility for treatment.
March 9
At approximately 7:50 a.m., an officer conducted a records check on a vehicle parked at The Shops at Santa Anita, located at 400 S. Baldwin Ave., and discovered it had been reported stolen. The officer initiated a traffic stop and contacted the driver. During a search of the vehicle, the officer discovered the driver, a 42-year-old male from Los Angeles, was in possession of a stolen firearm, had a second firearm concealed in the vehicle, unlawfully possessed an illegal firearm magazine, and had two outstanding misdemeanor warrants. The suspect was arrested and transported to the Arcadia City Jail for booking.
March 10
At approximately 3:34 p.m., an officer responded to a residence in the 900 block of Hampton Road regarding a burglary investigation. The victim stated his alarm was activated when two suspects smashed the rear glass door.
The suspects fled in a black sedan. The loss is unknown.
March 11
At approximately 6:26 p.m., officers responded to the 00 block of Woodland Lane regarding shots being fired and an injured subject. The lone male victim later succumbed to his injuries. The investigation is ongoing and is being handled by Los Angeles County Sheriff’s Department’s Homicide Bureau.
March 12
At approximately 5 a.m., an officer responded to Golden Vision, located at 655 W. Duarte Road, regarding an alarm activation. The officer discovered unknown suspects used a vehicle to damage the metal roll up window and steal glasses from the business.
March 13
At approximately 8:43 a.m., an officer responded to The Shops at Santa Anita, located at 400 S. Baldwin Ave., regarding a vehicle burglary report. The victim’s Tesla recorded the suspect exiting her car after he stole cash, gift cards, credit cards, and other items. He then used the stolen credit cards at Nordstrom. The suspect is described as a White or Hispanic male driving a white Mini Cooper.
March 14
At approximately 8:52 a.m., an officer responded to Arcadia Surgical Group, located at 80 W. Live Oak Ave., regarding a grand theft incident. Sometime during the previous night, someone accessed the roof of the business and stole copper from the air conditioning units.
March 15
At approximately 9:35 a.m., an officer responded to a residence in the 800 block of Victoria Drive regarding a burglary investigation. The victim discovered someone smashed a rear bedroom glass door and ransacked the room. The loss is unknown. The crime happened sometime during the previous night.
Monrovia
Monrovia Wine Walk slated for April 5
The Monrovia Old Town Advisory Board and the merchant community will host this year's Wine Walk in Old Town Monrovia on Saturday, April 5, from 6 to 9 p.m. Wine Walk guests will receive a tasting glass, a map of the participating businesses in Old Town, 12 wine tastings, access to the photo booth and appetizers. Pre-sale tickets are available for purchase at the Monrovia Community Center, Charlie's House, or online at eventbrite.com for $50. A limited number of tickets will be sold on the day of the event for $60.
Arcadia
Join City of Arcadia for a hike at Weir Canyon Trail
Join the City of Arcadia for a hike at Weir Canyon Trail in Anaheim, on Saturday, April 19, 2025. This hike is a fourmile moderate route, and the cost is $26 per person, for ages 8 years and older. The event includes a light lunch, transportation from the Arcadia Community Center to the Weir Canyon Trail and back. Participants will meet at 7:30 a.m. at the Arcadia Community Center located at 365 Campus Drive, Arcadia. To register, visit the city’s website at www.ArcadiaCA.gov or you may register in person at the Arcadia Recreation and Community Services
Department Office located at 375 Campus Drive. For more information, call the Arcadia Recreation Office at 626-5745113.
Glendale
Author Talk with Nancy Kricorian to be held at Glendale Central Library
Join Glendale Library, Arts & Culture and Nancy Kricorian in conversation with Shahé Mankerian to discuss her latest book “The Burning Heart of the World” on Wednesday, April 2, from 7 to 8 p.m. in Central Library’s Auditorium. In vivid, poetic prose, Kricorian’s "The Burning Heart of the World" tells the story of a Beirut Armenian family before, during, and after the Lebanese Civil War. Returning to the fabular tone of "Zabelle," her popular first novel, Kricorian conjures up the lost worlds and intergenerational traumas that haunt a family in permanent exile. Leavened with humor and imbued with the timelessness of a folktale, "The Burning Heart of the World" is a sweeping saga that takes readers on an epic journey from the mountains of Cilicia to contemporary New York City.
Azusa
Azusa accepting scholarship applications
The City of Azusa is accepting applications for the Academic Scholarship Program through Monday, April 14. This scholarship opportunity is open to graduating high school seniors
and adult advancement learners in Azusa pursuing higher education at an accredited community college, trade school, or university. Up to four scholarships are available, with awards of up to $2,000. For eligibility details and application information, visit www.azusaca.gov/scholarships. For any questions, reach out to neighborhoodservices@azusaca.gov or call (626) 633-4314.
OC man who threw injured cat in dumpster charged with animal cruelty
Joseph Harrison Parker of Mission Viejo has been charged with felony animal cruelty after he was captured on surveillance video throwing an obviously injured cat inside a trash bag into a dumpster. The cat was suffering from a broken jaw, broken blood vessels in her eye, a concussion, and a badly swollen eye when she was rescued just before the dumpster was scheduled to be emptied. Parker, 58, pleaded not guilty on Friday to one felony count of animal cruelty and one misdemeanor count of abandoning a domestic dog or cat. Prosecutors successfully objected to a request by the Public Defender’s Office to have Parker released on his own recognizance. Despite objections from prosecutors, Orange County Superior Court Commissioner Sheri Sandecki reduced Parker’s bail from the statutory $20,000 to $2,000. Parker posted bail over
the weekend and was released.
Riverside Heritage House exhibition highlights Victorian love, courtship
A new exhibition at the Museum of Riverside’s Heritage House, "First Comes Love: Courtship in the Victorian Era," highlights objects and images from the Museum’s collections that shed light on a shift in the institution of marriage during the Victorian era (1837-1901), the period during which Heritage House was built. The exhibition focuses on a cultural transformation that ushered in new expectations and opportunities for individuals, especially women, in their pursuit of love and partnership. "First Comes Love: Courtship in the Victorian Era" will be on view at Heritage House, 8193 Magnolia Ave., through June 29.Special programs will be advertised throughout the spring season. Experience the exhibition during your free tour of Heritage House. It’s recommended to book your tour in advance via Eventbrite: https://www. eventbrite.com/e/toursof-heritage-house-tickets976415213187?aff=oddtdtcr eator.
7 pets dead; 2 people, additional animals evacuated from fire
Investigations continued Friday in Palm Springs after seven dogs died in a residential structural fire that required two people to be evacuated. The Palm Springs Police Department was notified of a blaze in the 2400 block of Starr Road at approximately 12:45 p.m. Thursday, according to the department. Officers were called upon to assist Palm Springs Fire Department personnel at the location. When officers arrived, a detached garage and vehicle parked within were "fully engulfed in flames," police said. The officers ensured that a 12-year-old girl and 21-year-old man evacuated the residence safely. After firefighters extinguished the blaze, officers began a property search, finding that seven dogs had died in the fire. Seven additional dogs and four cats were found inside of the residence and taken into protective custody. The cause of the fire was under investigation. Animal Control authorities launched a separate investigation for possible animal cruelty, police said.
San Bernardino County IHSS offers free caregiver training
San Bernardino County In-Home Supportive Services is hosting an IHSS Caregiver Spring Training Summit to support and inspire San Bernardino County IHSS providers. The summit will be held on April 9 at the
By City News Service
UCLA received the seventh seed in the Midwest Region in the NCAA men's basketball tournament Sunday and will face 10th-seeded Utah State in a first-round game Thursday in Lexington, Kentucky.
"Because Jerrod and I are friends, on my nights sitting at home when they were on, I definitely watched them," Bruins coach Mick Cronin
said, referring to Aggies coach Jerrod Calhoun. "I watched them play against Richard Pitino (New Mexico). I saw them play Iowa.
"I'm well aware of their team. I root for the guys that I know well in the business.
Utah State was on an absolute roll at the start of the season. They beat Iowa. They have multiple wins. UCSD got them up there and
congratulations to those guys. I did scout the Iowa film in preparation for Iowa, so I watched them closely there. I've seen about five, six, seven times at least."'
Oddsmakers have made UCLA a 4 1/2-5 1/2-point favorite.
Since the tournament expanded to 64 teams in 1985, the seventh seeds have an 81-54 record against the 10th seeds in the first round,
with the 2021 West Region match-up between seventhseed Oregon and 10th-seed Virginia Commonwealth considered a no contest due to COVID-19 protocols with Virginia Commonwealth.
Connecticut in 2014 is the only seventh seed to win the NCAA tournament.
The Bruins (22-10) received their invitation after finishing in a three-way tie for fourth in the 18-team
Goldy S. Lewis Community Center, 11200 Baseline Road in Rancho Cucamonga. The training is free to registered San Bernardino County IHSS providers and offers two sessions: a morning session from 9 a.m. to noon and an afternoon session from 1 to 4 p.m. Space is limited. An online streaming option is available. For more information on the training summit, call 909-677-6076 or email ihsspatrainingunit@hss. sbcounty.gov.
Ontario Art Book Fair to be held March 29
The Department of Museum, Arts & Culture will once again host the Ontario Art Book Fair on Saturday, March 29, from 11 a.m. to 5 p.m. This free one-day event showcases regional artists' books, catalogues, monographs, periodicals, and zines. The museum will open its art galleries to fifty exhibitors including publishing houses, independent press collectives, artists, zine-makers, printmakers, and individuals practicing in experimental paper formats. The event highlights exhibitors from the West Coast with an emphasis on Californiabased artists and publishers. The event and programming activities are free for all ages. Original books, zines, and art prints will be available for purchase. Light refreshments will be available on site for purchase throughout the day. To learn more visit OntarioMuseum.org.
Big Ten Conference. UCLA will enter the NCAA tournament after Friday's 86-70 loss to Wisconsin in a quarterfinal game of the Big Ten Tournament.
The Bruins are returning to the NCAA tournament after a one-season absence. This is the fourth time in five seasons UCLA has advanced to the tournament.
Utah State (26-7) was third in the 11-team
Mountain West Conference. The Aggies lost to secondseeded Colorado State, 83-72, in a Mountain West Men's Basketball Championship semifinal Friday.
TNT will televise the 6:25 p.m. Pacific Daylight Time game.
The UCLA-Utah State winner will play the winner of Thursday's game between second-seeded Tennessee and 15th seeded Wofford.
By Steven Herbert, City News Service
MattRichtman became the first American to win the Los Angeles Marathon since 1994 Sunday, topping the second-largest field in race history in a course-record two hours, seven minutes, 56 seconds.
The 25-year-old Richtman, a cross-country All-American at Montana State who was raised in Illinois, took the lead midway through the 26-mile, 385- yard race. Athanas Kioko was second in 2:10:55 with fellow Kenyan Moses Kiptoo third in 2:13:13.
Richtman also won the Marathon Chase as the top overall finisher, receiving a $10,000 bonus in addition to the $10,000 he received as the men's winner. The elite women started 16 minutes, 5 seconds ahead of the elite men, a difference determined by projected winning times.
Richtman is the first man to win the chase since it was revived in 2022. The chase was part of the marathon from 2004 to 2014, with women winning seven times and men four. It was discontinued in 2015 when the race served as the USA Marathon Championships, then revived in 2022.
The previous course record was 2:09:08, set by Kenyan John Korir in 2022. The race has been held on the same course since 2021.
Tejinesh Gebisa Tulu of Ethiopia was the women's winner in 2:30:16, the 13th victory by an African woman in the last 16 LA Marathons. Kenyan Antonina Kwambai was second in 2:30:19. The last American woman to win was Olga Appell, also in 1994.
Savannah Berry of Bakersfield finished third among the women in 2:30:31.
"I'm beyond thrilled," Berry said. "It was fun racing against this group of girls, and then honestly seeing Matt by me ... I was like, `OK, yes, we got this. I wanted to represent for the state, and I wanted to represent for our country."

Richtman called the victory in his second marathon "definitely a surprise."
"I came in feeling really good," Richtman said moments after crossing the finish line. "It's really hard to judge where you stack up against competition, but it was a really good group out there today, and I was really happy to run with those guys and then ultimately win it,"
"I didn't have too much of a strategy," he continued.
"The first half I just wanted to stay in that group, didn't really want to push the pace or lead or anything like that, just kind of stay, feel it out, 'cause it's a challenging course. ... I told myself, `Once you get the hour mark then you can start to feel it out, do any moves if you want to do that, so that's what I did. ... The whole race I was running with a little bit of fear. It's tough when you can't see what's going on behind you."
Richtman said he drew inspiration from the atmosphere in Los Angeles.
"It's such a great day for it, you know, the 40th anniversary, there's so many legacy runners out here, and the crowd out here was amazing. There were people throughout the whole
course and it really helps. It's amazing how much a crowd can change the course of what you're doing."
Richtman was fourth in his marathon debut in the 2024 Twin Cities Marathon in 2:10:45 on Oct. 6 in a race won by Kenyan Shadrack Kimining in 2:10:17.
Richtman credited Sunday's victory to "good training and good support group around me."
Paul Pilkington was the last American to win the LA Marathon in 1994 in 2:12:13 on the race's original course which began and ended in Exposition Park. The men's race has been won by Kenyans 22 times since 1999, and Ethiopians four times.
The capacity field for the 40th Los Angeles Marathon numbered more than 26,000.
The men's and women's winners each received $10,000, the second-place finishers $5,000 and thirdplace finishers $3,500. The men's and women's wheelchair winners received $2,500.
Francisco Sanclemente of Colombia was Sunday's men's wheelchair winner in 1:38:10, his third consecutive LA Marathon triumph. Miguel Jimenez Vergara of Chula Vista was second in
1:43:32.
Wakako Tscuhida of Japan was the women's wheelchair winner in 2:03.56. The 50-year-old is a gold medal winner in track in the Summer Paralympics and two-time gold medal winner in ice sledge racing in the Winter Paralympics.
The wheelchair racers took off from Dodger Stadium promptly at 6:30 a.m., followed by the hand crank racers at 6:35 a.m. and the women's elite field at 6:44 a.m. The elite men's field hit the pavement at 7 a.m. Mayor Karen Bass was the honorary starter.
From Dodger Stadium, runners headed through Chinatown, downtown Los Angeles, Echo Park, Thai Town, Little Armenia, Hollywood, West Hollywood, Beverly Hills, Century City, Westwood and Brentwood then back through Westwood to Century City, with the finish line for the "Stadium to the Stars" course on Santa Monica Boulevard, just past Century Park East.
Several firefighters who fought January's devastating wildfires were among those participating in the 26-mile, 385-yard race.
U.S. Forest Service Capt. Jerry Garcia, who
and their families who lost homes or were displaced.
The Los Angeles Marathon, New York Road Runners, the nonprofit organization that produces the New York City Marathon, the Chicago Marathon, and the Boston Athletic Association, organizers of the Boston Marathon, came together to support Together LA, an initiative spearheaded by The McCourt Foundation, which owns and operates the Los Angeles Marathon, to aid those affected by the Los Angeles County wildfires.
helped battle the Eaton Fire, co-paced the group of runners seeking to complete the marathon in two hours, 55 minutes.
"I guarantee that 90% of the runners in the marathon probably know somebody who lost their home or was personally impacted," Garcia said in a statement. "When they asked me to pace, I knew it could be about helping runners and being part of an event that will be about the Los Angeles community. I'm grateful for the opportunity."
The 47-year-old Palmdale resident was the top runner in the 45-49 age group in the 2024 Los Angeles Marathon with a personal best time of 2:40:13. He won the 2017 Angeles Crest 100 trail running race.
Another firefighter in the field was Los Angeles Fire Department Firefighter Greg Balandran, who ran on behalf of the Widows, Orphans and Disabled Firefighters Fund, the official charity of the Los Angeles Firemen's Relief Association.
Shortly after the wildfires erupted, the fund began providing long- term support for the more than two dozen LAFD firefighters
The four organizations co-branded limited-edition Together LA merchandise, with all net proceeds benefiting Community Organized Relief Effort and the California Fire Foundation. These funds will provide emergency relief, assist displaced families and support long-term recovery efforts.
Only the 2020 field of 27,150 entrants had a larger field than Sunday's. Dan Cruz, the head of communications for The McCourt Foundation, told City News Service the capacity field could be attributed to the marathon's growing reputation, "its scenic and iconic course, strong community support and a robust charity partner program."
The field consisted of runners from all 50 states and more than 70 nations. It included 93 legacy runners who have run all 39 previous editions of the race while 40% are first-time marathoners. Cruz said the large number of first-time marathoners "could be due to the explosion in popularity of social run clubs throughout the region."
"We've also seen growth in the younger 20-29 year-old demographic and Students Run LA," the after-school mentoring and physical fitness program for at-risk middle and high school students, which "has returned to pre- pandemic numbers with 3,500 participants," Cruz said.

NOTICE IS HEREBY GIVEN that the City Council will hold a public hearing on the following project.
PROJECT LOCATION: The Ordinance would apply to the following areas shown on the map below and described as follows:
• Station Square Transit Village Area: Properties bounded by South Mayflower Avenue to the west, East and West Duarte Road to the south, Shamrock Avenue to the east, and East and West Evergreen Avenue to the north.
Project Location: Citywide
Contact Information: Development Services Department DSD@ArcadiaCA.gov (626) 574-5415
A. Categorical Exemption from CEQA Pursuant to Section 15061(b)(3) of the CEQA Guidelines as it can be seen with certainty that the Text Amendment will have no impact on the environment; and
B. Text Amendment No. TA 25-01 (Ordinance No. 2402 and Resolution No. 7621 pertaining to an Inclusionary Housing Ordinance)
Project Description: Text Amendment No. 25-01 to consider adding a new section 9103.16 to Article IX, Chapter 1 (Development Code) of the Arcadia Municipal Code pertaining to an Inclusionary Housing Ordinance and Resolution No. 7621 related to an associated In-Lieu Development Fee as an alternative to providing affordable units required by the Ordinance.
Applicant: City of Arcadia
Hearing Date and Time: Tuesday, April 1, 2025 at 7:00 p.m.
Place of Hearing: Arcadia City Council Chambers, 240 W. Huntington Drive, Arcadia, CA
很想知道这里讲的是什么吗?我们也希望你们了解这些信息。阿凯迪亚市向公众免费提供文件翻译服务。 请致电 (626) 574-5455,向市书记官办公室了解详情。
Published on March 20, 2025
ARCADIA WEEKLY

NOTICE IS HEREBY GIVEN that the City Council will hold a public hearing and consider the Planning Commission’s recommendation on the following Text Amendment.
• West Huntington Drive Corridor (Retail Corridor Mixed Use): Properties with the zoning designation of Retail Corridor Mixed (RCM). Generally enclosed by South 5th Avenue to the west, Encino Avenue to the east, and West Huntington Drive to the north.
• South Myrtle Avenue Corridor District Overlay (Old Town Extension District): Properties bounded by South Primrose Avenue to the west, East and West Maple Avenue to the south, South Ivy Avenue to the east, and East and West Olive Avenue to the north.
PROJECT DESCRIPTION: Ordinance to establish standards and procedures that require the development of affordable housing in conjunction with new housing developments of five or more units, to ensure the addition of affordable housing units is in proportion with the overall increase in new housing units, and to provide standards and procedures for the administration of the City's inclusionary housing program.
Pursuant to the California Environmental Quality Act (“CEQA”) and the City’s local CEQA Guidelines, City Staff determined that there is no possible significant effect directly related to the adoption of Ordinance No. 2025-03. This Ordinance implements Program 1.7 of the 6th Cycle Housing Element and is exempt from further environmental analysis pursuant to California Code of Regulations (CCR) Sections 15183(a), 15162(a), 15061(b)(3) and 15378(b)(4); therefore no further action is required under CEQA.
AVAILABILITY: The Staff Report pertaining to this item will be available on Thursday, April 3, 2025 after 4:00 p.m. on the City’s website at https://www.monroviaca.gov/your-government/boards-and-commissions/planning-commission/agendas-minutes.
Public comments regarding this item may be stated in person at the meeting, or submitted in writing. Written comments submitted by 5:00 p.m. on the meeting date will be distributed to the Planning Commissioners. The purpose of this public hearing is to afford the public an opportunity to be heard concerning the proposed Ordinance. If you challenge the ordinance in court, you may be limited to raising only those issues you or someone else raised at the public hearing described in this notice, or in written correspondence delivered to the Planning Commission at, or prior to, the public hearing. If you need additional information on this matter or have questions, please contact the Planning Division at (626) 932-5565 or e-mail at planning@monroviaca.gov.
Este aviso es para informarle sobre una junta pública acerca de un cambio de la ley indicada arriba. Si necesita información adicional en español, favor de ponerse en contacto del Departamento de Planificación al número (626) 932-5565.
Sheri Bermejo
Community Development Director
Community Development Director
Project Location: Citywide
Contact Information:
Project Planner: Fiona Graham Planning Services Manager fgraham@ArcadiaCA.gov (626) 574-5442
City of Arcadia
W. Huntington Drive
Box 60021 Arcadia, CA 91066
A. Categorical Exemption from CEQA Pursuant to Section 15061(b)(3) of the CEQA Guidelines as it can be seen with certainty that the Text Amendment will have no impact on the environment; and
B. Text Amendment No. TA 24-01 (Ordinance No. 2401)
Project Description: Text Amendment No. 24-01 proposes revisions to several sections of the Arcadia Development Code, focusing on regulations for Accessory Dwelling Units (ADUs), the ADU Objective Design Standards, updates to the Residential Flex (RF) Overlay, as well as various minor amendments and changes throughout the Code.
Applicant: City of Arcadia
Hearing Date and Time: Tuesday, April 1, 2025 at 7:00 p.m.
Place of Hearing: Arcadia City Council Chambers, 240 W. Huntington Drive, Arcadia, CA

Project Location Map MAP
Publish March 20, 2025 MONROVIA WEEKLY
FOR
Peck Road & Mountain Ave. Infrastructure Improvement Project
PUBLIC HEARING SCHEDULED: A public hearing will be held by the Planning Commission of the City of Monrovia on Wednesday, April 9, 2025 at 7:30 p.m. or as soon thereafter as possible, to consider Ordinance No. 2025-03 and Planning Commission Resolution No. 2025-0001, adding Chapter 17.42 (Inclusionary Housing) to the Monrovia Municipal Code. The hearing will be held within Council Chambers of Monrovia City Hall located at 415 South Ivy Avenue, Monrovia, California. The Planning Commission’s decision will be a recommendation to the City Council for the final action on the ordinance. PROJECT TITLE: Ordinance No. 2025-03 and Planning Commission Resolution 2025-0001
(Inclusionary Housing).
NOTICE IS HEREBY GIVEN that the City of Monrovia, California (“City”) invites sealed Bids for the Project. The city will receive such Bids at the City Clerk’s office, City Hall, 415 South Ivy Avenue, Monrovia, California 91016 up to 2:00 p.m. on April 30, 2025, at which time they will be publicly opened and read aloud.
All Bids must be made on the form furnished by the city. Each Bid must be submitted in a sealed envelope addressed to the City Clerk with the Project name and identification number typed or clearly printed on the lower left corner of the envelope. Bids must remain valid and shall not be subject to withdrawal for sixty (60) Days after the Bid opening date.
INCORPORATION OF STANDARD SPECIFICATIONS - The 2021 edition of “Standard Specifications for Public Works Construction” (“Standard Specifications”), as amended by the Contract Documents, is incorporated into the Contract Documents by reference SCOPE OF WORK - The Project includes, without limitation, furnishing all necessary labor, materials, equipment, and other incidental and appurtenant Work necessary to satisfactorily complete the Project, as more specifically described in the Contract Documents. This Work will be performed in strict conformance with the Contract Documents, permits from regulatory agencies with jurisdiction, and applicable regulations. The quantity of Work to be performed and materials to be furnished are approximations only, being given as a basis for the comparison of Bids. Actual quantities of Work to be performed may vary at the discretion of the City Engineer.
The Project Includes:
Demolition of saw-cut concrete, remove curb and gutter, drive approaches, spandrel, concrete paving, ADA ramps, V-gutter, gutter pan, storm drain structure, saw-cut and remove AC pavement, tree root prune, cold mill AC pavement, excavation, and grading for all structures in the project. Adjust sewer manhole rings, storm drain rings, and other utility manholes. Protect in place all utility structures. Remove Traffic signal poles and structures.
Construction of: AC pavement rubberized w/fibers, patch AC pavement, tree root prune, concrete curb, curb and gutter, concrete pavement, drive approaches, sidewalk, spandrel, concrete pavement, loop detectors, AC patch adjust manholes, adjust sewer manholes to grade, adjust water valves to grade, ADA ramps, fill low spot in roadway, storm drain catch basin, grind bump in roadway, longitudinally grind concrete roadway for smoothness before AC pavement, adjust utility manholes and pull boxes, river rock mulch with concrete bedding at medians, tree wells, plant trees, provide and install new traffic signal and all apparatus, etc.
ADA striping and signage, construction staging and traffic control, public notification, pedestrian and vehicular access, protect in place existing structures, mobilization, demobilization, bond, and insurance.
The Engineer’s Estimate for this project is $ 5,285,069.00
OBTAINING BID DOCUMENTS - Project Bid Documents, will be available on “Box” and can be accessed by invitation only. Interested bidders are to contact James Merrell at james.merrell@merrelljohnson.com and request access to the project documents. The interested bidder must provide the name of the company, the company address, the contractor’s license number, and name of contact person and email address of contact person. The bidder will then be invited and given access to the bid documents. Bid documents may be viewed and downloaded to the bidder’s email site.
MANDATORY PRE-BID MEETING AND SITE VISIT - A mandatory pre-bid meeting will be held on Thursday April 10, 2025, at 11:00 a.m. at City of Monrovia Public Works Building at 600 South Mountain Ave. Every Potential Bidder is required to attend the prebid meeting and project site visit. Failure of a Bidder to attend will render that Bidder’s Bid non-responsive. No allowances for cost adjustments will be made if a Bidder fails to adequately examine the Project site before submitting a Bid.
TRENCHES AND OPEN EXCAVATIONS. Pursuant to Labor Code Section 6707, if this Project involves construction of a pipeline, sewer, sewage disposal system, boring and jacking pits, or similar trenches or open excavations, which are five feet or deeper, each bid submitted in response hereto shall contain, as a bid item, adequate sheeting, shoring, and bracing, or equivalent method, for the protection of life or limb, which shall conform to applicable safety orders.
REGISTRATION WITH THE DEPARTMENT OF INDUSTRIAL RELATIONS - In accordance with Labor Code Sections 1725.5 and 1771.1, no contractor or subcontractor shall be qualified to bid on, be listed in a bid proposal, subject to the requirements of Section 4104 of the Public Contract Code, or engage in the performance of any contract for public work, unless currently registered and qualified to perform public work pursuant to Section 1725.5 [with limited exceptions for bid purposes only under Labor Code Section 1771.1(a)].
PREVAILING WAGES - In accordance with Labor Code Section 1770 et seq., the Project is a “public work”. The selected Bidder (Contractor) and any Subcontractors shall pay wages in accordance with the determination of the Director of the Department of Industrial Relations (“DIR”) regarding the prevailing rate of per diem wages. Copies of those rates are on file with the Director of Public Works and are available to any interested party upon request. The Contractor shall post a copy of the DIR’s determination of the prevailing rate of per diem wages at each job site. This Project is subject to compliance monitoring and enforcement by the DIR.
BONDS - Each Bid must be accompanied by a cash deposit, cashier’s check, certified check, or Bidder’s Bond issued by a Surety insurer, made payable to the City and in an amount not less than ten percent (10%) of the total Bid submitted. Personal or company checks are not acceptable. Upon Contract award, the Contractor shall provide faithful performance and payment Bonds, each in a sum equal to the Contract Price. All Bonds must be issued by a California admitted Surety insurer using the forms set forth in the Contract Documents, or in any other form approved by the City Attorney. Failure to enter into the Contract with the City, including the submission of all required Bonds and insurance coverage, within
REQUEST:
fifteen (15) Days after the date of the mailing of written notice of contract award to the Bidder, shall subject the Bid security to forfeiture to the extent provided by law.
LICENSES - Each Bidder shall possess a valid Class “A” (General Engineering) Contractor’s license issued by the California State Contractors License Board at the time of the Bid submission. The successful Contractor will be required to obtain a current City business license.
Additional
ENVIRONMENTAL DETERMINATION: This project is Categorically Exempt from the
(CEQA) §1530
Quality Act (CEQA) §15301, (Class 1), which consists of the operation, repair, maintenance, permitting, leasing, licensing, or minor alteration of existing public or private structures, facilities, mechanical equipment, or topographical features, involving negligible or no expansion of existing or former use.
RETENTION SUBSTITUTION - Five percent (5%) of any progress payment will be withheld as retention. In accordance with Public Contract Code Section 22300, and at the request and expense of the Contractor, securities equivalent to the amount withheld may be deposited with the City or with a State or federally chartered bank as escrow agent, which shall then pay such moneys to the Contractor. Upon satisfactory completion of the Project, the securities shall be returned to the Contractor. Alternatively, the Contractor may request that the city make payments of earned retentions directly to an escrow agent at the Contractor’s expense. No such substitutions shall be accepted until all related documents are approved by the City Attorney.
APPLICANT: Tony Alhilo for Lofti Construction Design Build, Inc.
APPLICANT: Tony Alhilo for Lofti Construction Design Build, Inc.
PROJECT ADDRESS: 320 West Chestnut Avenue
PROJECT ADDRESS: 320 West Chestnut Avenue
LIQUIDATED DAMAGES - Liquidated damages shall accrue in the amount of $2,500.00 for each Day that Work remains incomplete beyond the Project completion deadline specified in the Contract Documents.
BIDDING PROCESS - The City reserves the right to reject any Bid or all Bids, and to waive any irregularities or informalities in any Bid or in the bidding, as deemed to be in its best interest.
/s/ Alice D. Atkins, MMC, City Clerk
Publish Thursday, March 20 and March 27, 2025 MONROVIA WEEKLY


Project Location Map
Project Location Map
HEARING DATE AND TIME: Wednesday, April 2, 2025 at 4:00 PM
HEARING DATE AND TIME: Wednesday April 2 2025 at 4:00 PM
HEARING LOCATION: Monrovia City Hall (Council Chambers), 415 South Ivy Avenue, Monrovia, California 91016
NOTICE IS HEREBY GIVEN that, at 7:30 p.m., or as soon thereafter as the matter can be heard, on April 1, 2025, at the City Council Chambers, 415 South Ivy Avenue, Monrovia, California, the City Council of the City of Monrovia (the “City”) will conduct a public hearing as required by Section 147(f) of the Internal Revenue Code of 1986 (the “Code”), at which it will hear and consider information concerning a proposed plan of financing providing for the issuance by the California Statewide Communities Development Authority of qualified 501(c)(3) bonds, as defined in Section 145 of the Code in one or more series issued from time to time, including bonds issued to refund such qualified 501(c)(3) bonds in one or more series from time to time, and at no time to exceed $65,000,000 in outstanding aggregate principal amount, to finance or refinance the acquisition and rehabilitation of a multifamily rental housing project located at 125 West Olive Avenue, Monrovia, California (the “Project”). The Project is or will be owned and operated by Foothill Oak Park Apartments, LLC (the “Borrower”) which is an organization described in Section 501(c)(3) of the Code.
HEARING LOCATION: Monrovia City Hall (Council Chambers), 415 South Ivy Avenue, Monrovia, California 91016
PUBLIC COMMENTS: Public comments regarding this item may be stated in person at meeting, or submitted in writing. To ensure that Development Review Committee members have time to review, written comments must submitted by 3:00 p.m. on April 2 2025
PUBLIC COMMENTS: Public comments regarding this item may be stated in person at the meeting, or submitted in writing. To ensure that Development Review Committee members have time to review, written comments must be submitted by 3:00 p.m. on April 2, 2025.
If you challenge this application in court, you may be limited to raising only those issues you or someone else raised at the public hearing described in this notice, or in written correspondence delivered to the Planning Division at, or prior to, the public hearing. This application will not alter the zoning status of your property. For further information regarding this application, please contact the Planning Division at (626) 932-5565, or by email at planning@monroviaca.gov.
Supporting documents for this project will be available online after 4:00 p.m. on Thursday, March 27, 2025, at the following hyperlink: https://www.monroviaca.gov/your-government/boards-and-commissions/planning-commission/agendas-minutes
Those wishing to comment on the proposed financing or refinancing and the nature and location of the Project may either appear in person at the public hearing or submit written comments, which must be received by the City prior to the hearing. Written comments should be sent to City of Monrovia at 415 South Ivy Avenue, Monrovia, California 91016, Attention: City Clerk or emailed to cityclerk@monroviaca.gov.
/s/ Alice D. Atkins, MMC, City Clerk
Publish Thursday, March 20, 2025 MONROVIA WEEKLY
MONROVIA DEVELOPMENT REVIEW COMMITTEE
This Notice is to inform you of a public hearing to determine whether or not the following project should be granted under Title 16 and/or 17 of the Monrovia Municipal Code:
APPLICATION: Minor Conditional Use Permit (MCUP2025-0003)
REQUEST: Applicant is requesting a Minor Conditional Use Permit (mCUP) to allow the operation of an Adult Day Care use (NOVA CBAS) within an existing industrial building located at 318-320 West Chestnut Avenue. The property is located in the M (Manufacturing) zone.
Additional information regarding this request may be found on the City’s website at https://www.monroviaca. gov/projectsunderreview
ENVIRONMENTAL
DETERMINATION:
Este aviso es para informarle sobre una junta pública acerca de la propiedad indicada más arriba. Si necesita información adicional en español, favor de ponerse en contacto con el Departamento de Planificación al número (626) 932-5565.
Austin Arnold, Assistant Planner
Publish March 20, 2025 MONROVIA WEEKLY
CITY OF EL MONTE CITY COUNCIL NOTICE OF PUBLIC HEARING
Hablamos Español favor de hablar con Jeni Colon (626) 258-8626
TO: All Interested Parties
FROM: City of El Monte Planning Division
APPLICATIONS: • Code Amendment (AMEND) No. 012024 and Code Amendment No. 808: Title 17 (Zoning Code) of the El Monte Municipal Code (EMMC);
• Zoning Map Amendment (AMEND) No. 02-2024: Amendment to the Zoning Map to replace the Mixed/Multiuse (M/MU) and General Commercial (C-3) Zoning District Designations indicated on the Zoning Map for the Project Area with the new Urban/Multiuse (U/MU) Zoning District; and
• Zoning Change (ZONE) No. 02-2024: Amendment to the Code to incorporate permitted uses and development standards for the proposed Urban Multiuse
(U/MU) Zoning District.
PROPERTY LOCATION: Code Amendment (AMEND) No. 012024 and Code Amendment No. 808: –apply to properties citywide; Zoning Map Amendment (AMEND) No. 02-2024 and Zoning Change (ZONE) No. 02-2024 – Establish a new U/MU Zoning District and associated development standards for parcels along the Garvey Avenue Corridor and 5-Points area that comprises of an approximately 2.2 mile segment of Garvey Avenue, approximately 50 feet east of Potrero Avenue to the site’s eastern boundary located approximately 430 feet west of the intersection of Garvey Avenue, Valley Boulevard, Mountain View Road, and Cogswell Road.
TO BE CONSIDERED:
Title 17 (Zoning Code) of the EMMC (AMEND No. 01-2024 & CA No. 808)
Zoning Code Updates to the following Divisions –
•Division 00 – Table of Contents
• Division A – Matrix of Permitted Uses.
• Division 1 – General Regulations; Rules and Measurements; Zoning Classifications and Map; and Nonconforming Provisions.
• Division 2 – One-Family Dwelling Residential Zones and Multiple-Family Dwelling Residential Zones.
• Division 3 – Multiuse Zoning Districts
• Division 4 – Commercial & Manufacturing Zoning Districts; and Public and Quasi-Public Zones.
• Division 5 – Performance Standards.
• Division 6 – General Property Development Standards.
• Division 7 – Parking Regulations; Landscape Regulations; and Landscape Water Efficiency.
• Division 8 – Signage Regulations and Billboard Overlay Zone
•Division 10 – Affordable Housing; Density Bonus Provisions; Inclusionary Housing; and Affordable Housing in Commercial Areas.
•Division 11 – Regulations for Specific Residential Uses, Corridor Housing; and Religious Institutions Housing.
• Division 12 – Zoning Clearance and Business Occupancy Permits; Initial Plan Review; Design and Minor Design Review; Temporary Use Permits; and Planning Residential Developments.
•Division 13 – Specific Plans; Gateway Specific Plan; Downtown Specific Plan and Esperanza Village Specific Plan.
•Division 15 – Use Definitions; and General Definitions.
Zoning Map Amendment (AMEND 022024) – Amendment to the Zoning Map to replace the Mixed/Multiuse (M/MU) and General Commercial (C-3) Zoning District Designations indicated on the Zoning Map for the Project Area with the new Urban/Multiuse (U/MU) Zoning District; and Zoning Change (ZONE) No. 02-2024: Amendment to the Code to incorporate permitted uses and development standards for the proposed Urban Multiuse (U/MU) Zoning District.
The entitlements noted above are made pursuant to Chapters 17.128 (General Plan and Zoning Amendments) of the EMMC.
APPLICANT: City of El Monte
ENVIRONMENTAL
DOCUMENTATION:
Pursuant to CEQA Guidelines, Section 15164, an Addendum was prepared to a previously Certified EIR that was prepared in June 2011 for the El Monte General Plan and Zoning Code Update Final Environmental Impact Report (GP EIR). Since then, the City adopted the updated 2021-2029 Housing Element in February 2022. CEQA review required for the project may tier from the Certified GP EIR pursuant to CEQA Guidelines Section 15152. The Addendum demonstrates that through its analysis that the proposed project would not result in substantial changes requiring major revisions to the previ-
ously Certified GP EIR, therefore, no new mitigation measures are required for the proposed project.
PLACE OF HEARING: The City Council will hold a public hearing to receive testimony, orally and in writing, on the proposed project. The public hearing is scheduled for the following date, time, and location:
Dates: Wednesday, April 9, 2025 Time: 7:00 p.m.
Place: El Monte City Hall East – Council Chambers11333 Valley Boulevard, El Monte, California
Members of the public wishing to observe the meeting may do so in one of the following ways:
(1)Turn your TV to Channel 3; (2)City’s website at http://www.elmonteca.gov/378/Council-Meeting-Videos; or (3)In Person
Persons wishing to offer public comment for this meeting may do so in one of the following ways:
(1) By directly addressing the City Council in person at the time(s) allotted on the agenda for such comment. Persons wishing to address the City Council in person are asked to fill-out a blue speaker card providing their name and indicating the specific agenda item(s) they wish to comment on or if they wish to speak during the portion of the agenda designated for comment on non-agendized matters. Speaker cards should be handed to City staff) before the City Council’s approval of the agenda, if possible. The City Council shall be under no obligation to recognize a speaker who submits a speaker card on a particular agenda item after the City Council has completed its handling of the agenda item and has moved on to the next item of business on the agenda. As members of the public are now free to attend City Council meetings in person, the City Council will no longer receive public comment by telephone.
(2) E-mail – All interested parties can submit questions/comments in advance to the Planning Division’s general e-mail address: planning@elmonteca.gov. All questions/comments must be received by the Planning Division no later than 12:00 pm on April 9, 2025. The staff report on this matter will be available before the City Council meeting on the City of El Monte website, which may be accessed at https://www.ci.el-monte.ca.us/AgendaCenter/ or by e-mailing selias@elmonteca.gov.
the next item of business onthe agenda. Asmembersof the public arenow freeto attend CityCouncil meetings inperson, theCity Council will no longer receive public comment by telephone. (2) E-mail –All interested parties cansubmit questions/comments in advance tothe Planning Division’s general e-mail address: planning@elmonteca.gov. All questions/comments must be receivedby the Planning Division no laterthan12:00 pm onApril9, 2025.
COMBINED NOTICE OF PUBLIC REVIEW/ COMMENT PERIOD AND PUBLIC HEARING FOR THE DRAFT 2025-2029 CONSOLIDATED PLAN, 2025-2029 CITIZEN PARTICIPATION PLAN, 20252029 ANALYSIS OF IMPEDIMENTS TO FAIR HOUSING CHOICE, AND 2025-2026 ACTION PLAN
NOTICE IS HEREBY GIVEN that a draft copy of the City of Rosemead’s 2025-2029 Consolidated Plan, 2025-2029 Citizen Participation Plan, 2025-2029 Analysis of Impediments to Fair Housing Choice, and 2025-2026 Action Plan (documents) are available for review as required by the Department of Housing and Urban Development (HUD). This 30-day public review and comment period begins March 20, 2025, and will run through April 21, 2025. Copies of the draft documents will be available for public review on the City's website and at City Hall (8838 East Valley Boulevard, Rosemead, CA 91770). The public is invited to submit written comments or questions on the draft document to the Housing Division at City Hall, by phone at (626) 569-2153, or by email to degarcia@cityofrosemead.org.
NOTICE IS HEREBY FURTHER GIVEN that the Rosemead City Council will conduct a public hearing on the draft documents on Tuesday, April 22, 2025, at 7:00 PM, at Rosemead City Hall, located at 8838 East Valley Boulevard, Rosemead, California 91770. Any person interested in the above proceedings to provide their community may provide oral public comments at the public hearing, submitting in writing through email at publiccomment@cityofrosemead. org before 5:00 p.m. on Tuesday, April 22, 2025, or by calling (626) 569-2100. All comments are public record and will be recorded in the official record of the City. If you have a request for an accommodation under the ADA, please contact Ericka Hernandez, City Clerk, at (626) 569-2100.
The City Council Agenda and Staff Report will be available on the City’s website under “City Calendar” (www.cityofrosemead.org) at least 72 hours in advance of the public hearing.
2025-2029 CONSOLIDATED PLAN: A five-year document submitted to HUD that serves as a comprehensive housing affordability strategy, community development plan, and submission for funding under any of HUD’s entitlement formula grant programs.
2025-2029 CITIZEN PARTICIPATION PLAN: A five-year document that sets forth the City of Rosemead’s policies and procedures for providing citizens and other interested parties with opportunities to participate in an advisory role in the planning, implementation, and evaluation of the Community Development and Block Grant (CDBG) and HOME Investment Partnerships (HOME) programs.
The staffreport on this matter will be available before the City Council meeting on the City of El Monte website, which may be accessedat https://www.ci.el-monte.ca.us/AgendaCenter/or by e-mailing selias@elmonteca.gov.
Americans With Disabilities Act: In compliance with Section 202 of the Americans with Disabilities Act of 1990 (42 U.S.C. Sec. 12132) and the federal rules and regulations adopted in implementation thereof, the Agenda will be made available in appropriate alternative formats to persons with a disability. Should you need special assistance to participate in this meeting, please contact the City Clerk’s Office by calling (626) 580-2016. Notification 48 hours prior to the meeting will enable the City to make reasonable arrangements to ensure accessibility to this meeting.
Americans With Disabilities Act: Incompliance with Section 202 ofthe Americans with Disabilities Actof 1990 (42 U.S.C. Sec. 12132)and thefederal rules and regulations adopted in implementationthereof,the Agenda will be made available in appropriate alternative formats to persons with a disability. Shouldyou need special assistancetoparticipate inthis meeting, please contactthe CityClerk’sOffice by calling (626)5802016. Notification 48 hours prior to themeetingwill enablethe City tomake reasonablearrangements to ensureaccessibility to this meeting.
Persons wishing to comment on the proposed application may do so orally at the public hearing or in writing prior to the meeting date and must be received by 12:00 pm the day of the meeting. Written comments shall be sent to Sandra Elias; El Monte City Hall West; 11333 Valley Boulevard; El Monte, CA 91731 or at selias@elmonteca.gov. If you challenge the decision of the City Council, in court, you may be limited to raising only those issues you or someone else raised at the public hearing described in this notice, or in written correspondence delivered to the City Council at, or prior to, the public hearing. For further information regarding this application please contact Sandra Elias, City Planner at selias@elmonteca.gov Monday through Thursday, except legal holidays, between the hours of 7:00 a.m. and 5:30 p.m.
2025-2029 ANALYSIS OF IMPEDIMENTS TO FAIR HOUSING CHOICE: A comprehensive five-year document that promotes fair housing and examines barriers to equal housing access based on protected characteristics, like race, color, ancestry, national origin, religion, sex, disability, marital status, familial status, or other arbitrary factors. The Analysis of Impediments to Fair Housing Choice examines laws, regulations, conditions, or other barriers that may limit an individual or household's access to housing.
Persons wishing tocomment ontheproposedapplication may dosoorally at the public hearing or in writing prior to the meeting date andmust be received by 12:00 pm theday of the meeting. Written comments shall be sent to Sandra Elias; El Monte City Hall West; 11333 Valley Boulevard;El Monte,CA 91731 or at selias@elmonteca.gov. If you challenge the decision of the City Council, in court, youmay belimitedtoraising only those issues you or someone elseraised at the public hearing described in this notice, or inwritten correspondence delivered to the City Council at, orpriorto,the public hearing. Forfurther information regarding this applicationplease contactSandra Elias, City Planner atselias@elmonteca.gov Monday through Thursday, except legal holidays, between the hours of 7:00 a.m. and 5:30 p.m. Published On:Monday,March 20, 2025 Gabriel Ramirez, City Clerk
Gabriel Ramirez, City Clerk






2025-2026 ACTION PLAN: serves as the annual application for federal funds under the HUD CDBG and HOME formula grant program. The City anticipates receiving approximately $584,000 in CDBG funds and $228,000 in HOME funds to support eligible projects during the Program Year 2025-2026.
Publication Date: March 20, 2025 ROSEMEAD READER
NOTICE OF PETITION TO ADMINISTER ESTATE OF: DAVID JIMENEZ JR. CASE NO. 25STPB00848
To all heirs, beneficiaries, creditors, contingent creditors, and persons who may otherwise be interested in the WILL or estate, or both of DAVID JIMENEZ JR..
A PETITION FOR PROBATE has been filed by JIANMEI ZHAO in the Superior Court of California, County of LOS ANGELES. THE PETITION FOR PROBATE requests that JIANMEI ZHAO be appointed as personal representative to administer the estate of the decedent.
THE PETITION requests authority to administer the estate under the Independent Administration of Estates Act. (This authority will allow the personal representative to take many actions without obtaining court approval. Before taking certain very important actions, however, the personal representative will be required to give notice to interested persons unless they have waived notice or
consented to the proposed action.) The independent administration authority will be granted unless an interested person files an objection to the petition and shows good cause why the court should not grant the authority.
A HEARING on the petition will be held in this court as follows: 06/24/25 at 8:30AM in Dept. 5 located at 111 N. HILL ST., LOS ANGELES, CA 90012
IF YOU OBJECT to the granting of the petition, you should appear at the hearing and state your objections or file written objections with the court before the hearing. Your appearance may be in person or by your attorney.
IF YOU ARE A CREDITOR or a contingent creditor of the decedent, you must file your claim with the court and mail a copy to the personal representative appointed by the court within the later of either (1) four months from the date of first issuance of letters to a general personal representative, as defined in section 58(b) of the California Probate Code, or (2) 60 days from the date of mailing or personal delivery to you of a notice under section 9052 of the California Probate Code.
Other California statutes and legal authority may affect your rights as a creditor. You may want to consult with an attorney knowledgeable in California law.
YOU MAY EXAMINE the file kept by the court. If you are a person interested in the estate, you may file with the court a Request for Special Notice (form DE-154) of the filing of an inventory and appraisal of estate assets or of any petition or account as provided in Probate Code section 1250. A Request for Special Notice form is available from the court clerk. Attorney for Petitioner
FANG L. CHEN - SBN 315706
THE LAW OFFICES OF FANG CHEN 20657 GOLDEN SPRINGS DR #209
DIAMOND BAR CA 91789
Telephone (626) 512-8990 3/17, 3/20, 3/24/25 CNS-3905657# EL MONTE EXAMINER
NOTICE OF PETITION TO ADMINISTER ESTATE OF:
SUSANNE K. PASSENTINO CASE NO. 25STPB02772
To all heirs, beneficiaries, creditors, contingent creditors, and persons who may otherwise be interested in the WILL or estate, or both of SU-
SANNE K. PASSENTINO.
A PETITION FOR PROBATE has been filed by STEPHANIE QUINTERO in the Superior Court of California, County of LOS ANGELES. THE PETITION FOR PROBATE requests that STEPHANIE QUIN-
TERO be appointed as personal representative to administer the estate of the decedent.
THE PETITION requests authority to administer the estate under the Independent Administration of Estates Act with limited authority.
(This authority will allow the personal representative to take many actions without obtaining court approval. Before taking certain very important actions, however, the personal representative will be required to give notice to interested persons unless they have waived notice or consented to the proposed action.) The independent administration authority will be granted unless an interested person files an objection to the petition and shows good cause why the court should not grant the authority.
A HEARING on the petition will be held in this court as follows: 04/11/25 at 8:30AM in Dept. 67 located at 111 N. HILL ST., LOS ANGELES, CA 90012
IF YOU OBJECT to the granting of the petition, you should appear at the hearing and state your objections or file written objections with the court before the hearing. Your appearance may be in person or by your attorney.
IF YOU ARE A CREDITOR or a contingent creditor of the decedent, you must file your claim with the court and mail a copy to the personal representative appointed by the court within the later of either (1) four months from the date of first issuance of letters to a general personal representative, as defined in section 58(b) of the California Probate Code, or (2) 60 days from the date of mailing or personal delivery to you of a notice under section 9052 of the California Probate Code. Other California statutes and legal authority may affect your rights as a creditor. You may want to consult with an attorney knowledgeable in California law.
YOU MAY EXAMINE the file kept by the court. If you are a person interested in the estate, you may file with the court a Request for Special Notice (form DE-154) of the filing of an inventory and appraisal of estate assets or of any petition or account as provided in Probate Code section 1250. A Request for Special Notice form is available from the court clerk. Attorney for Petitioner
JENNIFER L. FIELD - SBN 236565
LAW OFFICE OF JENNIFER L. FIELD
405 N INDIAN HILL BLVD
CLAREMONT CA 91711
Telephone (909) 625-0220
BSC 226557
3/17, 3/20, 3/24/25
CNS-3905827# AZUSA BEACON
NOTICE OF PETITION TO ADMINISTER ESTATE OF:
ALLEN H. LASKO
CASE NO. 25STPB00077
To all heirs, beneficiaries, creditors, contingent creditors, and persons
who may otherwise be interested in the WILL or estate, or both of ALLEN H. LASKO.
A PETITION FOR PROBATE has been filed by RUTH JAINESE in the Superior Court of California, County of LOS ANGELES. THE PETITION FOR PROBATE requests that RUTH JAINESE be appointed as personal representative to administer the estate of the decedent.
THE PETITION requests authority to administer the estate under the Independent Administration of Estates Act. (This authority will allow the personal representative to take many actions without obtaining court approval. Before taking certain very important actions, however, the personal representative will be required to give notice to interested persons unless they have waived notice or consented to the proposed action.)
The independent administration authority will be granted unless an interested person files an objection to the petition and shows good cause why the court should not grant the authority.
A HEARING on the petition will be held in this court as follows: 04/23/25 at 8:30AM in Dept. 2D located at 111 N. HILL ST., LOS ANGELES, CA 90012
IF YOU OBJECT to the granting of the petition, you should appear at the hearing and state your objections or file written objections with the court before the hearing. Your appearance may be in person or by your attorney.
IF YOU ARE A CREDITOR or a contingent creditor of the decedent, you must file your claim with the court and mail a copy to the personal representative appointed by the court within the later of either (1) four months from the date of first issuance of letters to a general personal representative, as defined in section 58(b) of the California Probate Code, or (2) 60 days from the date of mailing or personal delivery to you of a notice under section 9052 of the California Probate Code. Other California statutes and legal authority may affect your rights as a creditor. You may want to consult with an attorney knowledgeable in California law.
YOU MAY EXAMINE the file kept by the court. If you are a person interested in the estate, you may file with the court a Request for Special Notice (form DE-154) of the filing of an inventory and appraisal of estate assets or of any petition or account as provided in Probate Code section 1250. A Request for Special Notice form is available from the court clerk.
Attorney for Petitioner
ZACHARIAS N. TRIPODES - SBN 311595
LAGERLOF, LLP 155 N LAKE AVE FLR 11 PASADENA CA 91101 Telephone (626) 793-9400 BSC 226564 3/20, 3/24, 3/27/25 CNS-3905845# MONROVIA WEEKLY
NOTICE OF PETITION TO ADMINISTER ESTATE OF: LILY YING CASE NO. 25STPB02802
To all heirs, beneficiaries, creditors, contingent creditors, and persons who may otherwise be interested in the WILL or estate, or both of LILY YING.
A PETITION FOR PROBATE has been filed by FLORENCE PHOON in the Superior Court of California, County of LOS ANGELES. THE PETITION FOR PROBATE requests that FLORENCE PHOON be appointed as personal representative to administer the estate of the decedent.
THE PETITION requests authority to administer the estate under the Independent Administration of Estates Act. (This authority will allow the personal representative to take many actions without obtaining court approval. Before taking certain very important actions, however, the personal representative will be required to give notice to interested persons unless they have waived notice or consented to the proposed action.) The independent administration authority will be granted unless an interested person files an objection to the petition and shows good cause why the court should not grant the authority.
A HEARING on the petition will be held in this court as follows: 04/18/25 at 8:30AM in Dept. 44 located at 111 N. HILL ST., LOS ANGELES, CA 90012-3117
IF YOU OBJECT to the granting of the petition, you should appear at the hearing and state your objections or file written objections with the court before the hearing. Your appearance may be in person or by your attorney.
IF YOU ARE A CREDITOR or a contingent creditor of the decedent, you must file your claim with the court and mail a copy to the personal representative appointed by the court within the later of either (1) four months from the date of first issuance of letters to a general personal representative, as defined in section 58(b) of the California Probate Code, or (2) 60 days from the date of mailing or personal delivery to you of a notice under section 9052 of the California Probate Code.
Other California statutes and legal authority may affect your rights as a creditor. You may want to consult with an attorney knowledgeable in California law.
YOU MAY EXAMINE the file kept by the court. If you are a person interested in the estate, you may file with the court a Request for Special Notice (form DE-154) of the filing of an inventory and appraisal of estate assets or of any petition or account as provided in Probate Code section 1250. A Request for Special Notice form is available from the court clerk. Attorney for Petitioner
RICHARD L. CHINEN - SBN 105407, BARBARO, CHINEN, PITZER & DUKE LLP
301 E COLORADO BLVD STE 700 PASADENA CA 91101
Telephone (626) 793-5196
3/20, 3/24, 3/27/25 CNS-3906111# ARCADIA WEEKLY
NOTICE OF PETITION TO ADMINISTER ESTATE OF:
LUCIA LARA CASE NO. 25STPB02586
To all heirs, beneficiaries, creditors, contingent creditors, and persons who may otherwise be interested in the WILL or estate, or both of LUCIA LARA.
A PETITION FOR PROBATE has been filed by GLENN LARA in the Superior Court of California, County of LOS ANGELES.
THE PETITION FOR PROBATE requests that GLENN LARA be appointed as personal representative to administer the estate of the decedent.
THE PETITION requests authority to administer the estate under the Independent Administration of Estates Act. (This authority will allow the personal representative to take many actions without obtaining court approval. Before taking certain very important actions, however, the personal representative will be required to give notice to interested persons unless they have waived notice or consented to the proposed action.)
The independent administration authority will be granted unless an interested person files an objection to the petition and shows good cause why the court should not grant the authority.
A HEARING on the petition will be held in this court as follows: 04/07/25 at 8:30AM in Dept. 9 located at 111 N. HILL ST., LOS ANGELES, CA 90012
IF YOU OBJECT to the granting of the petition, you should appear at the hearing and state your objections or file written objections with the court before the hearing. Your appearance may be in person or by your attorney.
IF YOU ARE A CREDITOR or a contingent creditor of the decedent, you must file your claim with the court and mail a copy to the personal representative appointed by the court within the later of either (1) four months from the date of first issuance of letters to a general personal representative, as defined in section 58(b) of the California Probate Code, or (2) 60 days from the date of mailing or personal delivery to you of a notice under section 9052 of the California Probate Code. Other California statutes and legal authority may affect your rights as a creditor. You may want to consult with an attorney knowledgeable in California law.
YOU MAY EXAMINE the file kept by the court. If you are a person interested in the estate, you may file with the court a Request for Special Notice (form DE-154) of the filing of an inventory and appraisal of estate assets or of any petition or account as provided in Probate Code section 1250. A Request for Special Notice
form is available from the court clerk. Attorney for Petitioner
BYRON R. LANE - SBN 132625 LANE LAW GROUP, INC.
28924 S. WESTERN AVE. STE 206 RANCHO PALOS VERDES CA 90275
Telephone (310) 521-5300 3/20, 3/24, 3/27/25 CNS-3906277# EL MONTE EXAMINER
NOTICE OF PETITION TO ADMINISTER ESTATE OF: RAUL GUILLEN, JR. CASE NO. 24STPB03866
To all heirs, beneficiaries, creditors, contingent creditors, and persons who may otherwise be interested in the WILL or estate, or both of RAUL GUILLEN, JR.
A PETITION FOR PROBATE has been filed by JEROME GUILLEN in the Superior Court of California, County of LOS ANGELES.
THE PETITION FOR PROBATE requests that JEROME GUILLEN be appointed as personal representative to administer the estate of the decedent.
THE PETITION requests authority to administer the estate under the Independent Administration of Estates Act. (This authority will allow the personal representative to take many actions without obtaining court approval. Before taking certain very important actions, however, the personal representative will be required to give notice to interested persons unless they have waived notice or consented to the proposed action.)
The independent administration authority will be granted unless an interested person files an objection to the petition and shows good cause why the court should not grant the authority.
A HEARING on the petition will be held in this court as follows: 04/10/25 at 8:30AM in Dept. 4 located at 111 N. HILL ST., LOS ANGELES, CA 90012
IF YOU OBJECT to the granting of the petition, you should appear at the hearing and state your objections or file written objections with the court before the hearing. Your appearance may be in person or by your attorney.
IF YOU ARE A CREDITOR or a contingent creditor of the decedent, you must file your claim with the court and mail a copy to the personal representative appointed by the court within the later of either (1) four months from the date of first issuance of letters to a general personal representative, as defined in section 58(b) of the California Probate Code, or (2) 60 days from the date of mailing or personal delivery to you of a notice under section 9052 of the California Probate Code.
Other California statutes and legal authority may affect your rights as a creditor. You may want to consult with an attorney knowledgeable in California law.
YOU MAY EXAMINE the file kept by the court. If you are a person interested in the estate, you may file with the court a Request for Special Notice (form DE-154) of the filing of an inventory and appraisal of estate assets or of any petition or account as provided in Probate Code section 1250. A Request for Special Notice form is available from the court clerk. Attorney for Petitioner
C. TRACY KAYSER - SBN 230022
KAYSER LAW GROUP, APC 1407 N. BATAVIA ST., SUITE 103 ORANGE CA 92867 Telephone (714) 984-2004
BSC 226583 3/20, 3/24, 3/27/25 CNS-3906597# EL MONTE EXAMINER
NOTICE OF PETITION TO ADMINISTER ESTATE OF: WILLIAM PERRON CASE NO. 25STPB01321
To all heirs, beneficiaries, creditors, contingent creditors, and persons who may otherwise be interested in the WILL or estate, or both of WILLIAM PERRON.
A PETITION FOR PROBATE has been filed by JOHN PERRON in the Superior Court of California, County of LOS ANGELES.
THE PETITION FOR PROBATE requests that JOHN PERRON be appointed as personal representative to administer the estate of the decedent.
THE PETITION requests authority to administer the estate under the Independent Administration of Estates Act. (This authority will allow
the personal representative to take many actions without obtaining court approval. Before taking certain very important actions, however, the personal representative will be required to give notice to interested persons unless they have waived notice or consented to the proposed action.) The independent administration authority will be granted unless an interested person files an objection to the petition and shows good cause why the court should not grant the authority.
A HEARING on the petition will be held in this court as follows: 04/04/25 at 8:30AM in Dept. 9 located at 111 N. HILL ST., LOS ANGELES, CA 90012
IF YOU OBJECT to the granting of the petition, you should appear at the hearing and state your objections or file written objections with the court before the hearing. Your appearance may be in person or by your attorney.
IF YOU ARE A CREDITOR or a contingent creditor of the decedent, you must file your claim with the court and mail a copy to the personal representative appointed by the court within the later of either (1) four months from the date of first issuance of letters to a general personal representative, as defined in section 58(b) of the California Probate Code, or (2) 60 days from the date of mailing or personal delivery to you of a notice under section 9052 of the California Probate Code.
Other California statutes and legal authority may affect your rights as a creditor. You may want to consult with an attorney knowledgeable in California law.
YOU MAY EXAMINE the file kept by the court. If you are a person interested in the estate, you may file with the court a Request for Special Notice (form DE-154) of the filing of an inventory and appraisal of estate assets or of any petition or account as provided in Probate Code section 1250. A Request for Special Notice form is available from the court clerk.
Attorney for Petitioner
EMANUEL THOMAS, ESQ. - SBN 311906
THE THOMAS FIRM 4017 LONG BEACH BLVD. LONG BEACH CA 90807
Telephone (562) 349-0700
3/20, 3/24, 3/27/25
CNS-3906610# EL MONTE EXAMINER
ORDER TO SHOW CAUSE FOR CHANGE OF NAME PETITION OF Lidia Almaraz FOR CHANGE OF NAME CASE NUMBER: 25NNCP00151 Superior Court of California, County of Los Angeles 300 E Olive Ave, Burbank, Ca 91502, North Central Judicial District TO ALL INTERESTED
Pacific Time. The TTC will re-offer any properties that did not sell or were not redeemed prior to Friday, June 6, 2025, at 5:00 p.m. Pacific Time, for sale at the online public auction at www.govease.com/los-angeles beginning Saturday, June 7, 2025, at 3:00 p.m. Pacific Time, through Tuesday, June 10, 2025, at 12:00 p.m. Pacific Time. Information regarding this sale is available at ttc.lacounty.gov. Bidders are required to preregister at www.govease.com/ los-angeles and submit a deposit of 10 percent of the spend limit that is set by each registered bidder. Bid deposits must be in the form of a wire transfer, cashier’s check or bank-issued money order at the time of registration. Registration will begin on Friday, March 14, 2025, at 8:00 a.m. Pacific Time and end on Tuesday, April 15, 2025, at 5:00 p.m. Pacific Time.
Pursuant to R&TC Section 3692.3, TTC sells all property ``as is`` and the County and its employees are not liable for any known or unknown conditions of the properties, including, but not limited to, errors in the records of the Office of the Assessor (Assessor) pertaining to improvement of the property.
If TTC sells a property, parties of interest, as defined by R&TC Section 4675, have a right to file a claim with the County for any proceeds from the sale, which are in excess of the liens and costs required to be paid from the proceeds. If there are any excess proceeds after the application of the minimum bid, TTC will send notice to all parties of interest, pursuant to State law. Please direct requests for information concerning redemption of tax-defaulted property to the Treasurer and Tax Collector, at 225 North Hill Street, Room 130, Los Angeles, California 90012. Phone calls can be directed to (213) 9742045, Monday through Friday, 8:00 a.m. to 5:00 p.m. Pacific Time. TTC’s website is located at ttc.lacounty.gov and emails can be directed to auction@ttc.lacounty.gov.

PERSONS: 1. Petitioner Lidia Almaraz filed a petition with this court for a decree changing names as follows: Present name a. OF Lidia Almaraz to Proposed name Lidia Molina Sandoval 2. THE COURT ORDERS that all persons interested in this matter shall appear before this court at the hearing indicated below to show cause, if any, why the petition for change of name should not be granted. Any person objecting to the name changes described above must file a written objection that includes the reason for the objection at least two court days before the matter is scheduled to be heard and must appear at the hearing to show cause why the petition should not be granted. If no written objection is timely filed, the court may grant the petition without a hearing NOTICE OF HEARING a. Date: 04/25/2025 Time: 8:30AM Dept: A. The address of the court is same as noted above. 3. a. A copy of this Order to Show Cause shall be published at least once each week for four successive weeks prior to the day set for hearing on the petition in the following newspaper of general circulation, printed in this county: El Monte Examiner DATED: February 24, 2025 Robin Miller Sloan JUDGE OF THE SUPERIOR COURT Pub. February 27, March 6, 13, 20, 2025 EL MONTE EXAMINER County of Los Angeles Department of the Treasurer and Tax Collector Notice of Divided Publication Pursuant to Revenue and Taxation Code (R&TC) Sections 3702,
The Assessor’s Identification Number (AIN) in this publication refers to the Assessor’s Map Book, the Map Page, and the individual Parcel Number on the Map Page. If a change in the AIN occurred, the publication will show both prior and current AINs. An explanation of the parcel numbering system and the referenced maps are available at the Office of the Assessor located at 500 West Temple Street, Room 225, Los Angeles, California 90012, or at assessor.lacounty.gov. I certify under penalty of perjury that the foregoing is true and correct. Executed at Los Angeles, California, on February 27, 2025.


deal and imposed the stipulated sentence. In addition to probation, the judge ordered Betts to serve a day in county jail, but that was expected to be a so-called "paper commitment," in which the party appears and is signed into the correctional facility, then is immediately released due to space constraints.
According to the District Attorney's Office, on the morning of last Aug. 4, Betts was driving in the area of Palm Drive and Eighth Street in Desert Hot Springs when the victim, identified only as "K.S.," went past him, using the roadway shoulder instead of a traffic lane, angering the defendant, who threw a hand gesture and then followed the young man.
The victim stopped in a convenience store parking lot, where Betts parked immediately behind him, effectively blocking the motorist from leaving.
There was a brief verbal exchange, after which the

victim attempted to back out, lightly tapping Betts' vehicle in the process, enraging the defendant, according to published reports.
Prosecutors said Betts hit and kicked the victim's two-door sedan, causing visible damage, then drove away.
The incident was reported to the Desert Hot Springs Police Department, but the matter was referred to the DA's office for further investigation because it involved a public figure.
Betts had no documented prior felony or misdemeanor convictions.
By City News Service
A25-year-old man who joined his brother in a takeover robbery at a Banning cannabis store where two people were stabbed and another almost shot was bound for state prison Monday to begin serving a sentence of 21 years to life behind bars.
Raymond Emilio Paul Matus of Beaumont was convicted nearly a year ago of attempted murder, robbery, assault with a deadly weapon and sentence- enhancing allegations of using a deadly weapon in the commission of a felony and inflicting great bodily injury.

attempted to subdue Richard Matus and prevent him from retaking possession of the pistol. According to the prosecution, "the defendant looked at the struggle for the gun that was occurring ... and stabbed Harris from behind."


Matus changed attorneys after his conviction and submitted numerous motions, including for a new trial, that were finally disposed Friday, when Riverside County Superior Court Judge Steven Counelis moved forward with imposing the prison sentence during a hearing at the Riverside Hall of Justice.
His older brother Richard Matus Jr. died from fentanyl poisoning at the Byrd Detention Center in Murrieta in 2022. He was 29.
According to a trial brief filed by the District Attorney's Office, on the night of June 23, 2018, the defendants targeted the Go Green Calming Solutions marijuana shop at 6020 Ramsey St.
The brothers burst into the outlet, and the security guard, identified in documents only as "J.S.," immediately identified Richard Matus as a threat and physically engaged him.
The brief said another employee, Daniel Tellez, came to the guard's aid, and they managed to wrest a handgun away from Richard Matus, causing it to fall on the floor.
Prosecutors said Raymond Matus went to assist his older brother, stabbing Tellez in the left arm, prompting the man and the guard both to retreat to the rear of the outlet.
Another employee, Thomas Harris, also
"(Raymond Matus) stabbed Harris eight to 10 times in an attempt to assist his brother to get free," according to court papers.
"The defendant stabbed Harris even when his accomplice brother was back on his feet, and Harris was no longer struggling for the gun."
A patron of the marijuana shop, Rafat Ali, heard the commotion from the parking lot, armed himself with a baseball bat and went in to help the employees. When he encountered Richard Matus with the firearm, Ali headed for the exit. Prosecutors said that a shot was fired in the victim's direction, and he slipped, but wasn't struck by gunfire.
"Ali sustained a laceration to his chin because he fell, not because he was shot in the face," according to the defense's brief.
The brothers initially fled the shop without anything, but they returned moments later and grabbed "three jars of marijuana and a backpack" belonging to one of the employees, according to the prosecution.
Tellez and Harris suffered non-life-threatening stab wounds and were treated at San Gorgonio Memorial Medical Center, where Ali was also treated for the cut on his chin, court papers said.
Within two days of investigators circulating security surveillance photographs of the assailants via social media, numerous people contacted police, confirming the men's identities, according to documents. A week later, the pair were arrested without incident in San Diego.
Richard Matus had prior convictions for driving under the influence and being a habitual traffic offender. His younger brother had a juvenile conviction for robbery, court papers stated.
The Matus family filed a federal civil rights lawsuit in 2023 against the Riverside County Sheriff's Department in connection with the death of Richard Matus, who reportedly suffered a heart seizure after taking an unspecified quantity of fentanyl smuggled into his jail cell.
The plaintiffs allege staff were deficient in their response and pointed to wider, systemic problems caused by the sheriff, his administrators and the county, setting the stage for their loved one's loss.
By City News Service
Home prices in Riverside County rose slightly in February compared to the previous month, but they were still higher than housing prices one year ago, the California Association of Realtors announced Tuesday.
The $646,840 median price of an existing singlefamily home last month reflected a 0.3% increase from January's $645,000 sales price in the Riverside area. The February figure was a 3.5% increase from $624,900 one year ago, according to the report.
February's statewide median home price was $829,060, down 1.2% from January but up 2.8% from $806,480 in February 2024. Year-to-date statewide home sales edged up 2.6%, the survey said.
Also statewide, CAR noted, California's pending sales in February dipped from last year's level for the third consecutive month, but the drop was much smaller than the decline observed in January. The sales dip of homes in escrow could be due in part to a jump in mortgage rates at the beginning of February, but the public's growing concern of a recession may also have played a role in the slowdown in housing demand in recent weeks, the report said.
The February statewide median price increased on

a year-over-year basis for the 20th straight month, but the gain recorded was the smallest since July 2023, according to CAR.
On a month-to-month basis, the February median price dipped from the prior month, and the monthly drop was larger than the 10-year historical average dip of 0.7% recorded between the two months.
The downward trend in the statewide median price will likely reverse in the coming months, however, as home prices typically begin rising in March and continue climbing until the end of the homebuying season in August, according to the report.
"California home sales rebounded strongly in February after a sluggish
start to the year, supported by increased buyer activity and more available homes on the market," CAR President Heather Ozur said in a statement.
"Lower borrowing costs made homeownership more accessible to buyers who were previously sidelined by affordability challenges, while the rise in available inventory will help ease some of the competitive pressures that have defined the market in recent years and set a positive tone for the market for the rest of the year."
The median number of days it took to sell a California single-family home was 26 days in February, up from 22 days in February 2024.
The Board of SupervisorsTuesday authorized Riverside County Sheriff Chad Bianco to accept a $500,000 grant from the U.S. Drug Enforcement Administration in support of operations to eliminate illicit marijuana grows and carry out investigations that lead to criminal prosecutions.
The board without comment unanimously approved the Domestic Cannabis Eradication & Suppression grant award to the sheriff's department, retroactive to Oct. 1, 2024.
"This funding will allow the sheriff's office to eradicate and suppress the cultivation of illicit cannabis by gathering intelligence related to the illegal cultivation, possession and distribution of cannabis on private and
By City News Service
public lands," according to an agency statement posted to the board's agenda. "These efforts will improve the health and welfare of the residents and businesses of the county."
The sheriff's department seeks and generally receives multiple federal law enforcement grants annually.
The DEA funds must be expended by Sept. 30 for "overtime and operations expenses" incurred as a result of countywide efforts to crack down on illicit marijuana grows, documents stated.
Any sheriff's raid or seizure deployment in which the grant money is used must be documented.
Under the county's Marijuana Comprehensive Regulatory Framework of 2018, proposed outdoor and indoor commercial cannabis grows are required to undergo a stringent vetting process to qualify for licensing by the county and state.
The board has approved only a couple of commercial grows in the last six years.
The funding can be specifically applied to investigations that lead to arrests and prosecutions and the disposal of unauthorized grows. Officials said that a key part of the program is collecting cannabis samples and submitting them to the National Institute on Drug Abuse Potency Monitoring Project to determine what types of plants and their conditions which are commonly cultivated for grows within the county.


filed with the County Clerk of Los Angeles on February 14, 2025.
NOTICE: This fictitious business name statement expires five years from the date it was filed in the office of the County Clerk. A new fictitious business name statement must be filed prior to that date. The filing of this statement does not of itself authorize the use in this state of a fictitious business name in violation of the rights of another under federal, state or common law (See Section 14400 et seq., Business and Professional Code).
Pub. Monrovia Weekly 02/27/2025, 03/06/2025, 03/13/2025, 03/20/2025
FICTITIOUS BUSINESS NAME STATEMENT FILE NO. 2025009171 NEW FILING.
The following person(s) is (are) doing business as (1). Notion Link (2). Notion Link Strategies (3). NotionLink , 7119 West Sunset Boulevard No. 195, Los Angeles, CA 90046. This business is conducted by a limited liability company (llc). Registrant has not yet begun to transact business under the fictitious business name or names listed herein. Signed: RDJ Strategic Advisors, LLC (CA-3851823, 7119 West Sunset Boulevard No. 195, Los Angeles, CA 90046; Richard Jacobs, President. The statement was filed with the County Clerk of Los Angeles on January 15, 2025.
NOTICE: This fictitious business name statement expires five years from the date it was filed in the office of the County Clerk. A new fictitious business name statement must be filed prior to that date. The filing of this statement does not of itself authorize the use in this state of a fictitious business name in violation of the rights of another under federal, state or common law (See Section 14400 et seq., Business and Professional Code). Pub. Monrovia Weekly 02/27/2025, 03/06/2025, 03/13/2025, 03/20/2025
FICTITIOUS BUSINESS NAME STATEMENT FILE NO. 2025036383 NEW FILING.
The following person(s) is (are) doing business as (1). Cocoa and Cream (2). Cocoa + Cream (3). Cocoa and Cream LA (4). Cocoa +Cream LA , 10139 Riverside Drive, Toluca Lake, CA 91602. This business is conducted by a copartners. Registrant commenced to transact business under the fictitious business name or names listed herein on February 2025.
Signed: (1). Nicholas Grutzeck, 10139 Riverside Drive, Toluca Lake, CA 91602 (2). Tianna Hope, 10139 Riverside Drive, Toluca Lake, CA 91602 (3). Spencer Hope, 10139 Riverside Drive, Toluca Lake, CA 91602 (General Partner). The statement was filed with the County Clerk of Los Angeles on February 21, 2025. NOTICE: This fictitious business name statement expires five years from the date it was filed in the office of the County Clerk. A new fictitious business name statement must be filed prior to that date. The filing of this statement does not of itself authorize the use in this state of a fictitious business name in violation of the rights of another under federal, state or common law (See Section 14400 et seq., Business and Professional Code). Pub. Monrovia Weekly 02/27/2025, 03/06/2025, 03/13/2025, 03/20/2025
FICTITIOUS BUSINESS NAME STATEMENT FILE NO. 2025035775 NEW FILING.
The following person(s) is (are) doing business as Titan E-Lending, 407 N Maple Dr Suite GRD 1, Beverly Hills, CA 90210. This business is conducted by a limited liability company (llc). Registrant has not yet begun to transact business under the fictitious business name or names listed herein. Signed: Titan Financial Solutions LLC (CA-202464417794, 407 N Maple Dr Suite GRD 1, Beverly Hills, CA 90210; Vincent Wang, Manager. The statement was filed with the County Clerk of Los Angeles on February 20, 2025. NOTICE: This fictitious business name statement expires five years from the date it was filed in the office of the County Clerk. A new fictitious business name statement must be filed prior to that date. The filing of this statement does not of itself authorize the use in this state of a fictitious business name in violation of the rights of another under federal, state or common law (See Section 14400 et seq., Business and Professional Code). Pub. Monrovia Weekly 02/27/2025, 03/06/2025, 03/13/2025, 03/20/2025 FICTITIOUS BUSINESS NAME STATEMENT FILE NO. 2025036482
NEW FILING. The following person(s) is (are) doing business as NARRATAIVE, 10926 Bluffside Dr unit 35, Studio City, CA 91604. This business is conducted by a limited liability company (llc). Registrant has not yet begun to transact business under the fictitious business name or names listed herein. Signed: FINCON CONSULTING LC (CA-202464317870, 10926 Bluffside Dr unit 35, Studio City, CA 91604; Connor Meechan, CEO. The statement was filed with the County Clerk of Los Angeles on February 21, 2025. NOTICE: This fictitious business name statement expires five years from the date it was filed in the office of the County Clerk. A new fictitious business name statement must be filed prior to that date. The filing of this statement does not of itself authorize the use in this state of a fictitious business name in violation of the rights of another under federal, state or common law (See Section 14400 et seq., Business and Professional Code). Pub. Monrovia Weekly 02/27/2025, 03/06/2025, 03/13/2025, 03/20/2025
FICTITIOUS BUSINESS NAME STATEMENT FILE NO. 2025035945
NEW FILING.
The following person(s) is (are) doing business as Moncha Cafe, 8547 Valley Blvd Unit B, Rosemead, CA 91770. This business is conducted by a corporation. Registrant has not yet begun to transact business under the fictitious business name or names listed herein. Signed: 626 Car Tea Inc (CA-4062869, 10136 Fern St, South El Monte, Ca 91733; Khesayc Chu Yang, CEO. The statement was filed with the County Clerk of Los Angeles on February 21, 2025. NOTICE: This fictitious business name statement expires five years from the date it was filed in the office of the County Clerk. A new fictitious business name statement must be filed prior to that date. The filing of this statement does not of itself authorize the use in this state of a fictitious business name in violation of the rights of another under federal, state or common law (See Section 14400 et seq., Business and Professional Code). Pub. Monrovia Weekly 02/27/2025, 03/06/2025, 03/13/2025, 03/20/2025
FICTITIOUS BUSINESS NAME STATEMENT FILE NO. 2025035982 NEW FILING.
The following person(s) is (are) doing business as One Stop Shop Tires and Services, 13860 Ramona Blvd Apt 8, Baldwin Park, CA 91706. This business is conducted by a individual. Registrant has not yet begun to transact business under the fictitious business name or names listed herein. Signed: Carlos Zizo, 13860 Ramona Blvd Apt 8, Baldwin Park, CA 91706 (Owner). The statement was filed with the County Clerk of Los Angeles on February 21, 2025. NOTICE: This fictitious business name statement expires five years from the date it was filed in the office of the County Clerk. A new fictitious business name statement must be filed prior to that date. The filing of this statement does not of itself authorize the use in this state of a fictitious business name in violation of the rights of another under federal, state or common law (See Section 14400 et seq., Business and Professional Code). Pub. Monrovia Weekly 02/27/2025, 03/06/2025, 03/13/2025, 03/20/2025
FICTITIOUS BUSINESS NAME STATEMENT FILE NO. 2025 036190 FIRST FILING. The following person(s) is (are) doing business as Mira Vista Apartments BLI, 2314-2318 3/4 Mira Vista Ave., Montrose, CA 91020. Mailing Address, 1708 Fletcher Ave., South Pasadena, CA 91030. This business is conducted by a limited liability company (llc). Registrant commenced to transact business under the fictitious business name or names listed herein on December 2004. Signed: R & L APARTMENTS, LLC (CA-200435710064, 1708 Fletcher Ave, South Pasadena, CA 91030; Deborah Lutz, member. The statement was filed with the County Clerk of Los Angeles on February 21, 2025. NOTICE: This fictitious business name statement expires five years from the date it was filed in the office of the County Clerk. A new fictitious business name statement must be filed prior to that date. The filing of this statement does not of itself authorize the use in this state of a fictitious business name in violation of the rights of another under federal, state or common law (See Section 14400 et seq., Business and Professional Code).
Pub. Monrovia Weekly 02/27/2025, 03/06/2025, 03/13/2025, 03/20/2025
FICTITIOUS BUSINESS NAME STATEMENT FILE NO. 2025 036325 FIRST FILING. The following person(s) is (are) doing business as (1). La Brea Collective (2). Dr. Greenthumb’s Mid City , 5057 W Pico Blvd, Los Angeles, CA 90019. This business is conducted by a limited liability company (llc). Registrant commenced to transact business under the fictitious business name or names listed herein on January 2024. Signed: Peace and Joy LLC (CA-202252316348, 4807 Glenalbyn Dr, Los Angeles, CA 90065; Daniel Sosa, Manager. The statement was filed with the County Clerk of Los Angeles on February 21, 2025. NOTICE: This fictitious business name statement expires five years from the date it was filed in the office of the County Clerk. A new fictitious business name statement must be filed prior to that date. The filing of this statement does not of itself authorize the use in this state of a fictitious business name in violation of the rights of another under federal, state or common law (See Section 14400 et seq., Business and Professional Code). Pub. Monrovia Weekly 02/27/2025, 03/06/2025, 03/13/2025, 03/20/2025
FICTITIOUS BUSINESS NAME STATEMENT FILE NO. 2025038027 NEW FILING.
The following person(s) is (are) doing business as Imperial Health ADHC, 1175 N Lake Ave, Pasadena, CA 91104. This business is conducted by a limited liability company (llc). Registrant commenced to transact business under the fictitious business name or names listed herein on February 2025. Signed: AA Brothers, LLC (CA-201731210312, 1175 N Lake Ave, Pasadena, CA 91104; Armenak Ter-Petrosyan, CEO. The statement was filed with the County Clerk of Los Angeles on February 24, 2025. NOTICE: This fictitious business name statement expires five years from the date it was filed in the office of the County Clerk. A new fictitious business name statement must be filed prior to that date. The filing of this statement does not of itself authorize the use in this state of a fictitious business name in violation of the rights of another under federal, state or common law (See Section 14400 et seq., Business and Professional Code). Pub. Monrovia Weekly 02/27/2025, 03/06/2025, 03/13/2025, 03/20/2025
FICTITIOUS BUSINESS NAME STATEMENT FILE NO. 2025037985 NEW FILING.
The following person(s) is (are) doing business as Responsive Real Estate, 855 N Lark Ellen Ave Suite H, West Covina, CA 91791. This business is conducted by a corporation. Registrant has not yet begun to transact business under the fictitious business name or names listed herein. Signed: BOS Commercial, Inc. (CA-3278978, 855 N Lark Ellen Ave Suite H, West Covina, CA 91791; Frank Rizzi, president. The statement was filed with the County Clerk of Los Angeles on February 24, 2025. NOTICE: This fictitious business name statement expires five years from the date it was filed in the office of the County Clerk. A new fictitious business name statement must be filed prior to that date. The filing of this statement does not of itself authorize the use in this state of a fictitious business name in violation of the rights of another under federal, state or common law (See Section 14400 et seq., Business and Professional Code). Pub. Monrovia Weekly 02/27/2025, 03/06/2025, 03/13/2025, 03/20/2025
FICTITIOUS BUSINESS NAME STATEMENT FILE NO. 2025038375 NEW FILING. The following person(s) is (are) doing business as (1). Rancho La Seda Mobile Home Community (2). Walnut Hills Mobile Home Community , 650 La Seda Rd, 3745 Valley Blvd, La Puente, CA 91744. This business is conducted by a trust. Registrant has not yet begun to transact business under the fictitious business name or names listed herein. Signed: (1). Mark Telesz, 1601 N Sepulveda Blvd #629, Manhattan Beach, Ca 90266 (2). Joseph Sherman Administrative Trust, 650 La Seda Rd, 1601 N Sepulveda Blvd #629, Manhattan Beach, Ca 90266 (Trustee). The statement was filed with the County Clerk of Los Angeles on February 24, 2025. NOTICE: This fictitious business name statement expires five years from the date it was filed in the office of the County Clerk. A new
fictitious business name statement must be filed prior to that date. The filing of this statement does not of itself authorize the use in this state of a fictitious business name in violation of the rights of another under federal, state or common law (See Section 14400 et seq., Business and Professional Code). Pub. Monrovia Weekly 02/27/2025, 03/06/2025, 03/13/2025, 03/20/2025
FICTITIOUS BUSINESS NAME STATEMENT FILE NO. 2025021574 NEW FILING.
The following person(s) is (are) doing business as Deep Steam Carpet Cleaning, 18046 Annes Circle Unit 205, Canyon Country, CA 91387. This business is conducted by a individual. Registrant has not yet begun to transact business under the fictitious business name or names listed herein. Signed: Murvyn John Cato, 18046 Annes Circle Unit 205, Canyon Country, CA 91387 (Owner). The statement was filed with the County Clerk of Los Angeles on February 3, 2025. NOTICE: This fictitious business name statement expires five years from the date it was filed in the office of the County Clerk. A new fictitious business name statement must be filed prior to that date. The filing of this statement does not of itself authorize the use in this state of a fictitious business name in violation of the rights of another under federal, state or common law (See Section 14400 et seq., Business and Professional Code).
Pub. Monrovia Weekly 02/27/2025, 03/06/2025, 03/13/2025, 03/20/2025
FICTITIOUS BUSINESS NAME STATEMENT FILE NO. 2025021272 NEW FILING. The following person(s) is (are) doing business as (1). Ground Zero Flooring (2). Ground Zero Contractors , 212 N. Catalina Ave Unit C, Redondo Beach, CA 90277. This business is conducted by a limited liability company (llc). Registrant has not yet begun to transact business under the fictitious business name or names listed herein. Signed: Ground Zero Flooring Contractors, LLC (CA202565511802, 212 N. Catalina Ave Unit C, Redondo Beach, CA 90277; Cinthia Chavez Guzman, CEO. The statement was filed with the County Clerk of Los Angeles on January 31, 2025. NOTICE: This fictitious business name statement expires five years from the date it was filed in the office of the County Clerk. A new fictitious business name statement must be filed prior to that date. The filing of this statement does not of itself authorize the use in this state of a fictitious business name in violation of the rights of another under federal, state or common law (See Section 14400 et seq., Business and Professional Code).
Pub. Monrovia Weekly 02/27/2025, 03/06/2025, 03/13/2025, 03/20/2025
FICTITIOUS BUSINESS NAME STATEMENT FILE NO. 2025028678
NEW FILING.
The following person(s) is (are) doing business as Cosmic Links, 768 N Glendora Ave, COVINA, CA 91724. This business is conducted by a individual. Registrant commenced to transact business under the fictitious business name or names listed herein on February 2025. Signed: Gabriela Duran, 768 N Glendora Ave, COVINA, CA 91724 (Owner). The statement was filed with the County Clerk of Los Angeles on February 12, 2025. NOTICE: This fictitious business name statement expires five years from the date it was filed in the office of the County Clerk. A new fictitious business name statement must be filed prior to that date. The filing of this statement does not of itself authorize the use in this state of a fictitious business name in violation of the rights of another under federal, state or common law (See Section 14400 et seq., Business and Professional Code).
Pub. Monrovia Weekly 02/27/2025, 03/06/2025, 03/13/2025, 03/20/2025
FICTITIOUS BUSINESS NAME STATEMENT FILE NO. 2025037174
NEW FILING.
The following person(s) is (are) doing business as Hard Pressed Graphics, 177 N Hudson Avenue Unit E313, Pasadena, CA 91101. This business is conducted by a general partnership. Registrant commenced to transact business under the fictitious business name or names listed herein on February 2025. Signed: (1). Rajaee Jackson, 177 N Hudson Avenue Unit E313, Pasadena, CA 91101 (2). Rasheeda Dove, 177 N Hudson Avenue Unit E313, Pasadena,
CA 91101 (General Partner). The statement was filed with the County Clerk of Los Angeles on February 24, 2025. NOTICE: This fictitious business name statement expires five years from the date it was filed in the office of the County Clerk. A new fictitious business name statement must be filed prior to that date. The filing of this statement does not of itself authorize the use in this state5 of a fictitious business name in violation of the rights of another under federal, state or common law (See Section 14400 et seq., Business and Professional Code).
Pub. Monrovia Weekly 02/27/2025, 03/06/2025, 03/13/2025, 03/20/2025
FICTITIOUS BUSINESS NAME STATEMENT FILE NO. 2025027145 NEW FILING.
The following person(s) is (are) doing business as Academy Salon and Barber, 27 N. Catalina Ave., Pasadena, CA 91106. This business is conducted by a individual. Registrant commenced to transact business under the fictitious business name or names listed herein on March 2015.
Signed: Inez Mira, 27 N. Catalina Ave., Pasadena, CA 91106 (Owner). The statement was filed with the County Clerk of Los Angeles on February 10, 2025. NOTICE: This fictitious business name statement expires five years from the date it was filed in the office of the County Clerk. A new fictitious business name statement must be filed prior to that date. The filing of this statement does not of itself authorize the use in this state of a fictitious business name in violation of the rights of another under federal, state or common law (See Section 14400 et seq., Business and Professional Code).
Pub. Monrovia Weekly 02/27/2025, 03/06/2025, 03/13/2025, 03/20/2025
FICTITIOUS BUSINESS NAME STATEMENT FILE NO. 2025038301
NEW FILING. The following person(s) is (are) doing business as Monemus Construction Management Advisors, 9531 S Santa Monica Blvd #410, Beverly Hills, CA 90210. This business is conducted by a corporation. Registrant commenced to transact business under the fictitious business name or names listed herein on February 2025. Signed: AGKC Associates Inc (CA-6586435, 9531 S Santa Monica Blvd #410, Beverly Hills, CA 90210; Armando Granillo, CEO. The statement was filed with the County Clerk of Los Angeles on February 24, 2025. NOTICE: This fictitious business name statement expires five years from the date it was filed in the office of the County Clerk. A new fictitious business name statement must be filed prior to that date. The filing of this statement does not of itself authorize the use in this state of a fictitious business name in violation of the rights of another under federal, state or common law (See Section 14400 et seq., Business and Professional Code).
Pub. Monrovia Weekly 02/27/2025, 03/06/2025, 03/13/2025, 03/20/2025
FICTITIOUS BUSINESS NAME STATEMENT FILE NO. 2025033208 NEW FILING. The following person(s) is (are) doing business as THE BESIDE YOU COMPANY, 1304 S Briargate Ln, Glendora, CA 91740. This business is conducted by a limited liability company (llc). Registrant commenced to transact business under the fictitious business name or names listed herein on February 2025. Signed: F & R GROUP LLC (CA-202206410450, 1304 S Briargate Ln, Glendora, CA 91740; ALEXIS RAMOS ROMERO, PRESIDENT. The statement was filed with the County Clerk of Los Angeles on February 18, 2025.
NOTICE: This fictitious business name statement expires five years from the date it was filed in the office of the County Clerk. A new fictitious business name statement must be filed prior to that date. The filing of this statement does not of itself authorize the use in this state of a fictitious business name in violation of the rights of another under federal, state or common law (See Section 14400 et seq., Business and Professional Code).
Pub. Monrovia Weekly 02/27/2025, 03/06/2025, 03/13/2025, 03/20/2025
FICTITIOUS BUSINESS NAME STATEMENT FILE NO. 2025038869 NEW FILING. The following person(s) is (are) doing business as Modern Property Management, 6320 Canoga Ave. 15th floor, Woodland Hills, CA 91367. This business is conducted by a corporation. Registrant has not yet begun to transact business
under the fictitious business name or names listed herein. Signed: Conbrad Corp (CA-3559392, 10551 Melvin Ave, Northridge, Ca 91326; Suheil cerino, CEO. The statement was filed with the County Clerk of Los Angeles on February 25, 2025.
NOTICE: This fictitious business name statement expires five years from the date it was filed in the office of the County Clerk. A new fictitious business name statement must be filed prior to that date. The filing of this statement does not of itself authorize the use in this state of a fictitious business name in violation of the rights of another under federal, state or common law (See Section 14400 et seq., Business and Professional Code). Pub. Monrovia Weekly 02/27/2025, 03/06/2025, 03/13/2025, 03/20/2025 FICTITIOUS BUSINESS NAME STATEMENT FILE NO. 2925033304 NEW FILING. The following person(s) is (are) doing business as A & M Upholstery, 2711 Merced Ave, El Monte, CA 91733. This business is conducted by a corporation. Registrant commenced to transact business under the fictitious business name or names listed herein on February 2025. Signed: A & M Upholstery Inc (CA-6235778, 2711 Merced Ave, El Monte, CA 91733; Ana Martinez, President. The statement was filed with the County Clerk of Los Angeles on February 18, 2025. NOTICE: This fictitious business name statement expires five years from the date it was filed in the office of the County Clerk. A new fictitious business name statement must be filed prior to that date. The filing of this statement does not of itself authorize the use in this state of a fictitious business name in violation of the rights of another under federal, state or common law (See Section 14400 et seq., Business and Professional Code). Pub. Monrovia Weekly 02/27/2025, 03/06/2025, 03/13/2025, 03/20/2025 FICTITIOUS BUSINESS NAME STATEMENT FILE NO. 2025039052 NEW FILING. The following person(s) is (are) doing business as (1). # 1 Dumpling (2). Long Xing Ji , 1628 Puente Ave, Baldwin Park, CA 91706. This business is conducted by a corporation. Registrant commenced to transact business under the fictitious business name or names listed herein on February 2025. Signed: Qin Huai Nutrition, Inc (CA-6109820, 1628 Puente Ave, Baldwin Park, CA 91706; Jessica Chen, President. The statement was filed with the County Clerk of Los Angeles on February 25, 2025. NOTICE: This fictitious business name statement expires five years from the date it was filed in the office of the County Clerk. A new fictitious business name statement must be filed prior to that date. The filing of this statement does not of itself authorize the use in this state of a fictitious business name in violation of the rights of another under federal, state or common law (See Section 14400 et seq., Business and Professional Code). Pub. Monrovia Weekly 02/27/2025, 03/06/2025, 03/13/2025, 03/20/2025
FICTITIOUS BUSINESS NAME STATEMENT FILE NO. 2025038918 NEW FILING. The following person(s) is (are) doing business as Fabric Tiger, 288 E LIVE OAK AVE TE 177, ARCADIA, CA 91006. This business is conducted by a corporation. Registrant commenced to transact business under the fictitious business name or names listed herein on February 2025. Signed: WOOD WOOD INC (CA-4789845, 288 E LIVE OAK AVE TE 177, ARCADIA, CA 91006; PO WA FUNG, PRESIDENT. The statement was filed with the County Clerk of Los Angeles on February 25, 2025. NOTICE: This fictitious business name statement expires five years from the date it was filed in the office of the County Clerk. A new fictitious business name statement must be filed prior to that date. The filing of this statement does not of itself authorize the use in this state of a fictitious business name in violation of the rights of another under federal, state or common law (See Section 14400 et seq., Business and Professional Code). Pub. Monrovia Weekly 02/27/2025, 03/06/2025, 03/13/2025, 03/20/2025
FICTITIOUS BUSINESS NAME STATEMENT FILE NO. 2025038968 NEW FILING. The following person(s) is (are) doing business as AA24, 288 E LIVE OAK AVE STE 177, ARCADIA, CA 91006. This business is conducted by a corporation. Registrant commenced to transact business under the fictitious
business name or names listed herein on February 2025. Signed: WOOD WOOD INC (CA-4789845, 288 E LIVE OAK AVE STE 177, ARCADIA, CA 91006; PO WU FUNG, PRESIDENT. The statement was filed with the County Clerk of Los Angeles on February 25, 2025.
NOTICE: This fictitious business name statement expires five years from the date it was filed in the office of the County Clerk. A new fictitious business name statement must be filed prior to that date. The filing of this statement does not of itself authorize the use in this state of a fictitious business name in violation of the rights of another under federal, state or common law (See Section 14400 et seq., Business and Professional Code).
Pub. Monrovia Weekly 02/27/2025, 03/06/2025, 03/13/2025, 03/20/2025
FICTITIOUS BUSINESS NAME STATEMENT FILE NO. 2025038466 NEW FILING.
The following person(s) is (are) doing business as Take N Taste, 916 W Burbank Blvd Unit C, Burbank, CA 91506. This business is conducted by a individual. Registrant commenced to transact business under the fictitious business name or names listed herein on February 2025. Signed: James Schroeder, 916 W Burbank Blvd Unit C, Burbank, CA 91506 (Owner). The statement was filed with the County Clerk of Los Angeles on February 25, 2025.
NOTICE: This fictitious business name statement expires five years from the date it was filed in the office of the County Clerk. A new fictitious business name statement must be filed prior to that date. The filing of this statement does not of itself authorize the use in this state of a fictitious business name in violation of the rights of another under federal, state or common law (See Section 14400 et seq., Business and Professional Code).
Pub. Monrovia Weekly 03/06/2025, 03/13/2025, 03/20/2025, 03/27/2025
FICTITIOUS BUSINESS NAME STATEMENT FILE NO. 2025032598 NEW FILING.
The following person(s) is (are) doing business as (1). Lili Candle Co (2). Lilis Candle Co , 627 E Cedar Ave Apt B, Burbank, CA 91501. This business is conducted by a individual. Registrant commenced to transact business under the fictitious business name or names listed herein on February 2025. Signed: William Levi Corcio, 627 E Cedar Ave Apt B, Burbank, CA 91501 (Owner). The statement was filed with the County Clerk of Los Angeles on February 18, 2025. NOTICE: This fictitious business name statement expires five years from the date it was filed in the office of the County Clerk. A new fictitious business name statement must be filed prior to that date. The filing of this statement does not of itself authorize the use in this state of a fictitious business name in violation of the rights of another under federal, state or common law (See Section 14400 et seq., Business and Professional Code). Pub. Monrovia Weekly 03/06/2025, 03/13/2025, 03/20/2025, 03/27/2025
FICTITIOUS BUSINESS NAME STATEMENT FILE NO. 2025039165 NEW FILING.
The following person(s) is (are) doing business as I LOVE ACAI, 12947 HAWTHORNE BLVD, HAWTHORNE CA, CA 902507011. This business is conducted by a corporation. Registrant commenced to transact business under the fictitious business name or names listed herein on February 2025. Signed: I LOVE ACAI (CA-6283383, 7009 Larkvale Dr, Rancho Pls Vrds, Ca 90275; KSENIIA HLADKA, CEO. The statement was filed with the County Clerk of Los Angeles on February 25, 2025. NOTICE: This fictitious business name statement expires five years from the date it was filed in the office of the County Clerk. A new fictitious business name statement must be filed prior to that date. The filing of this statement does not of itself authorize the use in this state of a fictitious business name in violation of the rights of another under federal, state or common law (See Section 14400 et seq., Business and Professional Code). Pub. Monrovia Weekly 03/06/2025, 03/13/2025, 03/20/2025, 03/27/2025
FICTITIOUS BUSINESS NAME STATEMENT FILE NO. 2025036450 NEW FILING.
The following person(s) is (are) doing business as Mendoza Trucking Service, 117 Montana
St, Monrovia, CA 91016. This business is conducted by a copartners. Registrant has not yet begun to transact business under the fictitious business name or names listed herein. Signed: (1). Jose Rolando Mendoza, 117 Montana St, Monrovia, CA 91016 (2). Omar Enrique Mendoza, 117 Montana St, Monrovia, CA 91016 (General Partner). The statement was filed with the County Clerk of Los Angeles on February 21, 2025. NOTICE: This fictitious business name statement expires five years from the date it was filed in the office of the County Clerk. A new fictitious business name statement must be filed prior to that date. The filing of this statement does not of itself authorize the use in this state of a fictitious business name in violation of the rights of another under federal, state or common law (See Section 14400 et seq., Business and Professional Code).
Pub. Monrovia Weekly 03/06/2025, 03/13/2025, 03/20/2025, 03/27/2025
FICTITIOUS BUSINESS NAME STATEMENT FILE NO. 2025041502 NEW FILING.
The following person(s) is (are) doing business as Novitas Consulting, 19425 Soledad Canyon Road #132, Canyon County, CA 91351. This business is conducted by a limited liability company (llc). Registrant commenced to transact business under the fictitious business name or names listed herein on February 2025. Signed: Novitas Marketing LLC (CA-200636210213, 19425 Soledad Canyon Road #132, Canyon County, CA 91351; Emil Karapetyan, Member. The statement was filed with the County Clerk of Los Angeles on February 27, 2025. NOTICE: This fictitious business name statement expires five years from the date it was filed in the office of the County Clerk. A new fictitious business name statement must be filed prior to that date. The filing of this statement does not of itself authorize the use in this state of a fictitious business name in violation of the rights of another under federal, state or common law (See Section 14400 et seq., Business and Professional Code).
Pub. Monrovia Weekly 03/06/2025, 03/13/2025, 03/20/2025, 03/27/2025
FICTITIOUS BUSINESS NAME STATEMENT FILE NO. 2025033895 NEW FILING.
The following person(s) is (are) doing business as AG Design Co, 5807 Topanga Canyon Blvd K306, Woodland hills, CA 91367. This business is conducted by a individual. Registrant commenced to transact business under the fictitious business name or names listed herein on February 2025. Signed: Alin Chrnamorts, 5807 Topanga Canyon Blvd K306, Woodland hills, CA 91367 (Owner). The statement was filed with the County Clerk of Los Angeles on February 19, 2025. NOTICE: This fictitious business name statement expires five years from the date it was filed in the office of the County Clerk. A new fictitious business name statement must be filed prior to that date. The filing of this statement does not of itself authorize the use in this state of a fictitious business name in violation of the rights of another under federal, state or common law (See Section 14400 et seq., Business and Professional Code). Pub. Monrovia Weekly 03/06/2025, 03/13/2025, 03/20/2025, 03/27/2025
FICTITIOUS BUSINESS NAME STATEMENT FILE NO. 2025041582 NEW FILING. The following person(s) is (are) doing business as Beyond the Path, 21420 Laker Ct, Chatsworth, CA 91311. This business is conducted by a individual. Registrant has not yet begun to transact business under the fictitious business name or names listed herein. Signed: Sophia Borkgren, 21420 Laker Ct, Chatsworth, CA 91311 (Owner). The statement was filed with the County Clerk of Los Angeles on February 28, 2025. NOTICE: This fictitious business name statement expires five years from the date it was filed in the office of the County Clerk. A new fictitious business name statement must be filed prior to that date. The filing of this statement does not of itself authorize the use in this state of a fictitious business name in violation of the rights of another under federal, state or common law (See Section 14400 et seq., Business and Professional Code). Pub. Monrovia Weekly 03/06/2025, 03/13/2025, 03/20/2025, 03/27/2025
FICTITIOUS BUSINESS NAME STATEMENT FILE NO. 2025030960 NEW FILING.
The following person(s) is (are) doing business as (1). Manu
Marra (2). Undercover Butler (3). Amaris , 23679 Calabasas Rd Suite 1080, Calabasas, CA 91302. This business is conducted by a limited liability company (llc). Registrant commenced to transact business under the fictitious business name or names listed herein on February 2025. Signed: INKTI LLC (CA202565517075, 23679 Calabasas Rd Suite 1080, Calabasas, CA 91302; Dol-Anne Asiru, CEO. The statement was filed with the County Clerk of Los Angeles on February 13, 2025. NOTICE: This fictitious business name statement expires five years from the date it was filed in the office of the County Clerk. A new fictitious business name statement must be filed prior to that date. The filing of this statement does not of itself authorize the use in this state of a fictitious business name in violation of the rights of another under federal, state or common law (See Section 14400 et seq., Business and Professional Code). Pub. Monrovia Weekly 03/06/2025, 03/13/2025, 03/20/2025, 03/27/2025
FICTITIOUS BUSINESS NAME STATEMENT FILE NO. 2025037380 NEW FILING.
The following person(s) is (are) doing business as Blue Bass Publishing, 1208 St Charles Ter, Alhambra, CA 91801. This business is conducted by a married couple. Registrant commenced to transact business under the fictitious business name or names listed herein on February 2025. Signed: (1). Jay Simper, 1208 St Charles Ter, Alhambra, CA 91801 (2). Danielle Simper, 1208 St Charles Ter, Alhambra, CA 91801 (Owner). The statement was filed with the County Clerk of Los Angeles on February 24, 2025. NOTICE:
This fictitious business name statement expires five years from the date it was filed in the office of the County Clerk. A new fictitious business name statement must be filed prior to that date. The filing of this statement does not of itself authorize the use in this state of a fictitious business name in violation of the rights of another under federal, state or common law (See Section 14400 et seq., Business and Professional Code).
Pub. Monrovia Weekly 03/06/2025, 03/13/2025, 03/20/2025, 03/27/2025
FICTITIOUS BUSINESS NAME STATEMENT FILE NO. 2025037877
NEW FILING.
The following person(s) is (are) doing business as AllTech Co, 617 N Orange Dr #205, Los Angeles, CA 90036. This business is conducted by a individual. Registrant commenced to transact business under the fictitious business name or names listed herein on March 2025. Signed: Rafael Azari, 617 N Orange Dr 205 205, Los Angeles, CA 90036 (Owner). The statement was filed with the County Clerk of Los Angeles on February 24, 2025.
NOTICE: This fictitious business name statement expires five years from the date it was filed in the office of the County Clerk. A new fictitious business name statement must be filed prior to that date. The filing of this statement does not of itself authorize the use in this state of a fictitious business name in violation of the rights of another under federal, state or common law (See Section 14400 et seq., Business and Professional Code).
Pub. Monrovia Weekly 03/06/2025, 03/13/2025, 03/20/2025, 03/27/2025
FICTITIOUS BUSINESS NAME STATEMENT FILE NO. 2025044209 NEW FILING.
The following person(s) is (are) doing business as Monrovia floral, 119 E Olive Ave, Monrovia, CA 91016. This business is conducted by a individual. Registrant has not yet begun to transact business under the fictitious business name or names listed herein. Signed: Lori Garcia, 119 E Olive Ave, Monrovia, CA 91016 (Owner). The statement was filed with the County Clerk of Los Angeles on March 4, 2025. NOTICE: This fictitious business name statement expires five years from the date it was filed in the office of the County Clerk. A new fictitious business name statement must be filed prior to that date. The filing of this statement does not of itself authorize the use in this state of a fictitious business name in violation of the rights of another under federal, state or common law (See Section 14400 et seq., Business and Professional Code). Pub. Monrovia Weekly 03/06/2025, 03/13/2025, 03/20/2025, 03/27/2025
FICTITIOUS BUSINESS NAME STATEMENT FILE NO. 2025044012 NEW FILING.
The following person(s) is (are) doing business as A&A GRANITE MARBLE, 8629 Bradley Ave, Sun
Valley, CA 91352. This business is conducted by a corporation. Registrant commenced to transact business under the fictitious business name or names listed herein on January 2003. Signed: MURADYAN ENTERPRISES INC (CA-2513166, 8629 Bradley Ave, Sun Valley, CA 91352; ARA MURADYAN, CEO. The statement was filed with the County Clerk of Los Angeles on March 4, 2025. NOTICE: This fictitious business name statement expires five years from the date it was filed in the office of the County Clerk. A new fictitious business name statement must be filed prior to that date. The filing of this statement does not of itself authorize the use in this state of a fictitious business name in violation of the rights of another under federal, state or common law (See Section 14400 et seq., Business and Professional Code).
Pub. Monrovia Weekly 03/06/2025, 03/13/2025, 03/20/2025, 03/27/2025
FICTITIOUS BUSINESS NAME STATEMENT FILE NO. 2025042651 NEW FILING.
The following person(s) is (are) doing business as Hans Weisshaar, 936 Huntington Drive Suite E, San Marino, CA 91108. This business is conducted by a corporation. Registrant commenced to transact business under the fictitious business name or names listed herein on June 2004. Signed: Weisshaar Musical Instruments, Inc. (CA-2613699, 936 Huntington Drive Suite E, San Marino, CA 91108; Georg Eittinger, CEO. The statement was filed with the County Clerk of Los Angeles on March 5, 2025. NOTICE: This fictitious business name statement expires five years from the date it was filed in the office of the County Clerk. A new fictitious business name statement must be filed prior to that date. The filing of this statement does not of itself authorize the use in this state of a fictitious business name in violation of the rights of another under federal, state or common law (See Section 14400 et seq., Business and Professional Code).
Pub. Monrovia Weekly 03/06/2025, 03/13/2025, 03/20/2025, 03/27/2025
FICTITIOUS BUSINESS NAME STATEMENT FILE NO. 2025024460 NEW FILING. The following person(s) is (are) doing business as (1). Brownhouse Minerals (2). Kings of Clubs Entertainment (3). Breakthrough Cardology (4). Breakthrough Advocacy Services , 2908 W El Segundo Blvd F, Gardena, CA 90249. This business is conducted by a limited liability company (llc). Registrant commenced to transact business under the fictitious business name or names listed herein on March 2025. Signed: BrownHouse LLC (CA-201907210320, 2908 W El Segundo Blvd F, Gardena, CA 90249; DWANN BROWN, Member. The statement was filed with the County Clerk of Los Angeles on February 6, 2025. NOTICE: This fictitious business name statement expires five years from the date it was filed in the office of the County Clerk. A new fictitious business name statement must be filed prior to that date. The filing of this statement does not of itself authorize the use in this state of a fictitious business name in violation of the rights of another under federal, state or common law (See Section 14400 et seq., Business and Professional Code).
Pub. Monrovia Weekly 03/06/2025, 03/13/2025, 03/20/2025, 03/27/2025
FICTITIOUS BUSINESS NAME STATEMENT FILE NO. 2025039379 NEW FILING.
The following person(s) is (are) doing business as Lay Up Tile & Stone, 11147 Sherman Way Unit 3, Sun Valley, CA 91352. This business is conducted by a individual. Registrant commenced to transact business under the fictitious business name or names listed herein on March 2025. Signed: Enrique Velazquez Banuelos, 11147 Sherman Way Unit 3, Sun Valley, CA 91352 (Owner). The statement was filed with the County Clerk of Los Angeles on February 25, 2025. NOTICE: This fictitious business name statement expires five years from the date it was filed in the office of the County Clerk. A new fictitious business name statement must be filed prior to that date. The filing of this statement does not of itself authorize the use in this state of a fictitious business name in violation of the rights of another under federal, state or common law (See Section 14400 et seq., Business and Professional Code).
Pub. Monrovia Weekly 03/06/2025, 03/13/2025, 03/20/2025, 03/27/2025
FICTITIOUS BUSINESS NAME STATEMENT FILE NO. 2025043477 NEW FILING. The following person(s) is (are) doing business as Day Ray Products, 746 Arrow Grand Circle, Covina, CA 91722. This business is conducted by a limited liability company (llc). Registrant commenced to transact business under the fictitious business name or names listed herein on March 2025. Signed: CEC VIBRATION PRODUCTS LLC (CA201706710061, 746 Arrow Grand Circle, Covina, CA 91722; Hilary Kingston, Manager. The statement was filed with the County Clerk of Los Angeles on March 3, 2025. NOTICE: This fictitious business name statement expires five years from the date it was filed in the office of the County Clerk. A new fictitious business name statement must be filed prior to that date. The filing of this statement does not of itself authorize the use in this state of a fictitious business name in violation of the rights of another under federal, state or common law (See Section 14400 et seq., Business and Professional Code).
Pub. Monrovia Weekly 03/06/2025, 03/13/2025, 03/20/2025, 03/27/2025
FICTITIOUS BUSINESS NAME STATEMENT FILE NO. 2025043468 NEW FILING.
The following person(s) is (are) doing business as Altadena Seed Library, 37 Auburn Ave #8, Sierra Madre, CA 91024. This business is conducted by a individual. Registrant commenced to transact business under the fictitious business name or names listed herein on January 2025. Signed: Nina Raj, 1946 Glen Avenue, Pasadena, Ca 91103 (Owner). The statement was filed with the County Clerk of Los Angeles on March 3, 2025. NOTICE: This fictitious business name statement expires five years from the date it was filed in the office of the County Clerk. A new fictitious business name statement must be filed prior to that date. The filing of this statement does not of itself authorize the use in this state of a fictitious business name in violation of the rights of another under federal, state or common law (See Section 14400 et seq., Business and Professional Code).
Pub. Monrovia Weekly 03/06/2025, 03/13/2025, 03/20/2025, 03/27/2025
FICTITIOUS BUSINESS NAME STATEMENT FILE NO. 2025043475
NEW FILING.
The following person(s) is (are) doing business as ADVANCED DAMAGE APPRAISERS, 7142 Asman Ave, West Hills, CA 91307. This business is conducted by a individual. Registrant commenced to transact business under the fictitious business name or names listed herein on March 2012. Signed: MICHAEL KVASHIS, 7142 Asman Ave, West Hills, CA 91307 (Owner). The statement was filed with the County Clerk of Los Angeles on March 3, 2025. NOTICE: This fictitious business name statement expires five years from the date it was filed in the office of the County Clerk. A new fictitious business name statement must be filed prior to that date. The filing of this statement does not of itself authorize the use in this state of a fictitious business name in violation of the rights of another under federal, state or common law (See Section 14400 et seq., Business and Professional Code).
Pub. Monrovia Weekly 03/06/2025, 03/13/2025, 03/20/2025, 03/27/2025
FICTITIOUS BUSINESS NAME STATEMENT FILE NO. 2025043351 NEW FILING.
The following person(s) is (are) doing business as Plum Bee Sewer & Drains, 18563 9th St, Bloomington, CA 92316. This business is conducted by a general partnership. Registrant has not yet begun to transact business under the fictitious business name or names listed herein. Signed: (1). Jose Rogel, 18563 9th St, Bloomington, CA 92316 (2). Jose Amilcar Palma, 9375 Fern St, South El Monte, Ca 91733 (General Partner). The statement was filed with the County Clerk of Los Angeles on March 3, 2025. NOTICE: This fictitious business name statement expires five years from the date it was filed in the office of the County Clerk. A new fictitious business name statement must be filed prior to that date. The filing of this statement does not of itself authorize the use in this state of a fictitious business name in violation of the rights of another under federal, state or common law (See Section 14400 et seq., Business and Professional Code). Pub. Monrovia Weekly 03/06/2025, 03/13/2025, 03/20/2025, 03/27/2025
FICTITIOUS BUSINESS NAME STATEMENT FILE NO. 2025042482 NEW FILING. The following person(s) is (are) doing business as EYE FOR EYE PRODUCTION, 300 W Valley Blvd 1706, Alhambra, CA 91803. This business is conducted by a individual. Registrant commenced to transact business under the fictitious business name or names listed herein on February 2025. Signed: Cherry Rong Zeng Ma, 300 W Valley Blvd 1706, Alhambra, CA 91803 (Owner). The statement was filed with the County Clerk of Los Angeles on February 28, 2025. NOTICE: This fictitious business name statement expires five years from the date it was filed in the office of the County Clerk. A new fictitious business name statement must be filed prior to that date. The filing of this statement does not of itself authorize the use in this state of a fictitious business name in violation of the rights of another under federal, state or common law (See Section 14400 et seq., Business and Professional Code). Pub. Monrovia Weekly 03/06/2025, 03/13/2025, 03/20/2025, 03/27/2025
FICTITIOUS BUSINESS NAME STATEMENT FILE NO. 2025043098 NEW FILING. The following person(s) is (are) doing business as Comfort nest remodeling, 582 W Stocker St 10, Glendale, CA 91202. This business is conducted by a individual. Registrant commenced to transact business under the fictitious business name or names listed herein on March 2025. Signed: Romik
FICTITIOUS BUSINESS NAME STATEMENT FILE NO. 2025038426 NEW FILING. The following person(s) is (are) doing business as Slice of Heaven, 11536 Ridgegate Dr, Whittier, CA 90601. This business is conducted by a individual. Registrant commenced to transact business under the fictitious business name or names listed herein on February 2025. Signed: Maya Gomez, 11536 Ridgegate Dr, Whittier, CA 90601 (Owner). The statement was filed with the County Clerk of Los Angeles on February 24, 2025. NOTICE: This fictitious business name statement expires five years from the date it was filed in the office of the County Clerk. A new fictitious business name statement must be filed prior to that date. The filing of this statement does not of itself authorize the use in this state of a fictitious business name in violation of the rights of another under federal, state or common law (See Section 14400 et seq., Business and Professional Code). Pub. Monrovia Weekly 03/06/2025, 03/13/2025, 03/20/2025, 03/27/2025
FICTITIOUS BUSINESS NAME STATEMENT FILE NO. 2025030144 NEW FILING. The following person(s) is (are) doing business as Pristine Building Services, 100 Horseshoe Circle, West Covina, CA 91791. This business is conducted by a individual. Registrant has not yet begun to transact business under the fictitious business name or names listed herein. Signed: Ashley Nicole Kerr, 100 Horseshoe Circle, West Covina, CA 91791 (Owner). The statement was filed with the County Clerk of Los Angeles on February 12, 2025. NOTICE: This fictitious business name statement expires five years from the date it was filed in the office of the County Clerk. A new fictitious business name statement must be filed prior to that date. The filing of this statement does not of itself authorize the use in this state of a fictitious business name in violation of the rights of another under federal, state or common law (See Section 14400 et seq., Business and Professional Code). Pub. Monrovia Weekly 03/06/2025, 03/13/2025, 03/20/2025, 03/27/2025
FICTITIOUS BUSINESS NAME STATEMENT FILE NO. 2025018236 NEW FILING. The following person(s) is (are)
doing business as The Songwriter Fund, 16027 Ventura Boulevard Suite 301, Encino, CA 91436. This business is conducted by a corporation. Registrant commenced to transact business under the fictitious business name or names listed herein on January 2025. Signed: The SONA Foundation (CA-4858466, 16027 Ventura Boulevard Suite 301, Encino, CA 91436; Mark Pariser, Treasurer. The statement was filed with the County Clerk of Los Angeles on January 28, 2025.
NOTICE: This fictitious business name statement expires five years from the date it was filed in the office of the County Clerk. A new fictitious business name statement must be filed prior to that date. The filing of this statement does not of itself authorize the use in this state of a fictitious business name in violation of the rights of another under federal, state or common law (See Section 14400 et seq., Business and Professional Code).
Pub. Monrovia Weekly 03/06/2025, 03/13/2025, 03/20/2025, 03/27/2025
FICTITIOUS BUSINESS NAME STATEMENT FILE NO. 2025041971 NEW FILING. The following person(s) is (are) doing business as TAURUS SECURITY PROCESS SERVICE, 2741 Via Paseo # 15, Montebello, CA 90640. This business is conducted by a individual. Registrant commenced to transact business under the fictitious business name or names listed herein on February 2025. Signed: MICHAEL ALDAPA, 2741 Via Paseo # 15, Montebello, CA 90640 (Owner). The statement was filed with the County Clerk of Los Angeles on February 28, 2025.
NOTICE: This fictitious business name statement expires five years from the date it was filed in the office of the County Clerk. A new fictitious business name statement must be filed prior to that date. The filing of this statement does not of itself authorize the use in this state of a fictitious business name in violation of the rights of another under federal, state or common law (See Section 14400 et seq., Business and Professional Code).
Pub. Monrovia Weekly 03/06/2025, 03/13/2025, 03/20/2025, 03/27/2025
FICTITIOUS BUSINESS NAME STATEMENT FILE NO. 2025037317 NEW FILING.
The following person(s) is (are) doing business as McCann Contracting, 1601 Walker Street First Floor, Cypress, CA 90630. This business is conducted by a individual. Registrant commenced to transact business under the fictitious business name or names listed herein on February 2025. Signed: Lisa Marie Gottis, 1601 Walker Street First Floor, Cypress, CA 90630 (Owner). The statement was filed with the County Clerk of Los Angeles on February 24, 2025. NOTICE: This fictitious business name statement expires five years from the date it was filed in the office of the County Clerk. A new fictitious business name statement must be filed prior to that date. The filing of this statement does not of itself authorize the use in this state of a fictitious business name in violation of the rights of another under federal, state or common law (See Section 14400 et seq., Business and Professional Code).
Pub. Monrovia Weekly 03/06/2025, 03/13/2025, 03/20/2025, 03/27/2025
FICTITIOUS BUSINESS NAME STATEMENT FILE NO. 2025044397 NEW FILING.
The following person(s) is (are) doing business as (1). Diamond Wish (2). DiamondStuds.com , 550 South Hill Street Suite 1095, Los Angeles, CA 90013. This business is conducted by a corporation. Registrant commenced to transact business under the fictitious business name or names listed herein on March 2013. Signed: Ishaan International Inc (CA3517655, 550 South Hill Street Suite 1095, Los Angeles, CA 90013; Alok Zaveri, Vice president. The statement was filed with the County Clerk of Los Angeles on March 4, 2025. NOTICE: This fictitious business name statement expires five years from the date it was filed in the office of the County Clerk. A new fictitious business name statement must be filed prior to that date. The filing of this statement does not of itself authorize the use in this state of a fictitious business name in violation of the rights of another under federal, state or common law (See Section 14400 et seq., Business and Professional Code). Pub. Monrovia Weekly 03/06/2025, 03/13/2025, 03/20/2025, 03/27/2025
FICTITIOUS BUSINESS NAME STATEMENT FILE NO. 2025045180 NEW FILING. The following person(s) is (are) doing business as (1). KBD Construction (2). Original Armenian (3). My phone vault (4). KBD (5). Altadena Demolition (6). Altadena Engineers (7). Altadena Co , 10968 Russett Ave, Sunland, CA 91040. This business is conducted by a individual. Registrant commenced to transact business under the fictitious business name or names listed herein on May 2006. Signed: Kevork Douzadjian, 10968 Russett Ave, Sunland, CA 91040 (Owner). The statement was filed with the County Clerk of Los Angeles on March 5, 2025. NOTICE: This fictitious business name statement expires five years from the date it was filed in the office of the County Clerk. A new fictitious business name statement must be filed prior to that date. The filing of this statement does not of itself authorize the use in this state of a fictitious business name in violation of the rights of another under federal, state or common law (See Section 14400 et seq., Business and Professional Code). Pub. Monrovia Weekly 03/13/2025, 03/20/2025, 03/27/2025, 04/03/2025
sc
FICTITIOUS BUSINESS NAME STATEMENT FILE NO. 2025 034512 NEW FILING.
The following person(s) is (are) doing business as Case management construction and Staffing service, 433 S westmoreland Ave Apt 112, Los Angeles, CA 90020. This business is conducted by a individual. Registrant commenced to transact business under the fictitious business name or names listed herein on August 2010. Signed: Aurora Rodriguez, 433 S westmoreland Ave Apt 112, Los Angeles, CA 90020 (Owner). The statement was filed with the County Clerk of Los Angeles on February 19, 2025. NOTICE: This fictitious business name statement expires five years from the date it was filed in the office of the County Clerk. A new fictitious business name statement must be filed prior to that date. The filing of this statement does not of itself authorize the use in this state of a fictitious business name in violation of the rights of another under federal, state or common law (See Section 14400 et seq., Business and Professional Code). Pub. Monrovia Weekly 03/13/2025, 03/20/2025, 03/27/2025, 04/03/2025
sc
FICTITIOUS BUSINESS NAME STATEMENT FILE NO. 2025 034501 NEW FILING.
The following person(s) is (are) doing business as Dick Wagner Dyno Service, 4139 Redondo Beach Blvd, Lawndale, CA 90260. This business is conducted by a individual. Registrant commenced to transact business under the fictitious business name or names listed herein on January 2002. Signed: Reid Allen Jones, 4139 Redondo Beach Blvd, Lawndale, CA 90260 (Owner). The statement was filed with the County Clerk of Los Angeles on February 19, 2025. NOTICE: This fictitious business name statement expires five years from the date it was filed in the office of the County Clerk. A new fictitious business name statement must be filed prior to that date. The filing of this statement does not of itself authorize the use in this state of a fictitious business name in violation of the rights of another under federal, state or common law (See Section 14400 et seq., Business and Professional Code). Pub. Monrovia Weekly 03/13/2025, 03/20/2025, 03/27/2025, 04/03/2025 sc
FICTITIOUS BUSINESS NAME STATEMENT FILE NO. 2025 034521
NEW FILING.
The following person(s) is (are) doing business as Downtown Flowers Net, 505 S Flower St Lecel B, Los Angeles, CA 90071. This business is conducted by a individual. Registrant commenced to transact business under the fictitious business name or names listed herein on March 2006.
Signed: Gabriel Soto Para, 505 S Flower St Lecel B, Los Angeles, CA 90071 (Owner). The statement was filed with the County Clerk of Los Angeles on February 19, 2025. NOTICE: This fictitious business name statement expires five years from the date it was filed in the office of the County Clerk. A new fictitious business name statement must be filed prior to that date. The filing of this statement does
not of itself authorize the use in this state of a fictitious business name in violation of the rights of another under federal, state or common law (See Section 14400 et seq., Business and Professional Code). Pub. Monrovia Weekly 03/13/2025, 03/20/2025, 03/27/2025, 04/03/2025
sc
FICTITIOUS BUSINESS NAME STATEMENT FILE NO. 2025 045503 NEW FILING.
The following person(s) is (are) doing business as Earthing Massage, 220 N Maclay Ave Ste 1, San Fernando, CA 91340. This business is conducted by a individual. Registrant commenced to transact business under the fictitious business name or names listed herein on February 2020. Signed: Londy Abu Perusquia, 5000 Whitsett Ave #201, Valley Village, Ca 91607 (Owner). The statement was filed with the County Clerk of Los Angeles on February 19, 2025. NOTICE: This fictitious business name statement expires five years from the date it was filed in the office of the County Clerk. A new fictitious business name statement must be filed prior to that date. The filing of this statement does not of itself authorize the use in this state of a fictitious business name in violation of the rights of another under federal, state or common law (See Section 14400 et seq., Business and Professional Code).
Pub. Monrovia Weekly 03/13/2025, 03/20/2025, 03/27/2025, 04/03/2025
sc
FICTITIOUS BUSINESS NAME STATEMENT FILE NO. 2025 034517
NEW FILING.
The following person(s) is (are) doing business as Gledhall I, 3186 Sunset Hill Blvd, Thousand Oaks, CA 91362. This business is conducted by a general partnership. Registrant has not yet begun to transact business under the fictitious business name or names listed herein. Signed: (1). Earl Lyons, 3186 Sunset Hill Blvd, Thousand Oaks, CA 91362 (2). Richard P Stevens II, 3186 Sunset Hill Blvd, Thousand Oaks, CA 91362 (General Partner). The statement was filed with the County Clerk of Los Angeles on February 19, 2025. NOTICE:
This fictitious business name statement expires five years from the date it was filed in the office of the County Clerk. A new fictitious business name statement must be filed prior to that date. The filing of this statement does not of itself authorize the use in this state of a fictitious business name in violation of the rights of another under federal, state or common law (See Section 14400 et seq., Business and Professional Code). Pub. Monrovia Weekly 03/13/2025, 03/20/2025, 03/27/2025, 04/03/2025 sc
FICTITIOUS BUSINESS NAME STATEMENT FILE NO. 2025 034509 NEW FILING. The following person(s) is (are) doing business as Hunters Roofing, 18328 Eddy St, Northridge, CA 91325. This business is conducted by a individual. Registrant has not yet begun to transact business under the fictitious business name or names listed herein. Signed: D.M. Hunter Enterprises, Inc (CA-2383806, 18328 Eddy St, Northridge, CA 91325; Douglas Michael Hunter, President (President). The statement was filed with the County Clerk of Los Angeles on February 19, 2025.
NOTICE: This fictitious business name statement expires five years from the date it was filed in the office of the County Clerk. A new fictitious business name statement must be filed prior to that date. The filing of this statement does not of itself authorize the use in this state of a fictitious business name in violation of the rights of another under federal, state or common law (See Section 14400 et seq., Business and Professional Code).
Pub. Monrovia Weekly 03/13/2025, 03/20/2025, 03/27/2025, 04/03/2025
sc
FICTITIOUS BUSINESS NAME STATEMENT FILE NO. 2025027450 NEW FILING. The following person(s) is (are) doing business as Shiromaru Yakitori, 1001 W Beverly Blvd, Montebello, CA 90640. This business is conducted by a limited liability company (llc). Registrant has not yet begun to transact business under the fictitious business name or names listed herein. Signed: Shiromaru LLC (CA-333330647, 1001 W Beverly Blvd, Montebello, CA 90640; Sean Lee, President. The statement was filed with the County Clerk of Los Angeles on February 11, 2025. NOTICE: This fictitious business
name statement expires five years from the date it was filed in the office of the County Clerk. A new fictitious business name statement must be filed prior to that date. The filing of this statement does not of itself authorize the use in this state of a fictitious business name in violation of the rights of another under federal, state or common law (See Section 14400 et seq., Business and Professional Code).
Pub. Monrovia Weekly 03/13/2025, 03/20/2025, 03/27/2025, 04/03/2025
FICTITIOUS BUSINESS NAME STATEMENT FILE NO. 2025046855 NEW FILING.
The following person(s) is (are) doing business as Grip Homes, 920 Tularosa Drive, Los Angeles, CA 90026. This business is conducted by a individual. Registrant commenced to transact business under the fictitious business name or names listed herein on March 2025. Signed: Sunah Biltsted, 920 Tularosa Drive, Los Angeles, CA 90026 (Owner). The statement was filed with the County Clerk of Los Angeles on March 7, 2025. NOTICE: This fictitious business name statement expires five years from the date it was filed in the office of the County Clerk. A new fictitious business name statement must be filed prior to that date. The filing of this statement does not of itself authorize the use in this state of a fictitious business name in violation of the rights of another under federal, state or common law (See Section 14400 et seq., Business and Professional Code).
Pub. Monrovia Weekly 03/13/2025, 03/20/2025, 03/27/2025, 04/03/2025
FICTITIOUS BUSINESS NAME STATEMENT FILE NO. 2025045000 NEW FILING.
The following person(s) is (are) doing business as Adapt Productions, 18043 Burbank Blvd, Encino, CA 91316. This business is conducted by a limited liability company (llc). Registrant has not yet begun to transact business under the fictitious business name or names listed herein. Signed: Common Sense Media LLC (CA202101211308, 18043 Burbank Blvd, Encino, CA 91316; Thomas Howard, Managing Partner. The statement was filed with the County Clerk of Los Angeles on March 5, 2025. NOTICE: This fictitious business name statement expires five years from the date it was filed in the office of the County Clerk. A new fictitious business name statement must be filed prior to that date. The filing of this statement does not of itself authorize the use in this state of a fictitious business name in violation of the rights of another under federal, state or common law (See Section 14400 et seq., Business and Professional Code).
Pub. Monrovia Weekly 03/13/2025, 03/20/2025, 03/27/2025, 04/03/2025
FICTITIOUS BUSINESS NAME STATEMENT FILE NO. 2025035044 NEW FILING.
The following person(s) is (are) doing business as Mirandan, 429 E Grinnell Dr, Burbank, CA 91501. This business is conducted by a individual. Registrant has not yet begun to transact business under the fictitious business name or names listed herein. Signed: Ruba Griffith, 429 E Grinnell Dr, Burbank, CA 91501 (Owner). The statement was filed with the County Clerk of Los Angeles on February 20, 2025. NOTICE: This fictitious business name statement expires five years from the date it was filed in the office of the County Clerk. A new fictitious business name statement must be filed prior to that date. The filing of this statement does not of itself authorize the use in this state of a fictitious business name in violation of the rights of another under federal, state or common law (See Section 14400 et seq., Business and Professional Code).
Pub. Monrovia Weekly 03/13/2025, 03/20/2025, 03/27/2025, 04/03/2025
FICTITIOUS BUSINESS NAME STATEMENT FILE NO. 2025045798
NEW FILING.
The following person(s) is (are) doing business as Code Glam, 11850 Skylark Circle #3101, Whittier, CA 90606. This business is conducted by a individual. Registrant commenced to transact business under the fictitious business name or names listed herein on March 2025. Signed: Adriana Christina Millan, 11850 Skylark Circle #3101, Whittier, CA 90606 (Owner). The statement was filed with the County Clerk of Los Angeles on March 6, 2025. NOTICE: This fictitious business name statement expires five years from the date it was filed in the office of the County Clerk. A new fictitious business name statement must be filed prior to that date. The filing
of this statement does not of itself authorize the use in this state of a fictitious business name in violation of the rights of another under federal, state or common law (See Section 14400 et seq., Business and Professional Code).
Pub. Monrovia Weekly 03/13/2025, 03/20/2025, 03/27/2025, 04/03/2025
FICTITIOUS BUSINESS NAME STATEMENT FILE NO. 2025044142
NEW FILING.
The following person(s) is (are) doing business as NARB CONSTRUCTION, 1122 ELM AVE APT 105, Glendale, CA 91201. This business is conducted by a individual. Registrant has not yet begun to transact business under the fictitious business name or names listed herein. Signed: Narbeh Avanessian, 1122 ELM AVE APT 105, Glendale, CA 91201 (Owner). The statement was filed with the County Clerk of Los Angeles on March 4, 2025. NOTICE: This fictitious business name statement expires five years from the date it was filed in the office of the County Clerk. A new fictitious business name statement must be filed prior to that date. The filing of this statement does not of itself authorize the use in this state of a fictitious business name in violation of the rights of another under federal, state or common law (See Section 14400 et seq., Business and Professional Code).
Pub. Monrovia Weekly 03/13/2025, 03/20/2025, 03/27/2025, 04/03/2025
FICTITIOUS BUSINESS NAME STATEMENT FILE NO. 2025048695 NEW FILING.
The following person(s) is (are) doing business as El Gallo Bakery, 4546 E Cesar E Chavez Ave, Los Angeles, CA 90022. This business is conducted by a corporation. Registrant commenced to transact business under the fictitious business name or names listed herein on March 2025. Signed: ElGB, Inc (CA-2265115, 4546 E Cesar E Chavez Ave, Los Angeles, CA 90022; Jesus Gabriel Huerta, president. The statement was filed with the County Clerk of Los Angeles on March 10, 2025.
NOTICE: This fictitious business name statement expires five years from the date it was filed in the office of the County Clerk. A new fictitious business name statement must be filed prior to that date. The filing of this statement does not of itself authorize the use in this state of a fictitious business name in violation of the rights of another under federal, state or common law (See Section 14400 et seq., Business and Professional Code).
Pub. Monrovia Weekly 03/13/2025, 03/20/2025, 03/27/2025, 04/03/2025
FICTITIOUS BUSINESS NAME STATEMENT FILE NO. 2025045780 NEW FILING.
The following person(s) is (are) doing business as GEORGE INDUSTRIES, 2125 Lemon Street, Alhambra, CA 91830. This business is conducted by a corporation. Registrant commenced to transact business under the fictitious business name or names listed herein on October 1957. Signed: George Industries, Inc. (CA-345028, 2125 Lemon Street, Alhambra, CA 91830; Patrick Golling, President. The statement was filed with the County Clerk of Los Angeles on March 6, 2025. NOTICE: This fictitious business name statement expires five years from the date it was filed in the office of the County Clerk. A new fictitious business name statement must be filed prior to that date. The filing of this statement does not of itself authorize the use in this state of a fictitious business name in violation of the rights of another under federal, state or common law (See Section 14400 et seq., Business and Professional Code).
Pub. Monrovia Weekly 03/13/2025, 03/20/2025, 03/27/2025, 04/03/2025
FICTITIOUS BUSINESS NAME STATEMENT FILE NO. 2025046715 NEW FILING. The following person(s) is (are) doing business as Old Brand New ; Old Brand New Apparel, 985 Mayo St, Los Angeles, CA 90042. This business is conducted by a corporation. Registrant commenced to transact business under the fictitious business name or names listed herein on February 2025. Signed: Total Sales Inc (CA-3392782, 985 Mayo St, Los Angeles, CA 90042; joshua rodner, president. The statement was filed with the County Clerk of Los Angeles on March 7, 2025. NOTICE: This fictitious business name statement expires five years from the date it was filed in the office of the County Clerk. A new fictitious business name statement must be filed prior to that date. The filing of this statement does not of itself authorize the use in this state of a fictitious business name in violation of the rights of another under federal, state or common law (See Section 14400 et seq., Business and Professional Code). Pub. Monrovia Weekly 03/13/2025, 03/20/2025, 03/27/2025, 04/03/2025
FICTITIOUS BUSINESS NAME STATEMENT FILE NO. 2025045071 NEW FILING. The following person(s) is (are) doing business as King Massage, 14157 Lambert Road Unit AB, Whittier, CA 90605. This business is conducted by a individual. Registrant commenced to transact business under the fictitious business name or names listed herein on March 2025. Signed: Baoshu Xie, 14157 Lambert Road Unit AB, Whittier, CA 90605 (Owner). The statement was filed with the County Clerk of Los Angeles on March 5, 2025. NOTICE: This fictitious business name statement expires five years from the date it was filed in the office of the County Clerk. A new fictitious business name statement must be filed prior to that date. The filing of this statement does not of itself authorize the use in this state of a fictitious business name in violation of the rights of another under federal, state or common law (See Section 14400 et seq., Business and Professional Code). Pub. Monrovia Weekly 03/13/2025, 03/20/2025, 03/27/2025, 04/03/2025
FICTITIOUS BUSINESS NAME STATEMENT FILE NO. 2025047686 NEW FILING. The following person(s) is (are) doing business as The Hand Laundry & Drycleaners, 606 S Lake Ave, Pasadena, CA 91106. This business is conducted by a limited liabilty partnership. Registrant commenced to transact business under the fictitious business name or names listed herein on March 2025. Signed: French Hand Cleaners, LP (CA-3897507, 606 S Lake Ave, Pasadena, CA 91106; Cira Flores, General partner. The statement was filed with the County Clerk of Los Angeles on March 5, 2025. NOTICE: This fictitious business name statement expires five years from the date it was filed in the office of the County Clerk. A new fictitious business name statement must be filed prior to that date. The filing of this statement does not of itself authorize the use in this state of a fictitious business name in violation of the rights of another under federal, state or common law (See Section 14400 et seq., Business and Professional Code). Pub. Monrovia Weekly 03/13/2025, 03/20/2025, 03/27/2025, 04/03/2025
FICTITIOUS BUSINESS NAME STATEMENT FILE NO. 2025 046206 FIRST FILING. The following person(s) is (are) doing business as Genki Dental, 157 N Garfield Ave, Alhambra, CA 91801. This business is conducted by a corporation. Registrant commenced to transact business under the fictitious business name or names listed herein on January 2025. Signed: Nonaka Dental Corporation (CA-333074528, 157 N Garfield Ave, Alhambra, CA 91801; Anna Nonaka, President. The statement was filed with the County Clerk of Los Angeles on March 6, 2025. NOTICE: This fictitious business name statement expires five years from the date it was filed in the office of the County Clerk. A new fictitious business name statement must be filed prior to that date. The filing of this statement does not of itself authorize the use in this state of a fictitious business name in violation of the rights of another
FICTITIOUS BUSINESS NAME STATEMENT FILE NO. 2025042224 NEW FILING. The following person(s) is (are) doing business as Sunflower Post Production, 6239 Beck Ave 301, North Hollywood, CA 91606. This business is conducted by a individual. Registrant has not yet begun to transact business under the fictitious business name or names listed herein. Signed: Ocilia Newby, 6239 Beck Ave 301, North Hollywood, CA 91606 (Owner). The statement was filed with the County Clerk of Los Angeles on February 28, 2025. NOTICE: This fictitious business name statement expires five years from the date it was filed in the office of the County Clerk. A new fictitious business name statement must be filed prior to that date. The filing of this statement does not of itself authorize the use in this state of a fictitious business name in violation of the rights of another under federal, state or common law (See Section 14400 et seq., Business and Professional Code). Pub. Monrovia Weekly 03/13/2025, 03/20/2025, 03/27/2025, 04/03/2025
under federal, state or common law (See Section 14400 et seq., Business and Professional Code).
Pub. Monrovia Weekly 03/13/2025, 03/20/2025, 03/27/2025, 04/03/2025
FICTITIOUS BUSINESS NAME
STATEMENT FILE NO. 2025033598
NEW FILING.
The following person(s) is (are) doing business as FRAGOZA & SONS TRUCKING INC, 5921 Brayton Ave, Long Beach, CA 90805. This business is conducted by a corporation. Registrant has not yet begun to transact business under the fictitious business name or names listed herein. Signed: FRAGOZA & SONS TRUCKING INC
(CA-A3654515, 5921 Brayton Ave, Long Beach, CA 90805; ESTEBAN FRAGOZA JR, President. The statement was filed with the County Clerk of Los Angeles on February 18, 2025. NOTICE: This fictitious business name statement expires five years from the date it was filed in the office of the County Clerk. A new fictitious business name statement must be filed prior to that date. The filing of this statement does not of itself authorize the use in this state of a fictitious business name in violation of the rights of another under federal, state or common law (See Section 14400 et seq., Business and Professional Code). Pub. Monrovia Weekly 03/13/2025, 03/20/2025, 03/27/2025, 04/03/2025
FICTTIOUS BUSINESS NAME STATEMENT FILE NO. 2025031723 NEW FILING.
The following person(s) is (are) doing business as (1). Quality Notary Services (2). Fancy’s Arts & Crafts , 2222 Huntington Dr apt 76, Duarte, CA 91010. This business is conducted by a limited liability company (llc). Registrant has not yet begun to transact business under the fictitious business name or names listed herein. Signed: VHS PS5 LLC (CA-202565210241, 2222 Huntington Dr 76, Duarte, CA 91010; Victor Sanchez, CEO. The statement was filed with the County Clerk of Los Angeles on February 14, 2025. NOTICE: This fictitious business name statement expires five years from the date it was filed in the office of the County Clerk. A new fictitious business name statement must be filed prior to that date. The filing of this statement does not of itself authorize the use in this state of a fictitious business name in violation of the rights of another under federal, state or common law (See Section 14400 et seq., Business and Professional Code).
Pub. Monrovia Weekly 03/13/2025, 03/20/2025, 03/27/2025, 04/03/2025
FICTITIOUS BUSINESS NAME STATEMENT FILE NO. 2025046949 NEW FILING.
The following person(s) is (are) doing business as ALKAS Solutions, 2088 S Atlantic Blvd Suite 281, Monterey Park, CA 91754. This business is conducted by a individual. Registrant commenced to transact business under the fictitious business name or names listed herein on January 2011. Signed: Adrian Guerrero, 2088 S Atlantic Blvd Suite 281, Monterey Park, CA 91754 (Owner). The statement was filed with the County Clerk of Los Angeles on March 7, 2025. NOTICE: This fictitious business name statement expires five years from the date it was filed in the office of the County Clerk. A new fictitious business name statement must be filed prior to that date. The filing of this statement does not of itself authorize the use in this state of a fictitious business name in violation of the rights of another under federal, state or common law (See Section 14400 et seq., Business and Professional Code).
Pub. Monrovia Weekly 03/13/2025, 03/20/2025, 03/27/2025, 04/03/2025
FICTITIOUS BUSINESS NAME STATEMENT FILE NO. 2025046953 NEW FILING. The following person(s) is (are) doing business as ACG Digital Media, 2088 S Atlantic Blvd Suite 281, Monterey Park, CA 91754. This business is conducted by a individual. Registrant commenced to transact business under the fictitious business name or names listed herein on January 2015. Signed: Adrian Guerrero, 2088 S Atlantic Blvd Suite 281, Monterey Park, CA 91754 (Owner). The statement was filed with the County Clerk of Los Angeles on March 7, 2025. NOTICE: This fictitious business name statement expires five years from the date it was filed in the office of the County Clerk. A new fictitious business name statement must be filed prior to that date. The filing of this statement does not of itself authorize the use in this state of a fictitious business name in
violation of the rights of another under federal, state or common law (See Section 14400 et seq., Business and Professional Code). Pub. Monrovia Weekly 03/13/2025, 03/20/2025, 03/27/2025, 04/03/2025
FICTITIOUS BUSINESS NAME STATEMENT FILE NO. 2025048188 NEW FILING. The following person(s) is (are) doing business as Thirty34 Ready Mix, 250 W. Verdugo Ave. Apt K, Burbank, CA 91502. This business is conducted by a limited liability company (llc). Registrant commenced to transact business under the fictitious business name or names listed herein on March 2025. Signed: Thirty34 Ready Mix (CA-20210410244, 250 W. Verdugo Ave. Apt K, Burbank, CA 91502; Raquel Dominguez, manager. The statement was filed with the County Clerk of Los Angeles on March 10, 2025. NOTICE: This fictitious business name statement expires five years from the date it was filed in the office of the County Clerk. A new fictitious business name statement must be filed prior to that date. The filing of this statement does not of itself authorize the use in this state of a fictitious business name in violation of the rights of another under federal, state or common law (See Section 14400 et seq., Business and Professional Code). Pub. Monrovia Weekly 03/13/2025, 03/20/2025, 03/27/2025, 04/03/2025
FICTITIOUS BUSINESS NAME STATEMENT FILE NO. 2025044388 NEW FILING.
The following person(s) is (are) doing business as Raquel Dominguez The Bookkeeper, 250 W. Verdugo Ave. Apt K, Burbank, CA 91502. This business is conducted by a individual. Registrant has not yet begun to transact business under the fictitious business name or names listed herein. Signed: Raquel Dominguez, 250 W. Verdugo Ave. Apt K, Burbank, CA 91502 (Owner). The statement was filed with the County Clerk of Los Angeles on March 4, 2025. NOTICE: This fictitious business name statement expires five years from the date it was filed in the office of the County Clerk. A new fictitious business name statement must be filed prior to that date. The filing of this statement does not of itself authorize the use in this state of a fictitious business name in violation of the rights of another under federal, state or common law (See Section 14400 et seq., Business and Professional Code).
Pub. Monrovia Weekly 03/13/2025, 03/20/2025, 03/27/2025, 04/03/2025
FICTITIOUS BUSINESS NAME STATEMENT FILE NO. 2025024486 NEW FILING.
The following person(s) is (are) doing business as (1). B-Side Los Angeles (2). B-Side LA (3). Eyes Down Los Angeles (4). Eyes Down LA (5). Bside Events , 4162 Via Mira Monte, Calabasas, CA 91301. This business is conducted by a individual. Registrant commenced to transact business under the fictitious business name or names listed herein on August 2021. Signed: (1). Stephen Huckins, 6803 Tomy Lee Traol, Tallahassee, Fl 32309 (2). Murad rezian, 8822 Willis Ave, Unit 4, Panorama City, Ca 91402. Stephen Huckins (Owner). The statement was filed with the County Clerk of Los Angeles on February 6, 2025. NOTICE: This fictitious business name statement expires five years from the date it was filed in the office of the County Clerk. A new fictitious business name statement must be filed prior to that date. The filing of this statement does not of itself authorize the use in this state of a fictitious business name in violation of the rights of another under federal, state or common law (See Section 14400 et seq., Business and Professional Code). Pub. Monrovia Weekly 03/13/2025, 03/20/2025, 03/27/2025, 04/03/2025
FICTITIOUS BUSINESS NAME STATEMENT FILE NO. 2025 046140 FIRST FILING. The following person(s) is (are) doing business as CANDY COMPOSER, 1120 San Rafael Ave Apt A, Glendale, CA 91202. This business is conducted by a individual. Registrant commenced to transact business under the fictitious business name or names listed herein on March 2025. Signed: Candace Emberley, 1120 San Rafael Ave Apt A, Glendale, CA 91202 (Owner). The statement was filed with the County Clerk of Los Angeles on March 6, 2025. NOTICE: This fictitious business name statement expires five years from the date it was filed in the office of the County Clerk. A new fictitious business name statement must be filed prior to that date.
The filing of this statement does not of itself authorize the use in this state of a fictitious business name in violation of the rights of another under federal, state or common law (See Section 14400 et seq., Business and Professional Code).
Pub. Monrovia Weekly 03/13/2025, 03/20/2025, 03/27/2025, 04/03/2025
FICTITIOUS BUSINESS NAME STATEMENT FILE NO. 2025047610
NEW FILING.
The following person(s) is (are) doing business as Audio Bible Daily, 14140 Mulberry Dr, Whittier, CA 90605. This business is conducted by a individual. Registrant commenced to transact business under the fictitious business name or names listed herein on March 2025. Signed: Carlos Alberto Acosta, 14140 Mulberry Dr, Whittier, CA 90605 (Owner). The statement was filed with the County Clerk of Los Angeles on March 10, 2025.
NOTICE: This fictitious business name statement expires five years from the date it was filed in the office of the County Clerk. A new fictitious business name statement must be filed prior to that date. The filing of this statement does not of itself authorize the use in this state of a fictitious business name in violation of the rights of another under federal, state or common law (See Section 14400 et seq., Business and Professional Code).
Pub. Monrovia Weekly 03/13/2025, 03/20/2025, 03/27/2025, 04/03/2025
FICTITIOUS BUSINESS NAME STATEMENT FILE NO. 2025045103
NEW FILING.
The following person(s) is (are) doing business as M C Trading, 401 E 11th St Unit 101, Los Angeles, CA 90015. This business is conducted by a individual. Registrant commenced to transact business under the fictitious business name or names listed herein on April 2015. Signed: CongMing Yu, 825 Euclid Ave, San Gabriel, Ca 91776 (Owner). The statement was filed with the County Clerk of Los Angeles on March 5, 2025. NOTICE: This fictitious business name statement expires five years from the date it was filed in the office of the County Clerk. A new fictitious business name statement must be filed prior to that date. The filing of this statement does not of itself authorize the use in this state of a fictitious business name in violation of the rights of another under federal, state or common law (See Section 14400 et seq., Business and Professional Code).
Pub. Monrovia Weekly 03/13/2025, 03/20/2025, 03/27/2025, 04/03/2025
FICTITIOUS BUSINESS NAME
STATEMENT FILE NO. 2025044950
NEW FILING.
The following person(s) is (are) doing business as Linewerks Supply Co., 860 Hallwood Ave, Pomona, CA 91767. This business is conducted by a individual. Registrant commenced to transact business under the fictitious business name or names listed herein on February 2025. Signed: Edgar Llanos, 860 Hallwood Ave, Pomona, CA 91767 (Owner). The statement was filed with the County Clerk of Los Angeles on March 5, 2025. NOTICE: This fictitious business name statement expires five years from the date it was filed in the office of the County Clerk. A new fictitious business name statement must be filed prior to that date. The filing of this statement does not of itself authorize the use in this state of a fictitious business name in violation of the rights of another under federal, state or common law (See Section 14400 et seq., Business and Professional Code). Pub. Monrovia Weekly 03/13/2025, 03/20/2025, 03/27/2025, 04/03/2025
FICTITIOUS BUSINESS NAME
STATEMENT FILE NO. 2025046935
NEW FILING. The following person(s) is (are) doing business as Sol Healing Therapy, 6737 Bright Ave 211, Whittier, CA 90601. This business is conducted by a individual. Registrant commenced to transact business under the fictitious business name or names listed herein on February 2020. Signed: Barbara Angela Guerrero, 347 S. Gerhart Ave, East Los Angeles, Ca 90022(Owner). The statement was filed with the County Clerk of Los Angeles on March 7, 2025. NOTICE: This fictitious business name statement expires five years from the date it was filed in the office of the County Clerk. A new fictitious business name statement must be filed prior to that date. The filing of this statement does not of itself authorize the use in this state of a fictitious business name in
violation of the rights of another under federal, state or common law (See Section 14400 et seq., Business and Professional Code).
Pub. Monrovia Weekly 03/13/2025, 03/20/2025, 03/27/2025, 04/03/2025
FICTITIOUS BUSINESS NAME STATEMENT FILE NO. 2025033775 NEW FILING.
The following person(s) is (are) doing business as Brothers BBQ, 18888 Labin Ct Ste 105, Rowland Heights, CA 91748. This business is conducted by a individual. Registrant commenced to transact business under the fictitious business name or names listed herein on February 2025. Signed: Lucky BBQ Inc (CA-6217409, 18888 Labin Ct Ste 105, Rowland Heights, CA 91748; Zhuo Zhi Huang, President (Owner). The statement was filed with the County Clerk of Los Angeles on February 19, 2025. NOTICE: This fictitious business name statement expires five years from the date it was filed in the office of the County Clerk. A new fictitious business name statement must be filed prior to that date. The filing of this statement does not of itself authorize the use in this state of a fictitious business name in violation of the rights of another under federal, state or common law (See Section 14400 et seq., Business and Professional Code).
Pub. Monrovia Weekly 03/13/2025, 03/20/2025, 03/27/2025, 04/03/2025
FICTITIOUS BUSINESS NAME STATEMENT FILE NO. 2025023702 NEW FILING.
The following person(s) is (are) doing business as OMG Cookies, 2610 Lincoln Lane, Palmdale, CA 93551. This business is conducted by a individual. Registrant commenced to transact business under the fictitious business name or names listed herein on January 2025. Signed: Jerry Milling III, 2610 Lincoln Lane, Palmdale, CA 93551 (Owner). The statement was filed with the County Clerk of Los Angeles on February 5, 2025. NOTICE: This fictitious business name statement expires five years from the date it was filed in the office of the County Clerk. A new fictitious business name statement must be filed prior to that date. The filing of this statement does not of itself authorize the use in this state of a fictitious business name in violation of the rights of another under federal, state or common law (See Section 14400 et seq., Business and Professional Code).
Pub. Monrovia Weekly 03/13/2025, 03/20/2025, 03/27/2025, 04/03/2025
FICTITIOUS BUSINESS NAME STATEMENT FILE NO. 2025046805 NEW FILING.
The following person(s) is (are) doing business as ZONFAIR.COM, 15080 Desman Rd, La Mirada, CA 90638. This business is conducted by a corporation. Registrant commenced to transact business under the fictitious business name or names listed herein on March 2025. Signed: 2WORLD GROUP INC (CA-C4292044, 15080 Desman Rd, La Mirada, CA 90638; DUC MAI, PRESIDENT. The statement was filed with the County Clerk of Los Angeles on March 7, 2025. NOTICE: This fictitious business name statement expires five years from the date it was filed in the office of the County Clerk. A new fictitious business name statement must be filed prior to that date. The filing of this statement does not of itself authorize the use in this state of a fictitious business name in violation of the rights of another under federal, state or common law (See Section 14400 et seq., Business and Professional Code).
Pub. Monrovia Weekly 03/13/2025, 03/20/2025, 03/27/2025, 04/03/2025
FICTITIOUS BUSINESS NAME STATEMENT FILE NO. 2025046663
NEW FILING.
The following person(s) is (are) doing business as La Trinidad UMC, 3565 1st Street, Los Angeles, CA 90063. This business is conducted by a corporation. Registrant has not yet begun to transact business under the fictitious business name or names listed herein. Signed: Primera Iglesia Metodista ‘La Trinidad’ Incorporated. (CA-356474, 3565 1st Street, Los Angeles, CA 90063; Phillip Valdes, CEO. The statement was filed with the County Clerk of Los Angeles on March 7, 2025.
NOTICE: This fictitious business name statement expires five years from the date it was filed in the office of the County Clerk. A new fictitious business name statement must be filed prior to that date. The filing of this statement does not of itself authorize the use in this state of a fictitious business name in violation of the rights of
another under federal, state or common law (See Section 14400 et seq., Business and Professional Code).
Pub. Monrovia Weekly 03/13/2025, 03/20/2025, 03/27/2025, 04/03/2025
FICTITIOUS BUSINESS NAME STATEMENT FILE NO. 2025045616
NEW FILING.
The following person(s) is (are) doing business as Adams Bookkeeping, 452 Shadyglen Lane, San Dimas, CA 91773. This business is conducted by a individual. Registrant commenced to transact business under the fictitious business name or names listed herein on March 2025. Signed: Mary E Herriott, 452 Shadyglen Lane, San Dimas, CA 91773 (Owner). The statement was filed with the County Clerk of Los Angeles on March 5, 2025. NOTICE: This fictitious business name statement expires five years from the date it was filed in the office of the County Clerk. A new fictitious business name statement must be filed prior to that date. The filing of this statement does not of itself authorize the use in this state of a fictitious business name in violation of the rights of another under federal, state or common law (See Section 14400 et seq., Business and Professional Code).
Pub. Monrovia Weekly 03/13/2025, 03/20/2025, 03/27/2025, 04/03/2025
FICTITIOUS BUSINESS NAME STATEMENT FILE NO. 2025042991 NEW FILING. The following person(s) is (are) doing business as NOLA CHILL, 877 West El Repetto Dr, Monterey Park, CA 91754. This business is conducted by a individual. Registrant commenced to transact business under the fictitious business name or names listed herein on January 2025. Signed: Haseem Parker, 877 West El Repetto Dr B67, Monterey Park, CA 91754 (Owner). The statement was filed with the County Clerk of Los Angeles on March 3, 2025. NOTICE: This fictitious business name statement expires five years from the date it was filed in the office of the County Clerk. A new fictitious business name statement must be filed prior to that date. The filing of this statement does not of itself authorize the use in this state of a fictitious business name in violation of the rights of another under federal, state or common law (See Section 14400 et seq., Business and Professional Code).
Pub. Monrovia Weekly 03/13/2025, 03/20/2025, 03/27/2025, 04/03/2025
FICTITIOUS BUSINESS NAME STATEMENT FILE NO. 2025 043452 FIRST FILING.
The following person(s) is (are) doing business as Clair Value, 4830 White Oak Ridge Rd, McEwen, TN 37101. This business is conducted by a limited liability company (llc). Registrant has not yet begun to transact business under the fictitious business name or names listed herein. Signed: Jessica Brown, 4830 White Oak Ridge Rd, McEwen, TN 37101. The statement was filed with the County Clerk of Humphreys on March 3, 2025. NOTICE: This fictitious business name statement expires five years from the date it was filed in the office of the County Clerk. A new fictitious business name statement must be filed prior to that date. The filing of this statement does not of itself authorize the use in this state of a fictitious business name in violation of the rights of another under federal, state or common law (See Section 14400 et seq., Business and Professional Code). Pub. Monrovia Weekly 03/13/2025, 03/20/2025, 03/27/2025, 04/03/2025
FICTITIOUS BUSINESS NAME STATEMENT FILE NO. 2025046447 NEW FILING.
The following person(s) is (are) doing business as ALEX MONTES HANDYMAN SERVICES, 4909 Fortin St, Baldwin Park, CA 91706. This business is conducted by a individual. Registrant commenced to transact business under the fictitious business name or names listed herein on March 2025. Signed: ALEJANDRO MONTES SANCHEZ, 4909 Fortin St, Baldwin Park, CA 91706 (Owner). The statement was filed with the County Clerk of Los Angeles on March 6, 2025. NOTICE: This fictitious business name statement expires five years from the date it was filed in the office of the County Clerk. A new fictitious business name statement must be filed prior to that date. The filing of this statement does not of itself authorize the use in this state of a fictitious business name in violation of the rights of another under federal, state or common law (See Section 14400 et seq., Business and Professional Code). Pub. Monrovia Weekly 03/13/2025,
03/20/2025, 03/27/2025, 04/03/2025
FICTITIOUS BUSINESS NAME STATEMENT FILE NO. 2025025299
NEW FILING. The following person(s) is (are) doing business as (1). Freedom Martial Arts and Fitness (2). Freedom Martial Arts (3). Freedom Karate (4). Freedom Kickboxing (5). Freedom Fitness (6). Rock Steady Boxing (7). Rock Steady Boxing Los Angeles (8). Rock Steady Boxing Freedom Martial Arts and Fitness , 5607 Huntington Dr N, Los Angeles, CA 90032. This business is conducted by a corporation. Registrant commenced to transact business under the fictitious business name or names listed herein on November 2024. Signed: Freedom Martial Arts and Fitness, Inc. (CAC4278296, 5607 Huntington Dr N, Los Angeles, CA 90032; Adam N. Parth, CEO. The statement was filed with the County Clerk of Los Angeles on February 6, 2025. NOTICE: This fictitious business name statement expires five years from the date it was filed in the office of the County Clerk. A new fictitious business name statement must be filed prior to that date. The filing of this statement does not of itself authorize the use in this state of a fictitious business name in violation of the rights of another under federal, state or common law (See Section 14400 et seq., Business and Professional Code). Pub. Monrovia Weekly 03/13/2025, 03/20/2025, 03/27/2025, 04/03/2025
FICTITIOUS BUSINESS NAME STATEMENT FILE NO. 2025031017 NEW FILING. The following person(s) is (are) doing business as GFS CONSTRUCTION, 1242 W Masline St, Covina, CA 91722. This business is conducted by a individual. Registrant has not yet begun to transact business under the fictitious business name or names listed herein. Signed: GERARDO FLORES-SAUCEDO, 1242 W Masline St, Covina, CA 91722 (Owner). The statement was filed with the County Clerk of Los Angeles on February 13, 2025. NOTICE: This fictitious business name statement expires five years from the date it was filed in the office of the County Clerk. A new fictitious business name statement must be filed prior to that date. The filing of this statement does not of itself authorize the use in this state of a fictitious business name in violation of the rights of another under federal, state or common law (See Section 14400 et seq., Business and Professional Code). Pub. Monrovia Weekly 03/13/2025, 03/20/2025, 03/27/2025, 04/03/2025
FICTITIOUS BUSINESS NAME STATEMENT FILE NO. 2025045891 NEW FILING.
The following person(s) is (are) doing business as Simplified Shipping, 175 E. Eldridge St, Long Beach, CA 90807. This business is conducted by a individual. Registrant commenced to transact business under the fictitious business name or names listed herein on March 2025. Signed: John Rios, 175 E. Eldridge St, Long Beach, CA 90807 (Owner). The statement was filed with the County Clerk of Los Angeles on March 6, 2025. NOTICE: This fictitious business name statement expires five years from the date it was filed in the office of the County Clerk. A new fictitious business name statement must be filed prior to that date. The filing of this statement does not of itself authorize the use in this state of a fictitious business name in violation of the rights of another under federal, state or common law (See Section 14400 et seq., Business and Professional Code). Pub. Monrovia Weekly 03/13/2025, 03/20/2025, 03/27/2025, 04/03/2025
FICTITIOUS BUSINESS NAME STATEMENT FILE NO. 2025046327 NEW FILING. The following person(s) is (are) doing business as GlowCart, 13525 Fairfield Dr., Corona, CA 92883. This business is conducted by a individual. Registrant commenced to transact business under the fictitious business name or names listed herein on March 2025. Signed: Mercis Ramirez, 13525 Fairfield Dr., Corona, CA 92883 (Owner). The statement was filed with the County Clerk of Riverside on March 6, 2025. NOTICE: This fictitious business name statement expires five years from the date it was filed in the office of the County Clerk. A new fictitious business name statement must be filed prior to that date. The filing of this statement does not of itself authorize the use in this state of a fictitious business name in
violation of the rights of another under federal, state or common law (See Section 14400 et seq., Business and Professional Code).
Pub. Monrovia Weekly 03/13/2025, 03/20/2025, 03/27/2025, 04/03/2025
FICTITIOUS BUSINESS NAME STATEMENT FILE NO. 2025055217 NEW FILING.
authorize the use in this state of a fictitious business name in violation of the rights of another under federal, state or common law (See Section 14400 et seq., Business and Professional Code). Pub. Monrovia Weekly 03/20/2025, 03/27/2025, 04/03/2025, 04/10/2025
not of itself authorize the use in this state of a fictitious business name in violation of the rights of another under federal, state or common law (See Section 14400 et seq., Business and Professional Code). Pub. Monrovia Weekly 03/20/2025, 03/27/2025, 04/03/2025, 04/10/2025
under federal, state or common law (See Section 14400 et seq., Business and Professional Code).
Pub. Monrovia Weekly 03/20/2025, 03/27/2025, 04/03/2025, 04/10/2025
FICTITIOUS BUSINESS NAME STATEMENT FILE NO. 2025052473 NEW FILING.
Code). Pub. Monrovia Weekly 03/20/2025, 03/27/2025, 04/03/2025, 04/10/2025
FICTITIOUS BUSINESS NAME STATEMENT FILE NO. 2025052986
NEW FILING.
FICTITIOUS BUSINESS NAME STATEMENT FILE NO. 2025050908 NEW FILING.
The following person(s) is (are) doing business as Reliable Construction Services, 2340 E Larkwood St, West Covina, CA 91791. This business is conducted by a corporation. Registrant commenced to transact business under the fictitious business name or names listed herein on March 2025. Signed: Reliable Dry Guys, Inc (CA-4851387, 2340 E Larkwood St, West Covina, CA 91791; Erik Jaramillo Moreno, Ceo. The statement was filed with the County Clerk of Los Angeles on March 18, 2025.
NOTICE:
This fictitious business name statement expires five years from the date it was filed in the office of the County Clerk. A new fictitious business name statement must be filed prior to that date. The filing of this statement does not of itself authorize the use in this state of a fictitious business name in violation of the rights of another under federal, state or common law (See Section 14400 et seq., Business and Professional Code). Pub. Monrovia Weekly 03/20/2025, 03/27/2025, 04/03/2025, 04/10/2025
FICTITIOUS BUSINESS NAME STATEMENT FILE NO. 2025044395 NEW FILING.
The following person(s) is (are) doing business as PANERO’S BAKERY, 12100 Valley Blvd, El Monte, CA 91732. This business is conducted by a individual. Registrant has not yet begun to transact business under the fictitious business name or names listed herein. Signed: horacio sanchez, 12100 Valley Blvd, El Monte, CA 91732 (Owner). The statement was filed with the County Clerk of Los Angeles on March 4, 2025. NOTICE: This fictitious business name statement expires five years from the date it was filed in the office of the County Clerk. A new fictitious business name statement must be filed prior to that date. The filing of this statement does not of itself authorize the use in this state of a fictitious business name in violation of the rights of another under federal, state or common law (See Section 14400 et seq., Business and Professional Code). Pub. Monrovia Weekly 03/20/2025, 03/27/2025, 04/03/2025, 04/10/2025
FICTITIOUS BUSINESS NAME STATEMENT FILE NO. 2025039109 NEW FILING.
The following person(s) is (are) doing business as “RPV” ROMANTICOS PASTELES VERDES DEL PERU., 1312 E Harvard Street Unit C, Glendale, CA 91205. This business is conducted by a individual. Registrant commenced to transact business under the fictitious business name or names listed herein on January 2025. Signed: Gustavo Adolfo Mendez, 1312 E Harvard Street Unit C, Glendale, CA 91205 (Owner). The statement was filed with the County Clerk of Los Angeles on February 25, 2025. NOTICE: This fictitious business name statement expires five years from the date it was filed in the office of the County Clerk. A new fictitious business name statement must be filed prior to that date. The filing of this statement does not of itself authorize the use in this state of a fictitious business name in violation of the rights of another under federal, state or common law (See Section 14400 et seq., Business and Professional Code). Pub. Monrovia Weekly 03/20/2025, 03/27/2025, 04/03/2025, 04/10/2025
FICTITIOUS BUSINESS NAME STATEMENT FILE NO. 2025054463 NEW FILING. The following person(s) is (are) doing business as (1). Hi-Quality Construction (2). Hi-Quality Drywall & Restoration , 2021 E Gladstone St Suite P, Glendora, CA 91740. This business is conducted by a corporation. Registrant has not yet begun to transact business under the fictitious business name or names listed herein. Signed: Hi-Quality Interiors, Inc. (CA-3959135, 2021 E Gladstone St Suite P, Glendora, CA 91740; David Perez, President. The statement was filed with the County Clerk of Los Angeles on March 17, 2025. NOTICE: This fictitious business name statement expires five years from the date it was filed in the office of the County Clerk. A new fictitious business name statement must be filed prior to that date. The filing of this statement does not of itself
FICTITIOUS BUSINESS NAME STATEMENT FILE NO. 2025052896 NEW FILING. The following person(s) is (are) doing business as (1). MON FLORAL STUDIO (2). MORNING BREEZE STUDIO (3). MORNING BREEZE FLORAL , 2064 Clover Dr, Monterey Park, CA 91755. This business is conducted by a limited liability company (llc). Registrant commenced to transact business under the fictitious business name or names listed herein on March 2025. Signed: MORNING BREEZE FLORAL LLC (CA-B20250019744, 2064 Clover Dr, Monterey Park, CA 91755; MONIKA ISAHAKYAN, CEO. The statement was filed with the County Clerk of Los Angeles on March 14, 2025. NOTICE: This fictitious business name statement expires five years from the date it was filed in the office of the County Clerk. A new fictitious business name statement must be filed prior to that date. The filing of this statement does not of itself authorize the use in this state of a fictitious business name in violation of the rights of another under federal, state or common law (See Section 14400 et seq., Business and Professional Code). Pub. Monrovia Weekly 03/20/2025, 03/27/2025, 04/03/2025, 04/10/2025
FICTITIOUS BUSINESS NAME STATEMENT FILE NO. 2025042914 FIRST FILING.
The following person(s) is (are) doing business as (1). Spectrum cuttz (2). Spectrum artistic cuttz , 13752 Cordary Ave, Hawthorne, CA 90250. This business is conducted by a individual. Registrant has not yet begun to transact business under the fictitious business name or names listed herein. Signed: Sebeko Reid, 13752 Cordary Ave, Hawthorne, CA 90250 (Owner). The statement was filed with the County Clerk of Los Angeles on March 3, 2025. NOTICE: This fictitious business name statement expires five years from the date it was filed in the office of the County Clerk. A new fictitious business name statement must be filed prior to that date. The filing of this statement does not of itself authorize the use in this state of a fictitious business name in violation of the rights of another under federal, state or common law (See Section 14400 et seq., Business and Professional Code). Pub. Monrovia Weekly 03/20/2025, 03/27/2025, 04/03/2025, 04/10/2025
FICTITIOUS BUSINESS NAME STATEMENT FILE NO. 2025039402 NEW FILING.
The following person(s) is (are) doing business as MARISCOS PUERTO ESCONDIDO, 3740 Whittier Blvd, Los Angeles, CA 90023. This business is conducted by a corporation. Registrant commenced to transact business under the fictitious business name or names listed herein on January 2025. Signed: MBEFORE40 (CA5793689, 3740 Whittier Blvd, Los Angeles, CA 90023; PAOLA RAMIREZ, PRESIDENT. The statement was filed with the County Clerk of Los Angeles on February 25, 2025. NOTICE: This fictitious business name statement expires five years from the date it was filed in the office of the County Clerk. A new fictitious business name statement must be filed prior to that date. The filing of this statement does not of itself authorize the use in this state of a fictitious business name in violation of the rights of another under federal, state or common law (See Section 14400 et seq., Business and Professional Code). Pub. Monrovia Weekly 03/20/2025, 03/27/2025, 04/03/2025, 04/10/2025
FICTITIOUS BUSINESS NAME STATEMENT FILE NO. 2025031990 NEW FILING. The following person(s) is (are) doing business as Crusade Consulting, 3158 Los Olivos Lane, La Crescenta, CA 91214. This business is conducted by a individual. Registrant commenced to transact business under the fictitious business name or names listed herein on January 2025. Signed: MARIE MALAKIAN, 3158 Los Olivos Lane, La Crescenta, CA 91214 (Owner). The statement was filed with the County Clerk of Los Angeles on February 14, 2025.
NOTICE: This fictitious business name statement expires five years from the date it was filed in the office of the County Clerk. A new fictitious business name statement must be filed prior to that date. The filing of this statement does
FICTITIOUS BUSINESS NAME STATEMENT FILE NO. 2025048771
NEW FILING.
The following person(s) is (are) doing business as Mr. Fixit, 834 W Walnut Ave, Monrovia, CA 91016. This business is conducted by a individual. Registrant commenced to transact business under the fictitious business name or names listed herein on March 2025. Signed: Angel Mendoza, 834 W Walnut Ave, Monrovia, CA 91016 (Owner). The statement was filed with the County Clerk of Los Angeles on March 11, 2025.
NOTICE: This fictitious business name statement expires five years from the date it was filed in the office of the County Clerk. A new fictitious business name statement must be filed prior to that date. The filing of this statement does not of itself authorize the use in this state of a fictitious business name in violation of the rights of another under federal, state or common law (See Section 14400 et seq., Business and Professional Code). Pub. Monrovia Weekly 03/20/2025, 03/27/2025, 04/03/2025, 04/10/2025
FICTITIOUS BUSINESS NAME STATEMENT FILE NO. 2025053661
NEW FILING.
The following person(s) is (are) doing business as Sassi Rebel, 1974 E Lynwood Dr #3B, San Bernardino, CA 92404. This business is conducted by a individual. Registrant has not yet begun to transact business under the fictitious business name or names listed herein. Signed: Celes Harvey, 1974 E Lynwood Dr #3B, San Bernardino, CA 92404 (Owner). The statement was filed with the County Clerk of San Bernardino on March 17, 2025. NOTICE: This fictitious business name statement expires five years from the date it was filed in the office of the County Clerk. A new fictitious business name statement must be filed prior to that date. The filing of this statement does not of itself authorize the use in this state of a fictitious business name in violation of the rights of another under federal, state or common law (See Section 14400 et seq., Business and Professional Code). Pub. Monrovia Weekly 03/20/2025, 03/27/2025, 04/03/2025, 04/10/2025
FICTITIOUS BUSINESS NAME STATEMENT FILE NO. 2025052099
NEW FILING.
The following person(s) is (are) doing business as St Stephen Missionary Baptist Church, 1720 Walnut Ave, La Puente, CA 91744. This business is conducted by a corporation. Registrant has not yet begun to transact business under the fictitious business name or names listed herein. Signed: St. Stephen Missionary Baptist Church (CA-595691, 1720 Walnut Ave, La Puente, CA 91744; Celes Harvey, Secretary. The statement was filed with the County Clerk of Los Angeles on March 13, 2025.
NOTICE: This fictitious business name statement expires five years from the date it was filed in the office of the County Clerk. A new fictitious business name statement must be filed prior to that date. The filing of this statement does not of itself authorize the use in this state of a fictitious business name in violation of the rights of another under federal, state or common law (See Section 14400 et seq., Business and Professional Code).
Pub. Monrovia Weekly 03/20/2025, 03/27/2025, 04/03/2025, 04/10/2025
FICTITIOUS BUSINESS NAME
STATEMENT FILE NO. 2025048392
NEW FILING.
The following person(s) is (are) doing business as Chavez Lanscape & Maintenance, 4181 Harlan Ave, Baldwin Park, CA 91706. This business is conducted by a individual. Registrant has not yet begun to transact business under the fictitious business name or names listed herein. Signed: Jose M Chavez, 4181 Harlan Ave, Baldwin Park, CA 91706 (Owner). The statement was filed with the County Clerk of Los Angeles on March 10, 2025. NOTICE: This fictitious business name statement expires five years from the date it was filed in the office of the County Clerk. A new fictitious business name statement must be filed prior to that date. The filing of this statement does not of itself authorize the use in this state of a fictitious business name in violation of the rights of another
The following person(s) is (are) doing business as Collaborative Kitchen, 201 E Newmark Ave, Monterey Park, CA 91755. This business is conducted by a individual. Registrant has not yet begun to transact business under the fictitious business name or names listed herein.
Signed: Shannon Ceniseroz, 201 E Newmark Ave, Monterey Park, CA 91755 (Owner). The statement was filed with the County Clerk of Los Angeles on March 13, 2025. NOTICE: This fictitious business name statement expires five years from the date it was filed in the office of the County Clerk. A new fictitious business name statement must be filed prior to that date. The filing of this statement does not of itself authorize the use in this state of a fictitious business name in violation of the rights of another under federal, state or common law (See Section 14400 et seq., Business and Professional Code).
Pub. Monrovia Weekly 03/20/2025, 03/27/2025, 04/03/2025, 04/10/2025
FICTITIOUS BUSINESS NAME STATEMENT FILE NO. 2025047597 NEW FILING.
The following person(s) is (are) doing business as CL Property Resouces, 655 N. Central Ave, 17th Floor, Glendale, CA 91203. This business is conducted by a corporation. Registrant commenced to transact business under the fictitious business name or names listed herein on February 2025. Signed: CPA Search Inc (CA-2487556, 655 N. Central Ave, 17th Floor, Glendale, CA 91203; Viktor Luzar, CEO. The statement was filed with the County Clerk of Los Angeles on March 10, 2025.
NOTICE: This fictitious business name statement expires five years from the date it was filed in the office of the County Clerk. A new fictitious business name statement must be filed prior to that date. The filing of this statement does not of itself authorize the use in this state of a fictitious business name in violation of the rights of another under federal, state or common law (See Section 14400 et seq., Business and Professional Code).
Pub. Monrovia Weekly 03/20/2025, 03/27/2025, 04/03/2025, 04/10/2025
FICTITIOUS BUSINESS NAME STATEMENT FILE NO. 2025053043 NEW FILING.
The following person(s) is (are) doing business as DocMoc, 117 S Louise St 313, Glendale, CA 91205. This business is conducted by a corporation. Registrant commenced to transact business under the fictitious business name or names listed herein on March 2025. Signed: DocMoc, Inc. (CA-6597502, 117 S Louise St 313, Glendale, CA 91205; Tenny Baghdasari Chalian, CEO. The statement was filed with the County Clerk of Los Angeles on March 14, 2025. NOTICE: This fictitious business name statement expires five years from the date it was filed in the office of the County Clerk. A new fictitious business name statement must be filed prior to that date. The filing of this statement does not of itself authorize the use in this state of a fictitious business name in violation of the rights of another under federal, state or common law (See Section 14400 et seq., Business and Professional Code). Pub. Monrovia Weekly 03/20/2025, 03/27/2025, 04/03/2025, 04/10/2025
FICTITIOUS BUSINESS NAME STATEMENT FILE NO. 2025051093
NEW FILING.
The following person(s) is (are) doing business as Magnum Motors, 632 Myrtle Street, Glendale, CA 91203. This business is conducted by a individual. Registrant commenced to transact business under the fictitious business name or names listed herein on April 2014. Signed: Jilbert Vartanian, 632 Myrtle Street, Glendale, CA 91203 (Owner). The statement was filed with the County Clerk of Los Angeles on March 12, 2025. NOTICE: This fictitious business name statement expires five years from the date it was filed in the office of the County Clerk. A new fictitious business name statement must be filed prior to that date. The filing of this statement does not of itself authorize the use in this state of a fictitious business name in violation of the rights of another under federal, state or common law (See Section 14400 et seq., Business and Professional
The following person(s) is (are) doing business as Stark, 9200 W Sunset Blvd, Suite 170, West Hollywood, CA 90069. This business is conducted by a corporation. Registrant commenced to transact business under the fictitious business name or names listed herein on February 2025. Signed: Stark Naturopathic and Chiropractic for Good (CA6587088, 1783 Flight Way, Tustin, Ca 92782; Justin Cheng, President. The statement was filed with the County Clerk of Los Angeles on March 14, 2025. NOTICE: This fictitious business name statement expires five years from the date it was filed in the office of the County Clerk. A new fictitious business name statement must be filed prior to that date. The filing of this statement does not of itself authorize the use in this state of a fictitious business name in violation of the rights of another under federal, state or common law (See Section 14400 et seq., Business and Professional Code).
Pub. Monrovia Weekly 03/20/2025, 03/27/2025, 04/03/2025, 04/10/2025
FICTITIOUS BUSINESS NAME STATEMENT FILE NO. 2025045545 NEW FILING. The following person(s) is (are) doing business as Domino’s Pizza #7774, 5024 Ball Rd, Cypress, CA 90630. This business is conducted by a corporation. Registrant commenced to transact business under the fictitious business name or names listed herein on June 2013. Signed: Salmex Pizza, Inc. (CA-3564570, 103 Exchange Pl, Pomona, Ca 91768; Fernando Tapia, President. The statement was filed with the County Clerk of Los Angeles on March 5, 2025. NOTICE: This fictitious business name statement expires five years from the date it was filed in the office of the County Clerk. A new fictitious business name statement must be filed prior to that date. The filing of this statement does not of itself authorize the use in this state of a fictitious business name in violation of the rights of another under federal, state or common law (See Section 14400 et seq., Business and Professional Code).
Pub. Monrovia Weekly 03/20/2025, 03/27/2025, 04/03/2025, 04/10/2025
FICTITIOUS BUSINESS NAME STATEMENT FILE NO. 2025049954
NEW FILING.
The following person(s) is (are) doing business as AEROTOOLS, 13347 Kittridge St, Van nuys, CA 91401. This business is conducted by a individual. Registrant commenced to transact business under the fictitious business name or names listed herein on February 2025. Signed: KRISTINE MURAZYAN, 13347 Kittridge St, Van nuys, CA 91401 (Owner). The statement was filed with the County Clerk of Los Angeles on March 12, 2025. NOTICE: This fictitious business name statement expires five years from the date it was filed in the office of the County Clerk. A new fictitious business name statement must be filed prior to that date. The filing of this statement does not of itself authorize the use in this state of a fictitious business name in violation of the rights of another under federal, state or common law (See Section 14400 et seq., Business and Professional Code). Pub. Monrovia Weekly 03/20/2025, 03/27/2025, 04/03/2025, 04/10/2025
FICTITIOUS BUSINESS NAME STATEMENT FILE NO. 2025045537 NEW FILING. The following person(s) is (are) doing business as Domino’s Pizza #8564, 13297 South St, Cerritos, CA 90703. This business is conducted by a corporation. Registrant commenced to transact business under the fictitious business name or names listed herein on June 2013. Signed: Salmex Pizza, Inc. (CA-3564570, 103 Exchange Pl, Pomona, Ca 91768; Fernando Tapia, President. The statement was filed with the County Clerk of Los Angeles on March 5, 2025. NOTICE: This fictitious business name statement expires five years from the date it was filed in the office of the County Clerk. A new fictitious business name statement must be filed prior to that date. The filing of this statement does not of itself authorize the use in this state of a fictitious business name in violation of the rights of another under federal, state or common law (See Section 14400 et seq., Business and Professional Code). Pub. Monrovia Weekly 03/20/2025, 03/27/2025, 04/03/2025, 04/10/2025
The following person(s) is (are) doing business as G.S.L, 6620 riverside ave, Bell , CA 90201. This business is conducted by a individual. Registrant commenced to transact business under the fictitious business name or names listed herein on March 2025. Signed: Giovanny Sergio Larios Cruz, 6620 riverside ave, Bell , CA 90201 (Owner). The statement was filed with the County Clerk of Los Angeles on March 12, 2025. NOTICE: This fictitious business name statement expires five years from the date it was filed in the office of the County Clerk. A new fictitious business name statement must be filed prior to that date. The filing of this statement does not of itself authorize the use in this state of a fictitious business name in violation of the rights of another under federal, state or common law (See Section 14400 et seq., Business and Professional Code). Pub. Monrovia Weekly 03/20/2025, 03/27/2025, 04/03/2025, 04/10/2025
FICTITIOUS BUSINESS NAME STATEMENT FILE NO. 2025052420 NEW FILING. The following person(s) is (are) doing business as Proven Pest Control, 948 Lewiston St, Duarte, CA 91010. This business is conducted by a individual. Registrant has not yet begun to transact business under the fictitious business name or names listed herein. Signed: Julio F Ortiz Galindo, 948 Lewiston St, Duarte, CA 91010 (Owner). The statement was filed with the County Clerk of Los Angeles on March 13, 2025. NOTICE: This fictitious business name statement expires five years from the date it was filed in the office of the County Clerk. A new fictitious business name statement must be filed prior to that date. The filing of this statement does not of itself authorize the use in this state of a fictitious business name in violation of the rights of another under federal, state or common law (See Section 14400 et seq., Business and Professional Code). Pub. Monrovia Weekly 03/20/2025, 03/27/2025, 04/03/2025, 04/10/2025
FICTITIOUS BUSINESS NAME STATEMENT FILE NO. 2025050969 NEW FILING.
The following person(s) is (are) doing business as (1). SONORA SANTANERA NUEVA ESPANA (2). ORACLE LOAN PROCESSING (3). L.A. SONORA DINAMITA NUEVA ESPANA , 10208 Strong Avenue, Whittier, CA 90601. This business is conducted by a individual. Registrant commenced to transact business under the fictitious business name or names listed herein on January 2025. Signed: JOSE LUIS MALDONADO, 10208 Strong Avenue, Whittier, CA 90601 (Owner). The statement was filed with the County Clerk of Los Angeles on March 12, 2025. NOTICE: This fictitious business name statement expires five years from the date it was filed in the office of the County Clerk. A new fictitious business name statement must be filed prior to that date. The filing of this statement does not of itself authorize the use in this state of a fictitious business name in violation of the rights of another under federal, state or common law (See Section 14400 et seq., Business and Professional Code). Pub. Monrovia Weekly 03/20/2025, 03/27/2025, 04/03/2025, 04/10/2025 FICTITIOUS BUSINESS NAME STATEMENT FILE NO. 2025040238 NEW FILING. The following person(s) is (are) doing business as Hype Addiction, 260 W 3rd St, Pomona, CA 91766. This business is conducted by a individual. Registrant commenced to transact business under the fictitious business name or names listed herein on March 2023. Signed: Tatsumi Curry Johnson, Po Box 4123, West Covina, Ca 91791 (Owner). The statement was filed with the County Clerk of Los Angeles on February 26, 2025. NOTICE: This fictitious business name statement expires five years from the date it was filed in the office of the County Clerk. A new fictitious business name statement must be filed prior to that date. The filing of this statement does not of itself authorize the use in this state of a fictitious business name in violation of the rights of another under federal, state or common law (See Section 14400 et seq., Business and Professional Code). Pub. Monrovia Weekly 03/20/2025, 03/27/2025, 04/03/2025, 04/10/2025
NOTICE INVITING BIDS
NOTICE OF PLANNING HEARING OFFICER PUBLIC HEARING VARIANCE CASE NO. PVAR-003699-2024
LOCATION: 3296 FULLBROOK COURT GLENDALE, CA 91206
APPLICANT: Leo Chuang
ZONE: RIR-II-(Restricted Residential, Floor Area District II)
LEGAL DESCRIPTION: Lot 18, Block 3, Tract No. 9328/5660-013-005
PROJECT DESCRIPTION
The applicant is requesting approval to construct a new two story 1,716 square-foot single family house with an attached two-car garage on a vacant hillside lot in “ RIRII” - (Restricted Residential, Floor Area Ration II) Zone. The applicant is requesting two variances for the project.
Standards Variance to allow development on a 6,274 square foot substandard lot.
Standards Variance to allow the driveway length of 15 feet.
ENVIRONMENTAL DETERMINATION: The project is exempt from environmental review per State Guidelines Section 15303, Class 3 “New Construction or Conversion of Small Structures” because the project involves the construction of a new single-family house.
HEARING INFORMATION
The Planning Hearing Officer will conduct a public hearing regarding the above project in Room 105 of the Municipal Services Building, 633 E. Broadway, Glendale, CA 91206, on APRIL 2, 2025, AT 9:30 AM or as soon thereafter as possible. The purpose of the hearing is to hear comments from the public with respect to zoning concerns. The hearing will be held in accordance with Glendale Municipal Code, Title 30, Chapter 30.43.
The meeting can be viewed on Charter Cable Channel 6 or streamed online at: https://www.glendaleca.gov/government/departments/management-services/gtv6/livevideo-stream. For public comments and questions during the meeting call 818-937-8100. City staff will be submitting these questions and comments in real time to the appropriate person during the Planning Hearing Officer Hearing. You may also testify in person at the hearing if you wish to do so.
If the final decision is challenged in court, testimony may be limited to issues raised before or at the public hearing.
The staff report and case materials will be available a week before the hearing date at www. glendaleca.gov/agendas.
QUESTIONS OR COMMENTS: If you desire more information on the proposal, please contact the case planner, Shoghig Yepremian in the Planning Division at SYepremian@ glendaleca.gov or (818) 937-8135.
Any person having an interest in the subject project may participate in the hearing, by phone as outlined above, and may be heard in support of his/her opinion. Any person protesting may file a duly signed and acknowledged written protest with the Director of Community Development not later than the hour set for public hearing before the Hearing Officer. "Acknowledged" shall mean a declaration of property ownership (or occupant if not owner) under penalty of perjury. If you challenge the decision of this project in court, you may be limited to raising only those issues you or someone else raised at the public hearing described in this notice, or in written correspondence delivered to the City of Glendale, at or prior to the public hearing. In compliance with the Americans with Disabilities Act (ADA) of 1990, please notify the Community Development Department at least 48 hours (or two business days) for requests regarding sign language translation and Braille transcription services. When a final decision is rendered, a decision letter will be posted online at www.glendaleca.gov/planning/decisions. An appeal may be filed within 15 days of the final decision date appearing on the decision letter. Appeal forms are available at https://www. glendaleca.gov/home/showdocument?id=11926
Dr. S. Abajian , The City Clerk of the City of Glendale
Published on March 20,2025 GLENDALE INDEPENDENT
NOTICE is hereby given that the City of Glendale (“City”) will receive sealed Bids, before the Bid Deadline established below for the following work of improvement: The Babe Herman Little League Field Restroom Project SPECIFICATION NO. 3978
Bid Deadline: Submit before 2:00 p.m. on Thursday, April 30, 2025 (“the Bid Deadline”)
Original plus one (1) copy of Bid to be submitted to: Office of City Clerk 613 E. Broadway, Room 110 Glendale, CA 91206
Bid Opening: 2:00 p.m. on Thursday, May 1, 2025 City Council Chambers 613 E. Broadway, 2nd Floor Glendale, CA 91206
NO LATE BIDS WILL BE ACCEPTED.
Bidding Documents Available: March 17, 2025, on City of Glendale Website
Mandatory Pre-Bid Conference: Date: Wednesday, April 9, 2025 Time: 9:00 am Location: Babe Herman Little League Field 1726 Canada Blvd. Glendale, CA 91208
Note:
• All Contractors planning to attend the job walk on April 9th, shall RSVP prior to 4 pm on April 7th by email to aasaturyan@glendaleca.gov or by calling (818) 937-8247. City of Glendale Contact Person: Arthur Asaturyan, Project Manager Phone: 818-937-8247 E-mail: aasaturyan@glendaleca.gov
Mandatory Qualifications for Bidder and Designated Subcontractors: A Bid may be rejected as non-responsive if the Bid fails to document that Bidder meets the essential requirements for qualification. As part of the Bidder’s Statement of Qualifications, each Bid
1. Bidding Documents: Bids must be made on the Bidder’s Proposal form contained herein. Bidding Documents may be obtained by visiting City of Glendale’s website.
2.Completion: This Work must be completed within Ninety (90) calendar days from the Date of Commencement as established by the City’s written Notice to Proceed.
3. Acceptance or Rejection of Bids. The City reserves the right to reject any and all Bids, to award all or any individual part/item of the Bid, and to waive any informalities, irregularities or technical defects in such Bids and determine the lowest responsible Bidder, whichever may be in the best interests of the City. No late Bids will be accepted, nor will any oral, facsimile or electronic Bids be accepted by the City.
4. Mandatory Pre-Bid Conference and Job Walk. A mandatory pre-bid conference and job walk will be held at the project site at 9:00 a.m. on Wednesday, April 9th at the Babe Herman Little League Field, 1726 Canada Blvd., Glendale, CA 91208.
5. Contractors License. At the time of the Bid Deadline and at all times during performance of the Work, including full completion of all corrective work during the Correction Period, the Contractor must possess a California contractors license or licenses, current and active, of the classification required for the Work, in accordance with the provisions of Chapter 9, Division 3, Section 7000 et seq. of the Business and Professions Code. In compliance with Public Contract Code Section 3300, the City has determined that the Bidder must possess the following license(s): General “B”. The successful Bidder will not receive a Contract award if the successful Bidder is unlicensed, does not have all of the required licenses, or one or more of the licenses are not current and active. If the City discovers after the Contract’s award that the Contractor is unlicensed, does not have all of the required licenses, or one or more of the licenses are not current and active, the City may cancel the award, reject the Bid, declare the Bid Bond as forfeited, keep the Bid Bond’s proceeds, and exercise any one or more of the remedies in the Contract Documents. Subcontractors’ Licenses and Listing. At the time of the Bid Deadline and at all times during performance of the Work, each listed Subcontractor must possess a current and active California contractor license or licenses appropriate for the portion of the Work listed for such Subcontractor and shall hold all specialty certifications required for such Work. When the Bidder submits its Bid to the City, the Bidder must list each Subcontractor whom the Bidder must disclose under Public Contract Code Section 4104 (Subcontractor Listing Law), and the Bidder must provide all of the Subcontractor information that Section 4104 requires (name, the location (address) of the Subcontractor’s place of business, California Contractor license number, California Department of Industrial Relations contractor registration number, and portion of the Work). In addition, the City requires that the Bidder list the dollar value of each Subcontractor’s labor or services. The City’s disqualification of a Subcontractor does not disqualify a Bidder. However, prior to and as a condition to award of the Contract, the successful Bidder shall substitute a properly licensed and qualified Subcontractor— without an adjustment of the Bid Amount
6. Permits, Inspections, Plan Checks, Governmental Approvals, Utility Fees and Similar Authorizations: The City has applied and paid for the following Governmental Approvals and Utility Fees: City of Glendale Building Permits and Inspections
7. All other Governmental Approvals and Utility Fees shall be obtained and paid for by Contractor and will be reimbursed based on Contractor’s actual direct cost without markup. See Instructions to Bidders Paragraph 14, and General Conditions Paragraph 1.01 for definitions and Paragraph 1.03 for Contractor responsibilities.
8. Bid Forms and Bid Security: Each Bid must be made on the Bid Forms obtainable at the Public Works Facilities Management Division. Each Bid shall be accompanied by a cashier’s check or certified check drawn on a solvent bank, payable to “City of Glendale,” for an amount equal to ten percent (10%) of the total maximum amount of the Bid. Alternatively, a satisfactory corporate surety Bid Bond for an amount equal to ten percent (10%) of the total maximum amount of the Bid may accompany the Bid. Said security shall serve as a guarantee that the successful Bidder, within fourteen (14) calendar days after the City’s Notice of Award of the Contract, will enter into a valid contract with the City for said Work in accordance with the Contract Documents.
9. Bid Irrevocability. Bids shall remain open and valid for ninety (90) calendar days after the Bid Deadline.
10. Substitution of Securities. Pursuant to California Public Contract Code Section 22300, substitution of securities for withheld funds is permitted in accordance therewith.
11. Prevailing Wages. This Project is subject to the provisions of California Labor Code Section 1720. Contractor awarded this Contract and all Subcontractors of any tier shall not pay less than the minimum prevailing rate of per diem wages for each craft, classification, or type of worker needed to perform the Work. The Director of Industrial Relations of the State of California, pursuant to the California Labor Code, and the United States Secretary of Labor, pursuant to the Davis-Bacon Act, have determined the general prevailing rates of wages in the locality in which the Work is to be performed. The rates determined by the California Director of Industrial Relations are available online at www.dir. ca.gov/DLSR/PWD/. Davis-Bacon wage rates are included in this Specification and are available online at www.wdol.gov/. To the extent that there are any differences in the federal and state prevailing wage rates for similar classifications of labor, Contractor and its Subcontractors shall pay the highest wage rate. California Department of Industrial Relations ― Public Works Contractor Registration.
Beginning July 1, 2014, under the Public Works Contractor Registration Law (California Senate Bill No. 854 - See Labor Code Section 1725.5), contractors must register and meet requirements using the online application https://efiling. dir.ca.gov/PWCR/ActionServlet?action=displayPWCRegistrationForm before bidding on public works contracts in California. The application also provides agencies that administer public works programs with a searchable database of qualified contractors. Application and renewal are completed online with a non-refundable fee of $300. More information is available at the following links: http://www.dir.ca.gov/DLSE/PublicWorks/SB854FactSheet_6.30.14.pdf http://www.dir.ca.gov/Public-Works/PublicWorks.html
Beginning April 1, 2015, the City must award public works projects only to contractors and subcontractors who comply with the Public Works Contractor Registration Law.
Notice to Bidders and Subcontractors:
• No contractor or subcontractor may be listed on a Bid proposal for a public works project (submitted on or after March 1, 2015) unless registered with the Department of Industrial Relations pursuant to Labor Code section 1725.5 [with limited exceptions from this requirement for bid purposes only under Labor Code section 1771.1(a)].
• No contractor or subcontractor may be awarded a contract for public work on a public works project (awarded on or after April 1, 2015) unless registered with the Department of Industrial Relations pursuant to Labor Code section 1725.5.
• This Project is subject to compliance monitoring and enforcement by the Department of Industrial Relations.
• The prime contractor must post job site notices prescribed by regulation. (See 8 Calif. Code Reg. Section 16451(d) for the notice that previously was required for projects monitored by the DIR Compliance Monitoring Unit.)
Furnishing of Electronic Certified Payroll Records to Labor Commissioner. For all new projects awarded on or after April 1, 2015, contractors and subcontractors must furnish electronic certified payroll records directly to the Labor Commissioner (aka Division of Labor Standards Enforcement).
Dated this _______ day of ________________, 2025, City of Glendale, California.
Dr. Suzie Abajian, PhD., City Clerk of the City of Glendale
Publish March 17,& 20, 2025
GLENDALE INDEPENDENT
NOTICE is hereby given that the City of Glendale (“City”) will receive sealed Bids, before the Bid Deadline established below for the following work of improvement: Preservation and Reuse of the Former Rockhaven Sanitarium Project SPECIFICATION NO. 4004
Bid Deadline: Submit before 2:00 p.m. on Wednesday, April 30, 2025 (“the Bid Deadline”)
Original plus one (1) copy of Bid to be submitted to: Office of City Clerk 613 E. Broadway, Room 110 Glendale, CA 91206
Bid Opening: 2:00 p.m. on Wednesday, April 30, 2025 City Council Chambers 613 E. Broadway, 2nd Floor Glendale, CA 91206
NO LATE BIDS WILL BE ACCEPTED.
Bidding Documents Available: March 17, 2025, on City of Glendale Website
Mandatory Pre-Bid Conference: Date: Tuesday, April 8, 2025 Time: 9:00 am Location: Rockhaven Historic District 2713 Honolulu Ave. Montrose, CA 91020
Note: •All Contractors planning to attend the job walk on April 8th, shall RSVP prior to 4 pm on April 7th by email to aasaturyan@glendaleca.gov or by calling (818) 937-8247.
City of Glendale Contact Person: Arthur Asaturyan, Project Manager Phone: 818-937-8247 E-mail: aasaturyan@glendaleca.gov
Mandatory Qualifications for Bidder and Designated Subcontractors:
A Bid may be rejected as non-responsive if the Bid fails to document that Bidder meets the essential requirements for qualification. As part of the Bidder’s Statement of Qualifications, each Bid must provide satisfactory evidence that:
Bidder: satisfactorily completed at least Three ( 3 ) prevailing wage public contracts in California; each comparable in scope and scale to this Project, within Five ( 5 ) years prior to the Bid Deadline and with a dollar value in excess of the Bid submitted for this Project for the concrete step portion of the project. Documented experience in the renovation and restoration of historic structures, with a focus on compliance with California Historical Building Code (CHBC). The following Quality Assurances must be met: Following Quality Assurances must be met:
1.Contractor is hereby directed to recognize the value and significance of the building and exercise special care during the work to ensure that the existing building, its details, materials and finishes which are to remain are not damaged by the work being performed.
2. Contractor shall be responsible for protection of all existing materials and components to remain in place throughout the duration of construction. Extent of protection is to cover all historic elements to remain that are in the vicinity of construction activities or may be harmed by the movement of materials through the building and project site, whether specifically called out on the drawings, or not. It is the Contractor's responsibility to provide any additional protection required to prevent soiling and damage to existing finishes and elements to remain. All questionable protection requirements should be identified for Architect’s review. In the event of damage, such items shall be repaired or replaced by the contractor at his expense, to the satisfaction of the Architect and City of Glendale.
3. Protection is to be secured adequately so as to maintain a safe environment for workers throughout the duration of the project.
General Scope of Work: Contractor shall furnish labor, materials, equipment, services, and specialized skills to perform work involved in the Project. The Work in the Bid is defined in the Specifications and will generally include the materials needed and steps for the Pines Cottage renovation for a museum, Rockhaven grounds improvements, and off-site parking. The Pines Cottage is a historic structure, and all provisions will be made to preserve, restore, and replicate the original features and finishes.
Other Bidding Information:
4.Bidding Documents: Bids must be made on the Bidder’s Proposal form contained herein. Bidding Documents may be obtained by visiting City of Glendale’s website.
5. Completion: This Work must be completed within Two Hundred and Forty-Five (245) calendar days from the Date of Commencement as established by the City’s written Notice to Proceed.
6. Acceptance or Rejection of Bids. The City reserves the right to reject any and all Bids, to award all or any individual part/item of the Bid, and to waive any informalities, irregularities or technical defects in such Bids and determine the lowest responsible Bidder, whichever may be in the best interests of the City. No late Bids will be accepted, nor will any oral, facsimile or electronic Bids be accepted by the City.
7. Mandatory Pre-Bid Conference and Job Walk. A mandatory pre-bid conference and job walk will be held at the project site at 9:00 a.m. on Tuesday, April 8th at the Rockhaven Historic District, 2713 Honolulu Ave., Montrose, CA 91020.
8. Contractors License. At the time of the Bid Deadline and at all times during performance of the Work, including full completion of all corrective work during the Correction Period, the Contractor must possess a California contractors license or licenses, current and active, of the classification required for the Work, in accordance with the provisions of Chapter 9, Division 3, Section 7000 et seq. of the Business and Professions Code. In compliance with Public Contract Code Section 3300, the City has determined that the Bidder must possess the following license(s): General “B”. The successful Bidder will not receive a Contract award if the successful Bidder is unlicensed, does not have all of the required licenses, or one or more of the licenses are not current and active. If the City discovers after the Contract’s award that the Contractor is unlicensed, does not have all of the required licenses, or one or more of the licenses are not current and active, the City may cancel the award, reject the Bid, declare the Bid Bond as forfeited, keep the Bid Bond’s proceeds, and exercise any one or more of the remedies in the Contract Documents. Subcontractors’ Licenses and Listing. At the time of the Bid Deadline and at all times during performance of the Work, each listed Subcontractor must possess a current and active California contractor license or licenses appropriate for the portion
at the Public Works Facilities Management Division. Each Bid shall be accompanied by a cashier’s check or certified check drawn on a solvent bank, payable to “City of
guarantee that the successful Bidder, within fourteen (14) calendar days after the City’s Notice of Award of the Contract, will enter into a valid contract with the City for said Work in accordance with the Contract Documents.
12. Bid Irrevocability. Bids shall remain open and valid for ninety (90) calendar days after the Bid Deadline.
13. Substitution of Securities. Pursuant to California Public Contract Code Section 22300, substitution of securities for withheld funds is permitted in accordance therewith. 14. Prevailing Wages. This Project is subject to the provisions of California Labor Code Section 1720. Contractor awarded this Contract and all Subcontractors of any tier shall not pay less than the minimum prevailing rate of per diem wages for each craft, classification, or type of worker needed to perform the Work. The Director of Industrial Relations of the State of California, pursuant to the California Labor Code, and the United States Secretary of Labor, pursuant to the Davis-Bacon Act, have determined the general prevailing rates of wages in the locality in which the Work is to be performed. The rates determined by the California Director of Industrial Relations are available online at www.dir.ca.gov/DLSR/PWD/. Davis-Bacon wage rates are included in this Specification and are available online at www.wdol.gov/. To the extent that there are any differences in the federal and state prevailing wage rates for similar classifications of labor, Contractor and its Subcontractors shall pay the highest wage rate. California Department of Industrial Relations ― Public Works Contractor Registration.
Beginning July 1, 2014, under the Public Works Contractor Registration Law (California Senate Bill No. 854 - See Labor Code Section 1725.5), contractors must register and meet requirements using the online application https://efiling.dir.ca.gov/PWCR/ ActionServlet?action=displayPWCRegistrationForm before bidding on public works contracts in California. The application also provides agencies that administer public works programs with a searchable database of qualified contractors. Application and renewal are completed online with a non-refundable fee of $300. More information is available at the following links:
http://www.dir.ca.gov/DLSE/PublicWorks/SB854FactSheet_6.30.14.pdf
http://www.dir.ca.gov/Public-Works/PublicWorks.html
Beginning April 1, 2015, the City must award public works projects only to contractors and subcontractors who comply with the Public Works Contractor Registration Law.
Notice to Bidders and Subcontractors:
• No contractor or subcontractor may be listed on a Bid proposal for a public works project (submitted on or after March 1, 2015) unless registered with the Department of Industrial Relations pursuant to Labor Code section 1725.5 [with limited exceptions from this requirement for bid purposes only under Labor Code section 1771.1(a)].
• No contractor or subcontractor may be awarded a contract for public work on a public works project (awarded on or after April 1, 2015) unless registered with the Department of Industrial Relations pursuant to Labor Code section 1725.5.
• This Project is subject to compliance monitoring and enforcement by the Department of Industrial Relations.
• The prime contractor must post job site notices prescribed by regulation. (See 8 Calif. Code Reg. Section 16451(d) for the notice that previously was required for projects monitored by the DIR Compliance Monitoring Unit.)
Furnishing of Electronic Certified Payroll Records to Labor Commissioner. For all new projects awarded on or after April 1, 2015, contractors and subcontractors must furnish electronic certified payroll records directly to the Labor Commissioner (aka Division of Labor Standards Enforcement).
Dated this 17, 20 day of March, 2025, City of Glendale, California. Dr. Suzie Abajian, PhD., City Clerk of the City of Glendale
Published on March 17, 20, 2025
GLENDALE INDEPENDENT
NOTICE OF PLANNING HEARING OFFICER PUBLIC HEARING PARKING REDUCTION PERMIT CASE NO. PPRP-001372-2023 AND ADMINISTRATIVE USE PERMIT CASE NO. PAUP-001373-2023
LOCATION: 723 SONORA AVENUE (“MAZE” restaurant)
APPLICANT: Aris Artunyan, Exclusive Design Group ZONE: “IND” - (Industrial)
LEGAL DESCRIPTION/APN: Lots 5 and 6, Tract Number 8364, per Map Book 113, Pages 59 and 60, in the City of Glendale, County of Los Angeles. APN 5627-007-019.
PROJECT DESCRIPTION
The applicant is requesting A) a Parking Reduction Permit to allow a change of use from “Warehouse” to “Restaurants, full service” (“MAZE”) for a 12,208 square foot (SF) building in the IND (Industrial) Zone, without providing the 110 additional parking spaces required by Glendale Municipal Code Title 30, Section 30.32.050; and B) an Administrative Use Permit for the on-site sale, service and consumption of alcoholic beverages at the new 12,208 SF full-service restaurant.
ENVIRONMENTAL DETERMINATION
The project is categorically exempt from California Environmental Quality Act (CEQA) review under Section 15301 “Existing Facilities,” because the project only involves a change of use from warehouse to a full-service restaurant within an existing building.
HEARING INFORMATION
The Planning Hearing Officer will conduct a public hearing regarding the above project at 633 E. Broadway (MSB) Room 105, Glendale, CA 91206, on WEDNESDAY APRIL 2, 2025 at 9:30 am or as soon thereafter as possible. The purpose of the hearing is to hear comments from the public with respect to zoning concerns. The hearing will be held in accordance with Glendale Municipal Code, Title 30, Chapter 30.49 and 30.50.
The meeting can be viewed on Charter Cable Channel 6 or streamed online at: www.GlendaleCA.gov/WatchLive. For public comments and questions during the meeting call 818-937-8100. City staff will be submitting these questions and comments in real time to the appropriate person during the Planning Hearing Officer meeting. You may also testify in person at the hearing if you wish to do so. If the final decision is challenged in court, testimony may be limited to issues raised before or at the public hearing. The staff report and case materials will be available prior to the hearing date at www. glendaleca.gov/agendas.
QUESTIONS OR COMMENTS
If you desire more information on the proposal, please contact the case planner Cassandra Pruett in the Planning Division at CPruett@glendaleca.gov or (818) 937- 8186.
PROCEDURES
Any person having an interest in the subject project may participate in the hearing, by phone as outlined above, and may be heard in support of his/her opinion. Any person protesting may file a duly signed and acknowledged written protest with the Director of Community Development not later than the hour set for public hearing before the Hearing Officer. "Acknowledged" shall mean a declaration of property ownership (or occupant if not owner) under penalty of perjury. If you challenge the decision of this project in court, you may be limited to raising only those issues you or someone else raised at the public hearing described in this notice, or in written correspondence delivered to the City of Glendale, at or prior to the public hearing. In compliance with the Americans with Disabilities Act (ADA) of 1990, please notify the Community Development Department at least 48 hours (or two business
days) for requests regarding sign language translation and Braille transcription services. When a final decision is rendered, a decision letter will be posted online at www.glendaleca. gov/planning/decisions. An appeal may be filed within 15 days of the final decision date appearing on the decision letter. All appeals must be filed using the City’s online permit portal: www.glendaleca.gov/Permits -- click “Apply” and “Planning/Zoning.”
Dr. Suzie Abajian, The City Clerk of the City of Glendale
Published on March 20, 2025 GLENDALE INDEPENDENT
NOTICE OF PETITION TO ADMINISTER ESTATE OF JOSEPH WILLIAM KRUEGER aka J KRUEGER, JOSEPH W. KRUEGER, JOSEPH KRUGER
Case No. 25STPB02355
To all heirs, beneficiaries, cred-itors, contingent creditors, and persons who may otherwise be interested in the will or estate, or both, of JOSEPH WILLIAM KRUEGER aka J KRUEGER, JOSEPH W. KRUEGER, JOSEPH KRUGER
A PETITION FOR PROBATE has been filed by County of Los Angeles Public Administrator in the Superior Court of California, County of LOS ANGELES.
THE PETITION FOR PROBATE requests that County of Los Angeles Public Administrator be appointed as personal representative to administer the estate of the decedent.
THE PETITION requests authority to administer the estate under the Independent Administration of Estates Act. (This authority will allow the personal representative to take many actions without obtaining court approval. Before taking certain very important actions, however, the personal representative will be required to give notice to interested persons unless they have waived notice or consented to the proposed action.) The independent administration authority will be granted unless an interested person files an objection to the petition and shows good cause why the court should not grant the authority.
A HEARING on the petition will be held on April 2, 2025 at 8:30 AM in Dept. No. 9 located at 111 N. Hill St., Los Angeles, CA 90012.
IF YOU OBJECT to the granting of the petition, you should appear at the hearing and state your objections or file written objections with the court before the hearing. Your appearance may be in person or by your attorney.
IF YOU ARE A CREDITOR or a contingent creditor of the decedent, you must file your claim with the court and mail a copy to the personal representative appointed by the court within the later of either (1)four months from the date of first issu-ance of letters to a general personal representative, as defined in section 58(b) of the California Probate Code, or (2) 60 days from the date of mailing or personal delivery to you of a notice under section 9052 of the California Probate Code.
Other California statutes and legal authority may affect your rights as a creditor. You may want to consult with an attorney knowledgeable in California law.
YOU MAY EXAMINE the file kept by the court. If you are a person interested in the estate, you may file with the court a Request for Special Notice (form DE-154) of the filing of an inventory and appraisal of estate assets or of any petition or account as provided in Probate Code section 1250. A Request for Special Notice form is available from the court clerk.
Attorney for petitioner:
VALERIE WILES
PRIN DEP COUNTY COUNSEL SBN 143303
DAWYN HARRISON
OFFICE OF COUNTY COUNSEL 500 WEST TEMPLE ST STE 648
LOS ANGELES CA 90012
CN114783 KRUEGER Mar 13,17,20, 2025
BURBANK INDEPENDENT
NOTICE OF PETITION TO ADMINISTER ESTATE OF: REBECCA BALES
CASE NO. 25STPB02508
To all heirs, beneficiaries, creditors, contingent creditors, and persons who may otherwise be interested in the WILL or estate, or both of REBECCA BALES.
A PETITION FOR PROBATE has been filed by RICHARD BROWN in the Superior Court of California, County of LOS ANGELES.
THE PETITION FOR PROBATE requests that RICHARD BROWN be appointed as personal representative to administer the estate of the decedent.
THE PETITION requests the decedent's WILL and codicils, if any, be admitted to probate. The WILL and any codicils are available for examination in the file kept by the court.
THE PETITION requests authority to administer the estate under the Independent Administration of Estates Act. (This authority will allow the personal representative to take many actions without obtaining court approval. Before taking certain very important actions, however, the personal representative will be required to give notice to interested persons unless they have waived notice or consented to the proposed action.)
The independent administration authority will be granted unless an interested person files an objection to the petition and shows good cause why the court should not grant the authority.
A HEARING on the petition will be held in this court as follows: 04/04/25 at 8:30AM in Dept. 62 located at 111 N. HILL ST., LOS ANGELES, CA 90012
IF YOU OBJECT to the granting of the petition, you should appear at the hearing and state your objections or file written objections with the court before the hearing. Your appearance may be in person or by your attorney.
IF YOU ARE A CREDITOR or a contingent creditor of the decedent, you must file your claim with the court and mail a copy to the personal representative appointed by the court within the later of either (1) four months from the date of first issuance of letters to a general personal representative, as defined in section 58(b) of the California Probate Code, or (2) 60 days from the date of mailing or personal delivery to you of a notice under section 9052 of the California Probate Code. Other California statutes and legal authority may affect your rights as a creditor. You may want to consult with an attorney knowledgeable in California law.
YOU MAY EXAMINE the file kept by the court. If you are a person interested in the estate, you may file with the court a Request for Special Notice (form DE-154) of the filing of an inventory and appraisal of estate assets or of any petition or account as provided in Probate Code section 1250. A Request for Special Notice form is available from the court clerk. Attorney for Petitioner
GLORIA SCHARRE PITZER - SBN 84709 BARBARO, CHINEN, PITZER & DUKE LLP 301 E COLORADO BLVD., STE. 700 PASADENA CA 91101-1911
Telephone (626)793-5196 3/13, 3/17, 3/20/25 CNS-3903735# PASADENA PRESS
NOTICE OF PETITION TO ADMINISTER ESTATE OF: MATTHEW TRACY ELLIOTT
CASE NO. 25STPB02042
To all heirs, beneficiaries, creditors, contingent creditors, and persons who may otherwise be interested in the WILL or estate, or both of MATTHEW TRACY ELLIOTT.
A PETITION FOR PROBATE has been filed by ROBERTA SWANN in the Superior Court of California, County of LOS ANGELES.
THE PETITION FOR PROBATE requests that ROBERTA SWANN be appointed as personal representative to administer the estate of the decedent.
THE PETITION requests authority to administer the estate under the Independent Administration of Estates Act. (This authority will allow the personal representative to take many actions without obtaining court
approval. Before taking certain very important actions, however, the personal representative will be required to give notice to interested persons unless they have waived notice or consented to the proposed action.)
The independent administration authority will be granted unless an interested person files an objection to the petition and shows good cause why the court should not grant the authority.
A HEARING on the petition will be held in this court as follows: 03/28/25 at 8:30AM in Dept. 99 located at 111 N. HILL ST., LOS ANGELES, CA 90012
IF YOU OBJECT to the granting of the petition, you should appear at the hearing and state your objections or file written objections with the court before the hearing. Your appearance may be in person or by your attorney.
IF YOU ARE A CREDITOR or a contingent creditor of the decedent, you must file your claim with the court and mail a copy to the personal representative appointed by the court within the later of either (1) four months from the date of first issuance of letters to a general personal representative, as defined in section 58(b) of the California Probate Code, or (2) 60 days from the date of mailing or personal delivery to you of a notice under section 9052 of the California Probate Code.
Other California statutes and legal authority may affect your rights as a creditor. You may want to consult with an attorney knowledgeable in California law.
YOU MAY EXAMINE the file kept by the court. If you are a person interested in the estate, you may file with the court a Request for Special Notice (form DE-154) of the filing of an inventory and appraisal of estate assets or of any petition or account as provided in Probate Code section 1250. A Request for Special Notice form is available from the court clerk. Attorney for Petitioner SHANNON N. WIEZOREK - SBN 233601
WIEZOREK & GEYE, APC 3450 E. SPRING ST STE #212 LONG BEACH CA 90806
Telephone (562) 396-5529 3/13, 3/17, 3/20/25 CNS-3903774# BELMONT BEACON
NOTICE OF PETITION TO ADMINISTER ESTATE OF: DAVID NICHOLAS LYON AKA DAVID NICHOLAS LYON-BUCHANAN AKA DAVID NICHOLAS DELEO CASE NO. 25STPB02573
To all heirs, beneficiaries, creditors, contingent creditors, and persons who may otherwise be interested in the WILL or estate, or both of DAVID NICHOLAS LYON AKA DAVID NICHOLAS LYON-BUCHANAN AKA DAVID NICHOLAS DELEO.
A PETITION FOR PROBATE has been filed by JOSEPH DELEO in the Superior Court of California, County of LOS ANGELES.
THE PETITION FOR PROBATE requests that JOSEPH DELEO be appointed as personal representative to administer the estate of the decedent.
THE PETITION requests authority to administer the estate under the Independent Administration of Estates Act. (This authority will allow the personal representative to take many actions without obtaining court approval. Before taking certain very important actions, however, the personal representative will be required to give notice to interested persons unless they have waived notice or consented to the proposed action.)
The independent administration authority will be granted unless an interested person files an objection to the petition and shows good cause why the court should not grant the authority.
A HEARING on the petition will be held in this court as follows: 04/07/25 at 8:30AM in Dept. 2D located at 111 N. HILL ST., LOS ANGELES, CA 90012
IF YOU OBJECT to the granting of the petition, you should appear at the hearing and state your objections or file written objections with the court before the hearing. Your appearance may be in person or by your attorney.
IF YOU ARE A CREDITOR or a contingent creditor of the decedent, you must file your claim with the court and mail a copy to the personal representative appointed by the court within the later of either (1) four months from the date of first issu-
ance of letters to a general personal representative, as defined in section 58(b) of the California Probate Code, or (2) 60 days from the date of mailing or personal delivery to you of a notice under section 9052 of the California Probate Code. Other California statutes and legal authority may affect your rights as a creditor. You may want to consult with an attorney knowledgeable in California law. YOU MAY EXAMINE the file kept by the court. If you are a person interested in the estate, you may file with the court a Request for Special Notice (form DE-154) of the filing of an inventory and appraisal of estate assets or of any petition or account as provided in Probate Code section 1250. A Request for Special Notice form is available from the court clerk. Attorney for Petitioner
DANIEL B. BURBOTT SBN 279759 GAUDY LAW INC.
267 D STREET UPLAND CA 91786
Telephone (909)982-3199 3/13, 3/17, 3/20/25
NOTICE OF PETITION TO ADMINISTER ESTATE OF: MATTHEW BALANO CASE NO. 24STPB09417
To all heirs, beneficiaries, creditors, contingent creditors, and persons who may otherwise be interested in the WILL or estate, or both of MATTHEW BALANO.
A PETITION FOR PROBATE has been filed by DARIA CARRILLO in the Superior Court of California, County of LOS ANGELES. THE PETITION FOR PROBATE requests that DARIA CARRILLO be appointed as personal representative to administer the estate of the decedent.
THE PETITION requests the decedent's WILL and codicils, if any, be admitted to probate. The WILL and any codicils are available for examination in the file kept by the court. THE PETITION requests authority to administer the estate under the Independent Administration of Estates Act. (This authority will allow the personal representative to take many actions without obtaining court approval. Before taking certain very important actions, however, the personal representative will be required to give notice to interested persons unless they have waived notice or consented to the proposed action.) The independent administration authority will be granted unless an interested person files an objection to the petition and shows good cause why the court should not grant the authority.
A HEARING on the petition will be held in this court as follows: 04/07/25 at 8:30AM in Dept. 62 located at 111 N. HILL ST., LOS ANGELES, CA 90012
IF YOU OBJECT to the granting of the petition, you should appear at the hearing and state your objections or file written objections with the court before the hearing. Your appearance may be in person or by your attorney. IF YOU ARE A CREDITOR or a contingent creditor of the decedent, you must file your claim with the court and mail a copy to the personal representative appointed by the court within the later of either (1) four months from the date of first issuance of letters to a general personal representative, as defined in section 58(b) of the California Probate Code, or (2) 60 days from the date of mailing or personal delivery to you of a notice under section 9052 of the California Probate Code. Other California statutes and legal authority may affect your rights as a creditor. You may want to consult with an attorney knowledgeable in California law.
YOU MAY EXAMINE the file kept by the court. If you are a person interested in the estate, you may file with the court a Request for Special Notice (form DE-154) of the filing of an inventory and appraisal of estate assets or of any petition or account as provided in Probate Code section 1250. A Request for Special Notice form is available from the court clerk. Attorney for Petitioner TIMOTHY J. CHAMBERS - SBN
Telephone (415) 518-8836
3/13, 3/17, 3/20/25
CNS-3904817#
BURBANK INDEPENDENT
NOTICE OF PETITION TO ADMINISTER ESTATE OF:
GALINA SOLODUKHA
CASE NO. 25STPB02161
To all heirs, beneficiaries, creditors, contingent creditors, and persons who may otherwise be interested in the WILL or estate, or both of GALINA SOLODUKHA.
A PETITION FOR PROBATE has been filed by INNA SOLODUKHA in the Superior Court of California, County of LOS ANGELES.
THE PETITION FOR PROBATE requests that INNA SOLODUKHA be appointed as personal representative to administer the estate of the decedent.
THE PETITION requests authority to administer the estate under the Independent Administration of Estates Act. (This authority will allow the personal representative to take many actions without obtaining court approval. Before taking certain very important actions, however, the personal representative will be required to give notice to interested persons unless they have waived notice or consented to the proposed action.)
The independent administration authority will be granted unless an interested person files an objection to the petition and shows good cause why the court should not grant the authority.
A HEARING on the petition will be held in this court as follows: 03/28/25 at 8:30AM in Dept. 44 located at 111 N. HILL ST., LOS ANGELES, CA 90012
IF YOU OBJECT to the granting of the petition, you should appear at the hearing and state your objections or file written objections with the court before the hearing. Your appearance may be in person or by your attorney.
IF YOU ARE A CREDITOR or a contingent creditor of the decedent, you must file your claim with the court and mail a copy to the personal representative appointed by the court within the later of either (1) four months from the date of first issuance of letters to a general personal representative, as defined in section 58(b) of the California Probate Code, or (2) 60 days from the date of mailing or personal delivery to you of a notice under section 9052 of the California Probate Code. Other California statutes and legal authority may affect your rights as a creditor. You may want to consult with an attorney knowledgeable in California law.
YOU MAY EXAMINE the file kept by the court. If you are a person interested in the estate, you may file with the court a Request for Special Notice (form DE-154) of the filing of an inventory and appraisal of estate assets or of any petition or account as provided in Probate Code section 1250. A Request for Special Notice form is available from the court clerk. Attorney for Petitioner
DANIEL J. MATLOUBIAN, ESQ.SBN 318355 TRUST ADVISOR, A PROFESSIONAL LEGAL CORPORATION 15760 VENTURA BLVD., 7TH FLR. ENCINO CA 91436
Telephone (818) 995-9432 3/13, 3/17, 3/20/25 CNS-3905199# BURBANK INDEPENDENT
NOTICE OF PETITION TO ADMINISTER ESTATE OF AMELIA G. SILVA aka AMELIA GONZALES SILVA Case No. PROVA2500181
To all heirs, beneficiaries, cred-itors, contingent creditors, and persons who may otherwise be interested in the will or estate, or both, of AMELIA G. SILVA aka AMELIA GONZALES SILVA A PETITION FOR PROBATE has been filed by Carlos Gonzalez in the Superior Court of California, County of SAN BERNARDINO.
THE PETITION FOR PROBATE requests that Carlos Gonzalez be appointed as personal representative to administer the estate of the decedent.
THE PETITION requests authority to administer the estate under the Independent Administration of Estates Act. (This authority will allow the personal representative to take many actions without obtaining court approval. Before taking certain very important actions, however, the per-
sonal representative will be required to give notice to interested persons unless they have waived notice or consented to the proposed action.) The independent administration authority will be granted unless an interested person files an objection to the petition and shows good cause why the court should not grant the authority.
A HEARING on the petition will be held on April 9, 2025 at 9:00 AM in Dept. No. F2 located at 17780 ARROW BLVD, FONTANA CA 92335.
IF YOU OBJECT to the granting of the petition, you should appear at the hearing and state your objections or file written objections with the court before the hearing. Your appearance may be in person or by your attorney.
IF YOU ARE A CREDITOR or a contingent creditor of the decedent, you must file your claim with the court and mail a copy to the personal representative appointed by the court within the later of either (1)four months from the date of first issu-ance of letters to a general personal representative, as defined in section 58(b) of the California Probate Code, or (2) 60 days from the date of mailing or personal delivery to you of a notice under section 9052 of the California Probate Code. Other California statutes and legal authority may affect your rights as a creditor. You may want to consult with an attorney knowledgeable in California law.
YOU MAY EXAMINE the file kept by the court. If you are a person interested in the estate, you may file with the court a Request for Special Notice (form DE-154) of the filing of an inventory and appraisal of estate assets or of any petition or account as provided in Probate Code section 1250. A Request for Special Notice form is available from the court clerk.
Attorney for petitioner: PAUL HORN ESQ SBN 243227
PAUL HORN LAW GROUP PC 11404 SOUTH STREET CERRITOS CA 90703 CN115146 SILVA Mar 17,20,24, 2025 ONTARIO NEWS PRESS
NOTICE OF PETITION TO ADMINISTER ESTATE OF: JITENDRA KALYANI, AKA JITENDRA V. KALYANI, AKA JITENDRA VENILAL KALYANI CASE NO. 30-2025-01465919-PR-PWCMC
To all heirs, beneficiaries, creditors, contingent creditors, and persons who may otherwise be interested in the will or estate, or both of JITENDRA KALYANI, AKA JITENDRA V. KALYANI, AKA JITENDRA VENILAL KALYANI.
A PETITION FOR PROBATE has been filed by ANJALI J. KALYANI in the Superior Court of California, County of ORANGE. THE PETITION FOR PROBATE requests that ANJALI J. KALYANI be appointed as personal representative to administer the estate of the decedent.
THE PETITION requests the decedent's will and codicils, if any, be admitted to probate. The will and any codicils are available for examination in the file kept by the court.
THE PETITION requests authority to administer the estate under the Independent Administration of Estates Act. (This authority will allow the personal representative to take many actions without obtaining court approval. Before taking certain very important actions, however, the personal representative will be required to give notice to interested persons unless they have waived notice or consented to the proposed action.) The independent administration authority will be granted unless an interested person files an objection to the petition and shows good cause why the court should not grant the authority.
A HEARING on the petition will be held in this court as follows: 04/30/2025 at 1:30 PM in Dept. CM08 located at 3390 Harbor Blvd., Costa Mesa, CA 92626, Costa Mesa Justice Complex NOTICE IN PROBATE CASES
The court is providing the convenience to appear for hearing by video using the court's designated video platform. This is a no cost service to the public. Go to the Court's website at The Superior Court of California -County of Orange (occourts.org) to appear remotely for Probate
hearings and for remote hearing instructions. If you have difficulty connecting or are unable to connect to your remote hearing, call 657-6228278 for assistance. If you prefer to appear inperson, you can appear in the department on the day/time set for your hearing.
IF YOU OBJECT to the granting of the petition, you should appear at the hearing and state your objections or file written objections with the court before the hearing. Your appearance may be in person or by your attorney. IF YOU ARE A CREDITOR or a contingent creditor of the decedent, you must file your claim with the court and mail a copy to the personal representative appointed by the court within the later of either (1) four months from the date of first issuance of letters to a general personal representative, as defined in section 58(b) of the California Probate Code, or (2) 60 days from the date of mailing or personal delivery to you of a notice under section 9052 of the California Probate Code. Other California statutes and legal authority may affect your rights as a creditor. You may want to consult with an attorney knowledgeable in California law.
YOU MAY EXAMINE the file kept by the court. If you are a person interested in the estate, you may file with the court a Request for Special Notice (form DE-154) of the filing of an inventory and appraisal of estate assets or of any petition or account as provided in Probate Code section 1250. A Request for Special Notice form is available from the court clerk.
Attorney for Petitioner:: KEELEY C. LUHNOW, 7777 FAY AVENUE SUITE 203, LA JOLLA, CA 92037, Telephone: 858-4540024 3/20, 3/24, 3/27/25 CNS-3905570# ANAHEIM PRESS
NOTICE OF PETITION TO ADMINISTER ESTATE OF:
MARIANNE SPIELMANN
CASE NO. 25STPB02812
To all heirs, beneficiaries, creditors, contingent creditors, and persons who may otherwise be interested in the WILL or estate, or both of MARIANNE SPIELMANN.
A PETITION FOR PROBATE has been filed by JOHN E. SPIELMANN AND ALISON SPIELMANN in the Superior Court of California, County of LOS ANGELES.
THE PETITION FOR PROBATE requests that JOHN E. SPIELMANN AND ALISON SPIELMANN be ap-pointed as personal representative to administer the estate of the decedent.
THE PETITION requests the decedent's WILL and codicils, if any, be admitted to probate. The WILL and any codicils are available for examination in the file kept by the court.
THE PETITION re-quests authority to administer the estate under the Independent Administration of Estates Act with limited authority. (This authority will allow the personal representative to take many actions without obtain-ing court approval. Before taking certain very important actions, however, the personal representative will be required to give notice to interested persons unless they have waived notice or consented to the proposed action.) The independent administration authority will be granted unless an interested person files an objection to the petition and shows good cause why the court should not grant the authority.
A HEARING on the petition will be held in this court as follows: 04/11/25 at 8:30AM in Dept. 11 located at 111 N. HILL ST., LOS ANGELES, CA 90012
IF YOU OBJECT to the granting of the petition, you should appear at the hearing and state your objections or file written objections with the court before the hearing. Your appearance may be in person or by your attorney.
IF YOU ARE A CREDITOR or a contingent creditor of the decedent, you must file your claim with the court and mail a copy to the personal representative appointed by the court within the later of either (1) four months from the date of first issuance of letters to a general personal representative, as defined in section 58(b) of the California Probate Code, or (2) 60 days from the date of mailing or personal delivery to you of a notice under section 9052 of the California Probate Code. Other California statutes and legal authority may affect your rights as a creditor. You may want to consult with an attorney knowledgeable in
California law. YOU MAY EXAMINE the file kept by the court. If you are a person interested in the estate, you may file with the court a Request for Special Notice (form DE-154) of the filing of an inventory and appraisal of estate assets or of any petition or account as provided in Probate Code section 1250. A Request for Special Notice form is available from the court clerk. Attorney for Petitioner
TONY J. TYRE - SBN 269506
ALLYSON S. HELLER - SBN 315086
WILLIAM C. MASON III - SBN 319441
LAW OFFICES OF TONY J. TYRE, ESQ.
100 S. CITRUS AVE. STE 101 COVINA CA 91723
Telephone (626) 858-9378 3/20, 3/24, 3/27/25 CNS-3906352# PASADENA PRESS
NOTICE OF PETITION TO ADMINISTER ESTATE OF: MARY JANE OROZCO
CASE NO. 25STPB02888
To all heirs, beneficiaries, creditors, contingent creditors, and persons who may otherwise be interested in the WILL or estate, or both of MARY JANE OROZCO.
A PETITION FOR PROBATE has been filed by GILBERT MICHAEL OROZCO in the Superior Court of California, County of LOS ANGELES.
THE PETITION FOR PROBATE requests that GILBERT MICHAEL OROZCO be appointed as personal representative to administer the estate of the decedent.
THE PETITION requests the decedent's WILL and codicils, if any, be admitted to probate. The WILL and any codicils are available for examination in the file kept by the court.
THE PETITION requests authority to administer the estate under the Independent Administration of Estates Act. (This authority will allow the personal representative to take many actions without obtaining court approval. Before taking certain very important actions, however, the personal representative will be required to give notice to interested persons unless they have waived notice or consented to the proposed action.)
The independent administration authority will be granted unless an interested person files an objection to the petition and shows good cause why the court should not grant the authority.
A HEARING on the petition will be held in this court as follows: 04/14/25 at 8:30AM in Dept. 9 located at 111 N. HILL ST., LOS ANGELES, CA 90012
IF YOU OBJECT to the granting of the petition, you should appear at the hearing and state your objections or file written objections with the court before the hearing. Your appearance may be in person or by your attorney.
IF YOU ARE A CREDITOR or a contingent creditor of the decedent, you must file your claim with the court and mail a copy to the personal representative appointed by the court within the later of either (1) four months from the date of first issuance of letters to a general personal representative, as defined in section 58(b) of the California Probate Code, or (2) 60 days from the date of mailing or personal delivery to you of a notice under section 9052 of the California Probate Code. Other California statutes and legal authority may affect your rights as a creditor. You may want to consult with an attorney knowledgeable in California law.
YOU MAY EXAMINE the file kept by the court. If you are a person interested in the estate, you may file with the court a Request for Special Notice (form DE-154) of the filing of an inventory and appraisal of estate assets or of any petition or account as provided in Probate Code section 1250. A Request for Special Notice form is available from the court clerk.
Attorney for Petitioner
JON A. SAN JOSE - SBN 151892
LAW OFFICE OF JON SAN JOSE 5000 E. SPRING STREET, STE. 405 LONG BEACH CA 90815
Telephone (562) 498-8477
3/20, 3/24, 3/27/25
CNS-3906578# GLENDALE INDEPENDENT
NOTICE OF PETITION TO ADMINISTER ESTATE OF Ora Lee White
Case No. PROVA2500221
To all heirs, beneficiaries, creditors, contingent creditors, and persons who may otherwise be interested in the will or estate, or both, of Ora Lee White
A PETITION FOR PROBATE has been filed by Chandra G. White in the Superior Court of California, County of SAN BERNARDINO.
THE PETITION FOR PROBATE requests that Chandra G. White be appointed as personal representative to administer the estate of the decedent.
THE PETITION requests authority to administer the estate under the Independent Administration of Estates Act. (This authority will allow the personal representative to take many actions without obtaining court approval. Before taking certain very important actions, however, the personal representative will be required to give notice to interested persons unless they have waived notice or consented to the proposed action.)
The independent administration authority will be granted unless an interested person files an objection to the petition and shows good cause why the court should not grant the authority.
A HEARING on the petition will be held on April 30, 2025 at 9:00 AM in Dept. F2. located at 17780 Arrow Boulevard, Fontana, Ca 92335.
IF YOU OBJECT to the granting of the petition, you should appear at the hearing and state your objections or file written objections with the court before the hearing. Your appearance may be in person or by your attorney.
IF YOU ARE A CREDITOR or a contingent creditor of the decedent, you must file your claim with the court and mail a copy to the personal representative appointed by the court within the later of either (1) four months from the date of first issuance of letters to a general personal representative, as defined in section 58(b) of the California Probate Code, or (2) 60 days from the date of mailing or personal delivery to you of a notice under section 9052 of the California Probate Code. Other California statutes and legal authority may affect your rights as a creditor. You may want to consult with an attorney knowledgeable in California law.
YOU MAY EXAMINE the file kept by the court. If you are a person interested in the estate, you may file with the court a Request for Special Notice (form DE-154) of the filing of an inventory and appraisal of estate assets or of any petition or account as provided in Probate Code section 1250. A Request for Special Notice form is available from the court clerk.
Attorney for petitioner:
KRISTINE M. BORGIA SB#276777
KRISTINE M. BORGIA LAW CORPORATION 3962 11TH STREET SUITE 202 RIVERSIDE, CA 92501 951.823.5138
MARCH 20, 24, 27, 2025 SAN BERNARDINO PRESS
NOTICE OF PETITION TO ADMINISTER ESTATE OF NAOMI MARIETTA DE LA CRUZ
Case No. 25STPB02893
To all heirs, beneficiaries, cred-itors, contingent creditors, and persons who may otherwise be interested in the will or estate, or both, of NAOMI MARIETTA DE LA CRUZ
A PETITION FOR PROBATE has been filed by Bianca De La Cruz in the Superior Court of California, County of LOS ANGELES.
THE PETITION FOR PROBATE requests that Bianca De La Cruz be appointed as personal representative to administer the estate of the decedent.
THE PETITION requests authority to administer the estate under the Independent Administration of Estates Act. (This authority will allow the personal representative to take many actions without obtaining court approval. Before taking certain very important actions, however, the personal representative will be required to give notice to interested persons unless they have waived notice or consented to the proposed action.)
The independent administra-tion authority will be granted unless an interested person files an objec-tion to the petition and shows good cause why the court should not grant the authority.
A HEARING on the petition will be held on April 15, 2025 at 8:30 AM
in Dept. No. 29 located at 111 N. Hill St., Los Angeles, CA 90012. IF YOU OBJECT to the granting of the petition, you should appear at the hearing and state your objections or file written objections with the court before the hearing. Your ap-pearance may be in person or by your attorney. IF YOU ARE A CREDITOR or a contingent creditor of the decedent, you must file your claim with the court and mail a copy to the personal representative appointed by the court within the later of either (1)four months from the date of first issu-ance of letters to a general personal representative, as defined in section 58(b) of the California Probate Code, or (2) 60 days from the date of mailing or personal delivery to you of a notice under section 9052 of the California Probate Code. Other California statutes and legal authority may affect your rights as a creditor. You may want to consult with an attorney knowl-edgeable in California law.
YOU MAY EXAMINE the file kept by the court. If you are a person interested in the estate, you may file with the court a Request for Special Notice (form DE-154) of the filing of an inventory and appraisal of estate assets or of any petition or account as provided in Probate Code section 1250. A Request for Special Notice form is available from the court clerk. Attorney for petitioner: ANJA REINKE ESQ SBN 146385 LAW OFFICE OF ANJA REINKE
4000 W MAGNOLIA BLVD STE L BURBANK CA 91505 CN115292 DE LA CRUZ
Mar 20, 2024, Mar 24,27, 2025 GLENDALE INDEPENDENT
NOTICE OF PETITION TO ADMINISTER ESTATE OF SHUNJI MUSO
Case No. 25STPB02705
To all heirs, beneficiaries, cred-itors, contingent creditors, and persons who may otherwise be interested in the will or estate, or both, of SHUNJI MUSO
A PETITION FOR PROBATE has been filed by Yuriko Muso in the Superior Court of California, County of LOS ANGELES.
THE PETITION FOR PROBATE requests that Yuriko Muso be ap-pointed as personal representative to administer the estate of the dece-dent.
THE PETITION requests authority to administer the estate under the Independent Administration of Estates Act. (This authority will allow the personal representative to take many actions without obtaining court approval. Before taking certain very important actions, however, the personal representative will be required to give notice to interested persons unless they have waived notice or consented to the proposed action.) The independent administra-tion authority will be granted unless an interested person files an objec-tion to the petition and shows good cause why the court should not grant the authority.
A HEARING on the petition will be held on April 10, 2025 at 8:30 AM in Dept. No. 79 located at 111 N. Hill St., Los Angeles, CA 90012. IF YOU OBJECT to the granting of the petition, you should appear at the hearing and state your objections or file written objections with the court before the hearing. Your ap-pearance may be in person or by your attorney.
IF YOU ARE A CREDITOR or a contingent creditor of the decedent, you must file your claim with the court and mail a copy to the personal representative appointed by the court within the later of either (1)four months from the date of first issu-ance of letters to a general personal representative, as defined in section 58(b) of the California Probate Code, or (2) 60 days from the date of mailing or personal delivery to you of a notice under section 9052 of the California Probate Code. Other California statutes and legal authority may affect your rights as a creditor. You may want to consult with an attorney knowl-edgeable in California law.
YOU MAY EXAMINE the file kept by the court. If you are a person interested in the estate, you may file with the court a Request for Special Notice (form DE-154) of the filing of an inventory and appraisal of estate assets or of any petition or account
The following person(s) is (are) doing business as May’s 3D Prints 681 Laguna Dr Corona, CA 92879 Riverside County Karina Michelle May, 681 Laguna Dr, Corona, CA 92879 Riverside County
This business is conducted by: a individual. Registrant commenced to transact business under the fictitious business name or names listed herein on January 22, 2025. I declare that all the information in this statement is true and correct. (A registrant who declares as true any material matter pursuant to Section 17913 of the Business and Professions Code, that the registrant knows tobe false,is guilty of a misdemeanor punishable by a fine not to exceed one thousands dollars ($1000).)
s. Karina May Statement filed with the County of Riverside on March 6, 2025 NOTICE: In accordance with subdivision (a) of section 17920, a fictitious name statement generally expires at the endofthe five years from the date on which it was filed in the office of the county clerk, except, as provided in subdivision (b) of section 17920, where it expires 40 days after any changes inthe facts set forthinthe statement pursuant to section 17913 other than a change in the residence address of a registered owner. A new Fictitious Business Name Statement must be filed before the expiration. The filingof this statement does not of itself authorize the use this state of a fictitious business name in violation of the rights of another under federal, state, or common law (see Section14411 Et Seq.,business and professions code). I hereby certify that this copy is a correct copy of the original statement on file in my office. Peter Aldana, County, Clerk File# R-202503101 Pub. 03/13/2025, 03/20/2025, 03/27/2025, 04/03/2025 Riverside Independent
FICTITIOUS BUSINESS NAME STATEMENT File No. FBN20250002261
The following persons are doing business as: 4thwayart, 14872 Rockridge Lane, Fontana, CA 92337. Mailing Address, 14872 Rockridge Lane, Fontana, CA 92337. # of Employees 0. DV Designs LLC (CA 202253010238, 14872 Rockridge Lane, Fontana, CA 92337; Virginia Martinez, Manager.County of PrincipalPlace of Business: San Bernardino This business is conducted by: a limited liability company (llc). Registrant commenced to transact business under the fictitious business name or names listed herein on October 19, 2022. By signing below, I declare that I have read and understand the reverse side
in the statement pursuant to Section 17913 other than a change in the residence address of a registered owner. A new Fictitious Business Name Statement must be filed before the expiration. The filing of this statement does not of itself authorize the use in this state of a fictitious business name in violation of the rights of another under federal,state,or common law (see Section 14411 et seq., Business and Professions Code) File#: FBN20250002032 Pub: 03/06/2025, 03/13/2025, 03/20/2025, 03/27/2025 San Bernardino Press
of this form and that all information in this statement is true and correct. A registrant who declares as true any material matter pursuant to Section 17913 of the Business and Professions Code that the registrant knows to be false is guilty of a misdemeanor punishable by a fine not to exceed one thousand dollars ($1,000). I am also aware that all information on this statement becomes Public Record upon filing pursuant to the California Public Records Act (Government Code Sections 6250- 6277). /s/ Virginia Martinez, Manager. This statement was filed with the County Clerk of San Bernardinoon March 5, 2025 NoticeIn accordance with subdivision (a) of Section 17920. A Fictitious Name Statement generally expires at the end of five years from the date on which it was filed in the office of the County Clerk, except, as provided in subdivision (b) of Section 17920, where it expires 40 days after any change in the facts set forth in the statement pursuant to Section 17913 other than a change in the residence address of a registered owner. A new Fictitious Business Name Statement must be filed before the expiration. The filing of this statement does not of itself authorize the use in this state of a fictitious business name in violation of the rights of another under federal,state,or common law (see Section 14411 et seq., Business and Professions Code) File#: FBN20250002261 Pub: 03/13/2025, 03/20/2025, 03/27/2025, 04/03/2025 San Bernardino Press
FICTITIOUS BUSINESS NAME STATEMENT File No. FBN20250002452 The following persons are doing business as: United roofing California SB, 2130 N Arrowhead Ave Suite 205 D, San Bernardino, CA 92405. Mailing Address, 2130 N Arrowhead Ave Suite 205 D, San Bernardino, CA 92405. # of Employees 1. United roofing California Inc (CA, 15300 Ventura Blvd, Sherman Oaks, CA 91403; Lior Hamo, President. County of Principal Place of Business: San Bernardino This business is conducted by: a corporation. Registrant commenced to transact business under the fictitious business name or names listed herein on March 5, 2025. By signing below, I declare that I have read and understand the reverse side of this form and that all information in this statement is true and correct. A registrant who declares as true any material matter pursuant to Section 17913 of the Business and Professions Code that the registrant knows to be false is guilty of a misdemeanor punishable by a fine not to exceed one thousand dollars ($1,000). I am also aware that all information on this statement becomes Public Record upon filing pursuant to the California Public Records Act (Government Code Sections 6250- 6277). /s/ Lior Hamo, President. This statement was filed with the County Clerk of San Bernardino on March 10, 2025 Notice- In accordance with subdivision (a) of Section 17920. A Fictitious Name Statement generally expires at the end of five years from the date onwhichit was filedinthe office of the County Clerk, except, as provided in subdivision (b) of Section 17920, where it expires 40 days after any change in the facts set forth in the statement pursuant to Section 17913 other than a change in the residence address of a registered owner. A new Fictitious Business Name Statement must be filed before the expiration. The filing of this
statement does not of itself authorize the use in this state of a fictitious business name in violation of the rights of another under federal,state,or common law (see Section 14411 et seq., Business and Professions Code) File#: FBN20250002452 Pub: 03/13/2025, 03/20/2025, 03/27/2025, 04/03/2025 San Bernardino Press
The following person(s) is (are) doing business as Storyland Studios 7345 Piute Creek Drive Corona, CA 92881
Riverside County Storyland Studios, LLC (DE, 7345 Piute Creek Drive, Corona, CA 92881
Riverside County
This business is conducted by: a limited liability company (llc). Registrant commenced to transact business under the fictitious business name or names listedhereinonJanuary 10, 2025. I declare that all the information in this statement is true and correct.
(A registrant who declares as true any material matter pursuant to Section 17913 of the Business and Professions Code, that the registrant knows to be false, is guilty of a misdemeanor punishable by a fine not to exceed one thousands dollars ($1000).)
s. Hollyce Weber, Secretary Statement filed with the County of Riverside on March 7, 2025
NOTICE: In accordance with subdivision (a) of section 17920, a fictitious name statement generally expires at the endofthe five years from the date on which it was filed in the office of the county clerk, except, as provided in subdivision (b) of section 17920, where it expires 40 days after any changes inthe facts set forthinthe statement pursuant to section 17913 other than a change in the residence address of a registered owner. A new Fictitious Business Name Statement must be filed before the expiration. The filingof this statement does not of itself authorize the use this state of a fictitious business name in violation of the rights of another under federal, state, or common law (see Section14411 Et Seq.,business and professions code). I hereby certify that this copy is a correct copy of the original statement on file in my office.
Peter Aldana, County, Clerk File# R-202503118 Pub. 03/13/2025, 03/20/2025, 03/27/2025, 04/03/2025 Riverside Independent
FICTITIOUS BUSINESS NAME STATEMENT File No. FBN20250000979
The following persons are doing business as: islas diamond services, 405 S Pacific Ave, Santa Ana, CA 92703. Mailing Address, 405 S Pacific Ave, Santa Ana, CA 92703. juan islas, 405 S Pacific Ave, Santa Ana, CA 92703. County of Principal Place of Business: Orange This business is conducted by: a individual. Registrant commenced to transact business under the fictitious business name or names listedhereinonJanuary 1,2019.By signing below, I declare that I have read and understand the reverse side of this form and that all information in this statement is true and correct. A registrant who declares as true any material matter pursuant to Section 17913 of the Business and Professions Code that the registrant knows to be false is guilty of a misdemeanor
upon
pursuant
the California Public
Act (Government Code Sections 6250- 6277). /s/ juan islas, owner.This statement was filedwith the County Clerk of San Bernardino on February 3, 2025 Notice- In accordance with subdivision (a) of Section 17920. A Fictitious Name Statement generally expires at the end
of a registered owner. A new Fictitious Business Name Statement must be filed before the expiration. The filing of this statement does not of itself authorize the use in this state of a fictitious business name in violation of the rights of another under federal,state,or common law (see Section 14411 et seq., Business and Professions Code) File#: FBN20250000979 Pub: 03/13/2025, 03/20/2025, 03/27/2025, 04/03/2025 San Bernardino Press
FILE NO. FBN20250002196
FILED: March 4, 2025
FICTITIOUS BUSINESS NAME STATEMENT ABANDONMENT: County of Original Filing: San Bernardino
Date of Original Filing: January 27, 2025 File No.: FBN20250000751
Fictitious Business Name(s): THAT 1 PAINTER 17944 Pokeroot Ln San Bernardino, CA 92407
Mailing Address, 17944 Pokeroot Ln, San Bernardino, CA 92407. Name of Registrant: DS & SONS GROUP LLC (CA202463015350 17944 Pokeroot Ln, San Bernardino, CA 92407
This business is/was conducted by: a limited liability company (llc) Registrant has not yet begun to transact business under the fictitious business name or names listed herein BY SIGNING BELOW, I DECLARE THAT I HAVE READ AND UNDERSTAND THE REVERSE SIDE OF THIS FORM AND THAT ALL INFORMATION IN THIS STATEMENT IS TRUE AND CORRECT. (A registrant who declares as true any material matter pursuant to Section 17913 of the Business and Professions Code that the registrant knows to be false is guilty of a misdemeanor punishable by a fine not to exceed one thousand dollars ($1,000).) I am alsoaware that allinformationon this statement becomes public record upon filing pursuant to the California Public Records Act (Government Code Sections 6250-6277). /s/ AAKASH DHIRAJBHAI PARMAR, MANAGER 03/20/2025, 03/27/2025, 04/03/2025, 04/10/2025 San Bernardino Press
FICTITIOUS BUSINESS NAME STATEMENT 20256711501. The following person(s) is (are) doing business as: (1).Hey Guys! (2).Hey Guys (3).Farstar ,2271 WMalvern Ave #224, Fullerton, CA 92833. Full
By City News Service
Oneofthemen involved in gunning down a 78-year-old Winchester resident during a home invasion robbery was convicted Tuesday of firstdegree murder and other charges.
A Murrieta jury returned with unanimous verdicts Tuesday against Clifford John Franken, 54, of Hemet, finding him guilty of the murder count, as well as robbery, burglary and special-circumstance allegations of killing in the course of a robbery and killing in the commission of a burglary.
Riverside County Superior Court Judge Stephen Gallon set a sentencing hearing for May 30 at the Southwest Justice Center.
Franken is being held without bail at the Byrd Detention Center.
His jury went behind closed doors Wednesday afternoon and deliberated all day Thursday and Monday, announcing they had reached unanimous findings just before the lunch hour Tuesday.
Franken and his three co-defendants were granted separate trials for the slaying of Robert Bettencourt in 2023.
During proceedings last month for 47-year-old Kevin Richard Hirsch of Menifee, he reached a plea deal with the District Attorney's Office, admitting murder,

the special circumstance allegation for burglary, and the burglary and robbery counts. The special circumstance allegation for robbery was dropped in exchange for Hirsch's other admissions.
He's being held without bail at the Robert Presley Jail and is slated for sentencing on May 23.
Matthew Patrick Fromer, 52, of Menifee, is also on trial, and the prosecution was still summoning witnesses in his case Tuesday. He's charged identically to Franken, as is Joseph Michael Salvati, 34, of Hemet, whose trial is scheduled to start at the end of the month.
Fromer is being held without bail at the Byrd Detention Center, while Salvati is being held without bail at the Smith Correctional Facility.
According to a trial brief
filed by the prosecution, Hirsch and Fromer were initially the only two alleged conspirators, discussing plans on how to commit a break-in at Bettencourt's residence in the 28100 block of Whitaker Street after learning from someone who had worked around the double-wide trailer that the victim kept a large stash of rare coins and firearms.
Hirsch recorded the 40-minute conversation between he and Fromer on his Apple iPhone, then shared it in text form with Franken and Salvati, prosecutors alleged.
"During that recorded conversation, (they) discuss a plan to burglarize and murder the ‘old man,''' the brief stated. "Hirsch agrees to ‘pop the old man.'"
The men gathered in the predawn hours of March 3,
2023, going to Bettencourt's remote property in separate vehicles. They arrived shortly after 3 a.m., allegedly forcing their way into the residence and confronting the victim as he slept, court papers stated.
After subduing Bettencourt, Hirsch fatally shot the senior, prosecutors said.
The brief said the foursome spent almost two hours ransacking the residence, stealing the victim's collection of rare coins, along with tools, guns and anything else they could load into the bed of a pickup. They separated afterward.
One of the victim's friends became concerned when he couldn't reach him, and went to the property three days later to see what happened. Finding the trailer in complete disarray, he called for deputies, who
discovered the victim's remains "underneath several items of junk," the brief stated.
Central Homicide Unit detectives were able to obtain security surveillance video from a nearby property, which captured all of the vehicles coming and going from the victim's home. The investigators were then able to match the vehicles to other images recorded via license plate recognition cameras strategically placed at various locations in the Hemet Valley, according to court papers.
Sufficient evidence was amassed to obtain a search warrant for Hirsch's room at a Hemet motel, where detectives seized "multiple cell phones" and a Smith & Wesson revolver, later determined to be the one
used in the killing. After connecting all of the alleged conspirators, additional warrants were served, culminating in further seizures of rare coins and tools identified as belonging to the victim, according to the brief. Hirsch's phone and the case- breaking conversation that he'd recorded was also seized, prosecutors said.
After Hirsch was booked into custody, undercover deputies posing as inmates were placed in the same cell with him, leading to a conversation in which the defendant placed himself at the crime, along with his co-defendants, the brief said.
"He described the crime as a ‘huge payday' and the equivalent of a ‘retirement bust,'" according to the narrative. "Hirsch described the payout in the form of ‘guns, coins and money,' all of which are different items found during the search of each defendant ... When asked if he ‘popped the old dude,' Hirsch admitted he shot the victim."
Franken has a prior conviction for vehicle theft, while Fromer has a prior for driving under the influence of drugs, and Hirsch has two priors in another jurisdiction that weren't listed in court documents.
Salvati has priors for carjacking and felony evading.
a historic military training ground where American troops honed their skills in the unforgiving desert before heading into battle during WWII. It's a place of deep significance where veterans and civilians alike find recreation, reflection, and refuge. Taking a sledgehammer to it would throw open the gates to corporate interests and the highest bidder."
Iris Gutierrez, executive director of the High
Desert Hispanic Chamber of Commerce, said she is one of over 300 members of the business community who called for establishing the Chuckwalla monument.
"We should protect this economic engine, not put it on the chopping block. Any attacks on our public lands will be a setback for local businesses and threaten the local quality of life we all enjoy," Gutierrez told CNS.
The new California monuments were estab-
lished under the Antiquities Act of 1906, and it was unclear under what legal authority Trump could rescind their protections from development.
Chuckwalla monument advocates said last year that they sought to protect the homelands of the Iviatim, Nüwü, Pipa Aha Macav, Kwatsáan and Maara'yam peoples, also known as the Cahuilla, Chemehuevi, Quechan, Serrano and Mohave, aka CRIT Mohave,
nations.
"Since time immemorial, we have called the lands in the proposed Chuckwalla National Monument home," said Secretary Altrena Santillanes of the Torres Martinez Desert Cahuilla Indians. "These lands contain thousands of cultural places and objects of vital importance to the history and identity of the Torres Martinez Desert Cahuilla Indians."
Chuckwalla monument advocates said the desig-
nation advances "local priorities in the Eastern Coachella Valley, including honoring Tribal sovereignty, boosting the local economy and ensuring access to nature," such as Mecca's Painted Canyon trail and the Bradshaw Trail in southeastern Riverside County," according to the advocacy organization Protect Chuckwalla. The monument's boundaries were also drawn to avoid areas identified as suitable for renewable
energy development, and the proposal garnered support from the renewable energy industry.
Advocates added that the monument would "protect important heritage values tied to the land, such as multi-use trail systems established by Indigenous peoples and sacred sites," and allow new opportunities for members of local tribes to co-steward their ancestral homelands alongside federal officials.
San Bernardino County health officials last week confirmed four pediatric influenza-related deaths for the 2024-25 flu season.
Two of the children who died following flu infections did not have any known medical conditions, while the other two children had significant health issues, the San Bernardino County Public Health Department reported. All four children had not received the flu vaccine this season.
“We extend our sincerest condolences to the families of these children. These fatalities are a reminder that influenza can be a serious and
often deadly disease among our most vulnerable populations,” said San Bernardino County Health Officer Sharon Wang said in a statement.
The flu season each year is usually from Nov. 1 to April 30, according to health officials. Trips to emergency rooms for flu-like symptoms typically peak between December and February.
For 204-25, hospitalizations have increased by 64.6% compared with last year, officials said, adding that the to stay safe, the members of the public should learn: self-protection methods, how to recognize symptoms and when to seek medical care.
anti-Jewish racism," taking aim at "anti-American colleges and universities."
A few agencies, including the Departments of Justice and Education, have already reacted. Last week, federal law enforcement agents arrested antiwar activistorganizer Mahmoud Khalil from Columbia University, where sit- ins and other proPalestine demonstrations have been held since Israeli Defense Forces invaded Gaza in October 2023. Khalil, who is not a U.S. citizen, is under threat of deportation.
Meantime, the Department of Education announced investigations targeting 60 campuses for "antisemitic eruptions." The schools stand to lose federal educational grants.
"Since Oct. 7, 2023, radical pro-Palestinian and pro-Hamas faculty members and students targeted and harassed Jewish students, staff and faculty on the UCR campus," Eran Vaisben, director of campus-based Inland & Desert Hillel, told CNS. "Legislation and policies that help (in) preventing the harassment and intimidation of Jewish students and faculty are appreciated."
A UCR statement released to CNS indicated that between October 2023
and February 2025, there were 95 incidents "alleged to be hostile or offensive" to those identifying as Jewish.
UCR was among dozens of campuses nationwide where pro-Palestine and antiwar encampments were held last spring. The university noted that "a number of reports" of antisemitism stemmed from "pro-Palestine graffiti, such as ‘Free Palestine' stickers." There were no documented acts of violence.
Of the half-dozen other colleges and universities in the inland region from which hate crime data was obtained, only Cal Baptist University in Riverside reported an antisemitic incident, involving unspecified vandalism in March 2024.
"The encampments were very peaceful, beautiful forms of civil disobedience, which is protected by the First Amendment," Cal State San Bernardino Media Studies Professor Ahlam Muhtaseb, a Palestinian immigrant and member of the Temecula Valley Islamic Center, told CNS. "The encampment at UCLA, for example, was peaceful until malcontents, mainly Zionists, some of them Israelis, started attacking the encampment. It's well documented. These people
By Staff
Officials said even late in the season, receiving the vaccine helps reduce severe symptoms, hospitalizations and flu-related deaths. The U.S. Centers for Disease Control and Prevention recommends that everyone 6 months or older receive an annual flu shot.
Key preventative measures include frequent handwashing, wearing masks in crowded or high-risk settings, avoiding close contact with sick individuals and disinfecting frequently touched surfaces.
Higher-risk individuals for developing severe flu symptoms include pregnant women, children, older adults
and those with chronic conditions such as asthma, diabetes and heart disease.
Symptoms of influenza usually are fever, chills, muscle aches, cough, sore throat, runny nose and fatigue, according to health officials. Children may also experience vomiting and diarrhea. Trouble breathing, persistent chest pain, confusion or bluish lips or face are signs that an individual should seek medical care immediately.
"If you are at higher risk and develop flu symptoms, contact your healthcare provider right away," officials advised. "Early antiviral treatment can help reduce severe

incurred on the encampment, and the students there just tried to push back."
Muhtaseb said the president's executive order is intended to "squash all criticism of Israel so only one narrative — the pro-Israel side — is prominent."
"The policy is to give Israel support to continue its genocidal mission," she said. "You can't keep pushing anti-Constitutional policies and false narratives when it's clear there's a

More information on influenza is on the California Department of Public Health's website. Contact the county’s
plan to continue ethnically cleansing Palestinians from their lands."
Both the professor and Nassar have lost members of their extended families in Gaza and the West Bank since Oct. 7, 2023, when Hamas raided Israel, targeting the Nova Music Festival. An estimated 1,200 Israeli civilians have died in the ensuing hostilities between the IDF and Hamas, which also took more than 200 hostages.
The United Nations Office for Coordination of Humanitarian Affairs indicated that as of March 11, 48,503 Palestinians have been confirmed killed — close to half of them children. Roughly 90% of the population has been displaced, suffering food shortages and lack of electricity. IDF aircraft, drone and artillery strikes have flattened or significantly damaged hospitals, schools, religious centers and homes, according to Amnesty International and other sources.
The Committee to Protect Journalists said that at least 170 journalists, the overwhelming majority of them Palestinians, had been killed in Gaza, West Bank, Lebanon and Israel since October 2023.
Rep. Darrell Issa, R-Temecula, who is of Lebanese descent, told CNS in a statement he backs Trump's order because "college campuses in every corner of the country and everywhere in between are no longer safe harbors for free speech."
He acknowledged "the situation in Gaza is tragic," but stood by his "friend of 20 years, Israeli Prime Minister Benjamin Netanyahu," adding that "with President Trump's leadership, there
Public Health Communicable Disease Section with questions at 800-722-4794 or via email, CDS@dph.sbcounty. gov.
is a path to peace in the region."
Issa's "No Censors on Our Shores Act," which recently won House Judiciary Committee approval, underscores the importance of "First Amendment rights" by seeking to prevent foreign agents from infringing on free speech exercised by American citizens at home. The proposal wouldn't protect foreign nationals joining demonstrations on U.S. soil.
"I'm so Semitic, it hurts," Nassar said. "Trump's order against ‘antisemitism' creates a chilling effect on speech. It's weaponizing the language of anti-racism. It's like with Israel, where they've conflated an entire population with militants, dehumanizing Palestinians."
Attorney and Riverside Chabad Hanukkah Festival organizer Virginia Blumenthal told CNS some campuses "allowed things to get out of hand (last year), and that's where the problems started."
She didn't offer an opinion on the justification for the executive order, but asserted the "legal and constitutional rights of people" shouldn't be infringed because of political differences.